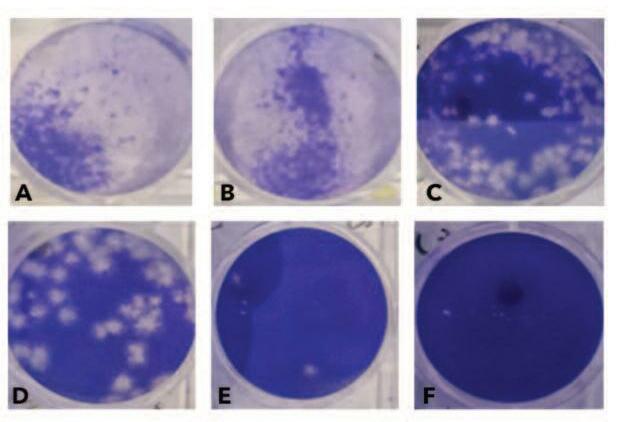
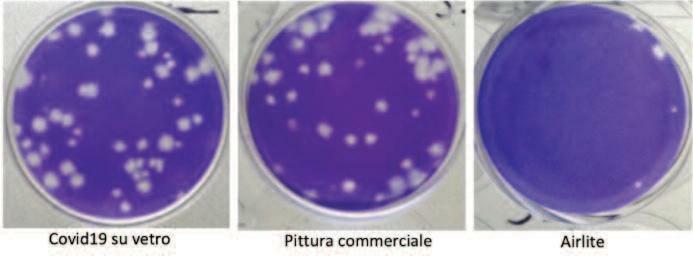

Editoriale

101 RUGGIERO F



Editoriale

101 RUGGIERO F
103 I l G ra n d e O s p e d a l i e r e , S . E . Dominique Principe de La Rochefoucauld Montbel a cura della Redazione
109 L’impatto dell’emergenza SARS CoV 2 nell’assistenza ai pazienti cardiologici: un’indagine preliminare qualitativa S A R S C o V 2 e f f e c t s o n c a r d i a c p a t i e n t s ’ c a r e : a p r e l i m i n a r y qualitative study
La pandemia ha fortemente influenzato l'organizzazione sanitaria ospe daliera dagli organi dirigenziali fino al lavoro in corsia Le difficoltà di gestione dei pazienti tra DPI e mancanza di punti di riferimento hanno però fatto riemergere gli aspetti empatici del lavoro a contatto con i soffe r e n t i L o s t u d i o p u b b l i c a t o , u n o d e i p r i m i s u l l ' a r g o m e n t o , ra c c o n t a l'esperienza degli infermieri dei reparti cardiologici LANNI N , RUGGIERO F , CHIALÀ O
135 I l s u i c i d i o n e l l e Fo r z e A r m a t e : r i c e rc a , p r e ve n z i o n e e contributi teorici S u i c i d e w i t h i n t h e A r m e d Fo rc e s : r e s e a rch , p r e ve n t i o n a n d theory Attraverso l'analisi delle fonti presenti in letteratura gli autori descrivono l ' a n d a m e n t o d e l f e n o m e n o s u i c i d a r i o n e l l e Fo r z e A r m a t e A l l a l u c e anche dei recenti studi in materia effettuati dall'Osservatorio Epidemiolo gico originano degli interessanti spunti di riflessione DI COSTANZO S., RAGGI A.
151 Tra t t a m e n t o d i o s s i g e n o t e ra p i a i p e r b a r i c a i n t ra u m a contusivo distrattivo del muscolo bicipite brachiale. Treatment with hyperbaric oxygen therapy in contusion/sprain of brachial biceps muscle
La sofferenza ischemica ed ipossica tissutale conseguente ad un trauma p u ò e f f i c a c e m e n t e e s s e r e c o n t ra s t a d a l l a t e ra p i a i p e r b a r i c a Vi e n e presentato il caso occorso ad un palombaro LABBATE P , MATTIOLI U , MELONI G
159 R i p a ra z i o n e t o t a l m e n t e e n d ova s c o l a r e d i u n a r o t t u ra dell’istmo aortico: caso clinico in un politrauma Totally endovascular repair of a traumatic aortic isthmic rupture:
a case report of a polytrauma patient

La rottura aortica rappresenta un'emergenza potenzialmente letale che può complicare un politrauma La stabilizzazione della lesione per via endovascolare costituisce un approccio terapeutico fattibile e rapido che consente di dedicarsi in un secondo momento alle altre lesioni ODDI F M , CARNEVALE R , FRESILLI M , IPPOLITI A
167 Trapianto cardiaco e idoneità alla guida e lavorativa MANOLFI M , FAMÀ I
173 L’ a d d e s t ra m e n t o d e i s o c c o r r i t o r i m i l i t a r i d e l c o m p a r t o Forze Speciali della Difesa. a cura di BUONACCORSI F
175 R i c e rc a e S a n i à M i l i t a r e : d i s r u p t ive t e ch n o l o g y a n t i C OV I D 1 9 d a l l a d i a g n o s i p r e c o c e a l l a s i c u r e z z a d e g l i ambienti a cura della Redazione
177 A b s t ra c t d e l l a C o n f e r e n z a “ R i c e rc a e S a n i à M i l i t a r e : d i s r u p t ive t e ch n o l o g y a n t i C OV I D 1 9 d a l l a d i a g n o s i precoce alla sicurezza degli ambienti”
191 Spunti dal “Giornale di Medicina Militare” di Cento anni f a : “ C o n g r e s s o I n t e r n a z i o n a l e d i M e d i c i n a e Fa r m a c i a M i l i t a r e ( B r u x e l l e s , l u g l i o 1 9 2 1 ) L ' o p e ra d e l l a C r o c e Rossa Italiana durante la Guerra (1915 18) come ausi liaria della Sanità militare”
199 P s i c o l o g i a M i l i t a r e : l ’ a t t u a l i t à d e l c o n t r i b u t o d i Pa d r e A g o s t i n o G e m e l l i n e l p r o c e s s o d i s e l e z i o n e psico attitudinale.
IODICE V
La collaborazione al Gior nale di Medicina Militare è libera Le opinioni espresse dagli Au t o r i , c o s ì c o m e e ve n t u a l i e r r o r i d i s t a m p a n o n i m p e g n a n o l a r e s p o n s a b i l i t à del periodico * * *
G l i e l a b o r a t i d ov r a n n o p e r ve n i r e s u s u p p o r t o e l e t t r o n i c o ( c d r o m , o p p u r e c o m e a l l e g a t o e m a i l ) c o n u n a c o p i a a stampa. Il testo può contenere già impagi n a t e e ve n t u a l i t a b e l l e e f i g u r e ch e, comunque, andranno anche alleg ate in un file a par te L’indirizzo per l’invio è: Re d a z i o n e d e l G i o r n a l e d i M e d i c i n a Militare Via Santo Stefano Rotondo n. 4 0 0 1 8 4 Ro m a I t a l i a Te l e f o n o 06/777039077 - 06/777039082. e mail: gmedmil@igesan.difesa.it (e mail: gior nale medmil@libero it) * * *
L o s c o p o d i q u e s t e n o t e è f a c i l i t a r e g l i Au t o r i n e l l a p r e s e n t a z i o n e d e l p r o p r i o l avo r o e d i o t t i m i z z a r e l e p r o c e d u r e d i invio revisione pubblicazione. Gli elaborati scientifici dovranno unifor marsi alle indicazioni contenute nelle nor me redazionali e consultabili all’indirizzo: www difesa it/Gior naleMedicina/rivista/ Pagine/Nor me Redazionali.aspx. * * *
Le presenti indicazioni sono state elaborate nel rispetto delle nor me previste in materia di “Protezione del diritto d’autore e di altri diritti connessi al suo esercizio” (Leg g e del 22 aprile 1941, n 633) * * *
G l i Au t o r i d e g l i e l a b o r a t i , a c c e t t a n d o l e c o n d i z i o n i d e l l e n o r m e, c e d o n o a “ G i o r n a l e d i M e d i c i n a M i l i t a r e ” , a t i t o l o g r a t u i t o, i l d i r i t t o d i u t i l i z z a z i o n e e c o n o mica della/delle opere dell’ing egno, la cui proprietà intellettuale resta in capo all’Au t o r e e c o n l e l i m i t a z i o n i d i s c e n d e n t i d a l l ’ a t t r i b u z i o n e d e l p r e d e t t o d i r i t t o d i pubblicazione.
G l i e l a b o r a t i d e s t i n a t i a l l a p u b b l i c a z i o n e dovranno rispettare i vincoli del Codice in m a t e r i a d i p r o t e z i o n e d e i d a t i p e r s o n a l i (Decreto Legislativo del 30 giugno, n 196) nonché quelli discendenti dalla nor mativa s u l S e g r e t o d i S t a t o e q u e l l i i n e r e n t i a l
d iv i e t o d i p u b b l i c a r e i n f o r m a z i o n i r i s e r va t e / c o n t r o l l a t e / c l a s s i f i c a t e i n a m b i t o Nato UEO e/o nazionale(1).
La collaborazione è aper ta a tutti gli Autori che g odano dei diritti civili e politici nello Stato di appar tenenza o di provenienza La responsabilità dell’effettiva titolarità di t a l i d i r i t t i r i c a d e n e l l a s f e r a p e r s o n a l e d e l l ’ Au t o r e ch e d i ch i a r a d i e s s e r n e i n possesso.
I prodotti editoriali destinati alla pubblica z i o n e d e vo n o e s s e r e i n e d i t i e d e s e n t i d a vincoli editoriali
A tal fine, gli Autori dovranno sottoscrivere apposita dichiarazione sostitutiva di cer tifi cazione e dichiarazione di conf litti d’inte resse (Disclosures) disponibili on line al link www difesa it/Gior naleMedicina/rivista/P agine/Nor me Redazionali aspx * * *
L’accettazione è condizionata al parere del C o m i t a t o S c i e n t i f i c o, ch e n o n è t e nu t o a m o t iva r e l a m a n c a t a p u b b l i c a z i o n e I l Comitato nel processo di revisione dell’ar t i c o l o p o t r à r i ch i e d e r e a g l i a u t o r i m o d i f i ch e, ch i a r i m e n t i e d a g g i u n t e r i t e nu t i necessari per l’accettazione dell’elaborato. I l C o m i t a t o S c i e n t i f i c o, ove l o r i t e n g a necessario, potrà richiedere ai competenti o r g a n i s m i d e l l e F F A A p a r e r e i n m e r i t o a l l ’ o p p o r t u n i t à d i p u b b l i c a r e o m e n o u n a r t i c o l o A l f i n e d i a b b r e v i a r e i t e m p i d i pubblicazione si raccomanda di far per ve n i r e l ’ e l a b o r a t o g i à c o r r e d a t o d e l p a r e r e favorevole dei Superiori g erarchici Condizione preferenziale per la pubblica z i o n e d e i l avo r i è ch e a l m e n o u n o d e g l i Autori sia un appar tenente ai Ser vizi Sani tari di FF AA , G D F , Polizia di Stato, od in a l t e r n a t iva a l l a C R I , a l l o S M O M , a i VV.FF. o alla Protezione Civile.
I l G i o r n a l e a c c e t t a p e r l a p u b b l i c a z i o n e l avo r i s c i e n t i f i c i , c o mu n i c a z i o n i s c i e n t i f i ch e / c a s i c l i n i c i / n o t e b r e v i , e d i t o r i a l i ( s o l o s u i nv i t o ) e d o g n i a l t r o c o n t r i b u t o scientifico o militare rilevante.
Tu t t i g l i Au t o r i s o n o r e s p o n s a b i l i d e l contenuto del testo e che il lavoro non sia stato pubblicato o simultaneamente inviato ad altre riviste per la pubblicazione
U n a vo l t a a c c e t t a t i i l avo r i d ive n g o n o d i
p r o p r i e t à d e l G i o r n a l e e n o n p o s s o n o essere pubblicati in tutto o in par te altrove senza il per messo dell’Editore * * *
È richiesto l’invio di un breve cur riculum vitae ed i punti di contatto di tutti gli Autori e d e l l ’ Au t o r e r e f e r e n t e p e r l ’ e l a b o r a t o (indirizzo, tel , fax, e mail) I lavori, le foto ed i suppor ti infor matici rimar ranno custoditi agli atti della Reda zione, non restituiti anche se non pubblicati L a p r e s e n t a z i o n e d e g l i e l a b o r a t i i m p l i c a l ’ o s s e r va n z a d a p a r t e d e l l ’ Au t o r e, s e n z a riser va alcuna, di tutte le nor me, condizioni e vincoli richiamate nelle presenti nor me, nonché la presentazione contestuale all’ela b o r a t o d e l l e d i ch i a r a z i o n i e l a m a n c a t a o t t e m p e r a n z a c o m p o r t a l ’ a u t o m a t i c a e s c l u s i o n e d a l p r o c e d i m e n t o. Pe r q u a n t o n o n e s p r e s s a m e n t e p r e v i s t o d a l p r e s e n t e Reg olamento, si fa comunque riferimento a l l e n o r m e d e t t a t e d a l l a l e g i s l a z i o n e i n m a t e r i a e s u c c e s s iv i / c o r r e l a t i p r ov ve d i menti legislativi e/o reg olamentari * * *
Ai sensi del Reg olamento UE 2016/679 e d e l d . l g s 2 0 1 8 / 1 0 1 , s i i n f o r m a ch e i d a t i p e r s o n a l i f o r n i t i d a g l i Au t o r i s a r a n n o u t i l i z z a t i e s c l u s iva m e n t e p e r l ’ e s p l e t a m e n t o d e l p r o c e d i m e n t o i n p a r o l a . I n p a r t i c o l a r e, l ’ Au t o r e p o t r à e s p l e t a r e i l diritto all’accesso ai dati personali, richie der ne la cor rezione, l’integ razione, ovvero ogni altro diritto contemplato dal sopraci tato decreto

Ai sensi dell’art 71 del D P R del 28 dicembre 2000, n. 445, l’Amministrazione ha d’altro canto la facoltà di effettuare idonei controlli, anche a campione, nonché in tutti i casi in cui sorgessero dubbi sulla veridicità della dichia razione sostitutiva di certificazione resa ai fini della par tecipazione alla valutazione per la pubblicazione degli elaborati
Ai sensi della Leg g e del 7 ag osto 1990, n 2 4 1 , i l r e s p o n s a b i l e u n i c o d e l p r o c e d i mento in parola è il Capo Ufficio Coordi n a m en to G en era l e d el l ’I sp etto ra to G en e r a l e d e l l a S a n i t à M i l i t a r e V i a d i S a n t o Stefano Rotondo n 4 00187 ROMA tel 06/777039049
DIFESA SERVIZI S.p.A.
Direttore Responsabile
Col Me Francesco Ruggiero
Presidente Comitato Scientifico
Ten Gen Nicola Sebastiani
Comitato Scientifico
Magg. Gen. Massimo Barozzi
Col sa (vet ) t ISSMI Simone Siena
Amm Isp Riccardo Guarducci

Brig Gen CSA rn Giuseppe Ciniglio Appiani
Gen D CC R T (me) Vito Ferrara
Dir Cen PS Fabrizio Ciprani
Col GdF Giuseppe Rinaldi
Magg Gen CRI Gabriele Lupini
C te C M SMOM Brig Gen Mario Fine
Referenti Scientifici
Ten Col Massimiliano Mascitelli
Ten Col sa (vet ) Sergio Carta
Magg. (psi) Giorgio Fanelli
Cap.Sa. RS Antonello Bencivenga
Ten Sa RS Antonio Ruggiero
C F (SAN) Francesco Tavella
C C (SAN) psi Giorgia Trecca
C C (SAN) Marco Gasparri
Brig Gen CSA rn Marco Lucertini
Ten CSArs (psi) Valeria Ceci
1° Mar Lgt Antonio Di Fabrizio
Col CC (me ) Giuseppe De Lorenzo
Cap (psi) Paolo Trabucco Aurelio
Dir Med PS Clementina Moschella
Dir Tecnico Capo (psi) Petri Cucè
Sovrintendente Capo Maurizio Bellini
Col. me. CRI Romano Tripodi
Col. me. CRI Ettore Calzolari
Cap. com. CRI Sergio Mattaccini
Ten com CRI Domenico Nardiello
Magg (psi) GdF Luigi Cinque
Magg me GdF Carlo Buonomo
Cap me GdF Fabio Castrica
Appuntato GdF Emiliano Cutelli
Brig Gen farm ANSMI Vincenzo Barretta
Prof ssa Rosaria Alvaro
Prof Giovanni Arcudi
Prof Francesco Bocchini
Prof. Francesco Carinci
Prof. Rostislav Kostadinov
Prof. Sefano Livi
Prof Rober to Mugavero
Dott Giuseppe Noschese
Prof Francesco Riva
Prof Fabrizio Tagliavini
Prof Giorgio Trenta
Prof Paolo Voci
Redazione e Segreteria
Francesca Amato Mosè Masi Danilo Di Mambro
Direzione e Redazione
Via S Stefano Rotondo, 4 00184 Roma Tel : 06/777039077 06777039082 Fax: 06/77202850 @ e mail: gmedmil@igesan difesa it @ e mail: giornale medmil@libero it
Amministrazione
STATO MAGGIORE DIFESA Uf ficio Amministrazione Via XX Settembre, 11 00187 Roma
Stampa, realizzazione e distribuzione FOTOLITO MOGGIO s.r.l. Strada Galli snc 00010 Villa Adriana Tivoli (RM) www fotolitomoggio it
Autorizzazione del Tribunale di Roma al n 11687 del Registro della stampa il 27 7 67 Codice ISSN 0017 0364 Finito di stampare in agosto 2021
Garanzia di riser vatezza
I dati personali forniti per l’indirizzario vengono utilizzati esclusivamente per l’invio della pubblicazione e non vengono ceduti a terzi per nessun motivo (D Lgs 196/2003 Codice in materia di protezione dei dati personali)
Ringraziamenti Si ringrazia per la collaborazione il personale della Sezione Interpretariato e Traduzioni dello Stato Maggiore della Difesa La Dott ssa Ginevra GERACI per l’ar ticolo a pagina 143; la Dott ssa Anna Maria CIPRIANI per gli ar ticoli a pagina 122 e 155
Il Giornale di Medicina Militare viene inviato a titolo gratuito agli Uf ficiali Medici delle FF AA ed agli Organismi Centrali della P A e dei Ser vizi Sanitari dei Corpi Armati dello Stato ed assimilati.
Italia: Abbonamenti € 36,15; Fasc singolo (annata in corso) € 5,16; Fasc singolo (annate arretrate) € 7,75

Estero: € 86,00 $ 125,20
Librerie: Sconto del 10% sull’impor to annuo: Italia € 32,54; Estero € 77,40 $ 112,80
L'abbonamento annuo al periodico "Giornale di Medicina Militare" può essere ef fettuato mediante: c/c postale intestato a Difesa Ser vizi S p A Nr conto 1048034431
IBAN: IT45Y0760103200001048034431
Ragione Sociale Difesa Ser vizi S p A Indicare in causale: Abbonamento Giornale di Medicina Militare, il codice abbonato (in caso di rinnovo), cognome, nome e indirizzo esatto per la spedizione Inviare copia della ricevuta del versamento alla Redazione del periodico e a Difesa Servizi S p A via e mail a gmedmil@igesan difesa it segreteria@difesaservizi it L’IVA sull’abbonamento di questo quadrimestrale è considerata nel prezzo di vendita ed è assolta dall’Editore ai sensi dell’ar t 74, primo comma lettera C del DPR 26/10/1972 n 633


C a r e l e t t r i c i c a r i l e t t o r i ,

i l C OV I D 1 9 p o t r e b b e e s s e r e u n ’ o c c a s i o n e o a d d i r i t t u r a u n a r i s o r s a ? Q u e s t a l a p r o vo c a t o r i a d o m a n d a ch e m i s o n o p o s t o d u r a n t e l a r e d a z i o n e d e l p r e s e n t e n u m e r o . L a r i s p o s t a , s c o n t a t a p e n s a n d o a i m o r t i e d a i p a t i m e n t i p r o vo c a t i d a l l a p a n d e m i a , è o v v i a m e n t e n o . Pe r ò u n a s f i d a e d u n o s t i m o l o a s s o l u t a m e n t e s i !
I n q u e s t o s e n s o , l e a z i e n d e ch e h a n n o p a r t e c i p a t o a l l a r e c e n t e c o n f e r e n z a o r g a n i z z a t a d a I G E S A N s u “ R i c e r c a e S a n i t à M i l i t a r e ” , d i c u i p u b b l i ch i a m o u n r e s o c o n t o e g l i a b s t r a c t , h a n n o i m p e g n a t o r i s o r s e t e c n o l o g i ch e e s c i e n t i f i ch e p e r s e g u e n d o l ’ o b i e t t ivo d i m i g l i o r a r e i s i s t e m i d i s a n i f i c a z i o n e o d i m o n i t o r a g g i o . L e s c o p e r t e f a t t e , d i s i c u r o b e n e f i c i o p e r l a c o m u n i t à , p o t r a n n o e s s e r e u t i l i z z a t e i n u n p r o s s i m o f u t u r o a n ch e s u a l t r i f r o n t i s e m p r e i n a m b i t o s a n i t a r i o Pe r t a n t o , l a p a n d e m i a h a f u n t o d a o c c a s i o n e q u a l e s t i m o l o p e r i l p r o g r e s s o d e l l a s c i e n z a e l a S a n i t à M i l i t a r e , i n s i e m e a l c o r o l l a r i o d i a z i e n d e ch e g r av i t a n o n e l l ’ a m b i e n t e , h a n n o f o r n i t o a d e g u a t e r i s p o s t e , v a l i d e a n c h e p e r s u c c e s s i v i s v i l u p p i e c a m p i d i a p p l i c a z i o n e

S u u n a l t r o f r o n t e , m e n o t e c n o l o g i c o e p i ù s o c i a l e , è s t a t o p r o va t o l ’ i m p e g n o d e l S o v r a n o M i l i t a r e O r d i n e d i M a l t a , u n o S t a t o , è b e n e r i b a d i r l o , d a s e c o l i a l s e r v i z i o d e g l i u m i l i e d e i s o f f e r e n t i A n ch e i n q u e s t o c a s o è s t a t o n e c e s s a r i o t r o va r e s o l u z i o n i a p r o b l e m i c o m p l e s s i l o g i s t i c i , s a n i t a r i , f i n a n z i a r i N e l l ’ i n t e r v i s t a a l G r a n d e O s p e d a l i e r e a p p r e n d i a m o ch e l a v i a p e r s e g u i t a è c o n s i s t i t a n e l r e c u p e r o d e l l e t r a d i z i o n i e d e l l o s p i r i t o d i s e r v i z i o ch e d a s e m p r e a n i m a l ’ O r d i n e ; l a s t r a t e g i a a d o t t a t a h a c o n s e n t i t o u n a r i s p o s t a a d e g u a t a a l l a s f i d a p a n d e m i c a , s e n z a a b b a n d o n a r e l e m o l t e p l i c i a t t iv i t à c a r i t a t e vo l i g i à i n e s s e r e d a d e c e n n i
U n u l t e r i o r e s p u n t o d i r i f l e s s i o n e g i u n g e d a l l ’ o r i g i n a l s t u dy d i L a n n i ch e c i c a l a n e l l a s f e r a p i ù p r iva t a e “ p r o va t a ” d e i s e n t i m e n t i . G l i o p e r a t o r i s a n i t a r i c o i n vo l t i a va r i o t i t o l o n e l l a l o t t a a l C OV I D h a n n o d o v u t o t r o va r e , n o n s e n z a s t r a s c i ch i e s o f f e r e n z e , l a f o r z a d i o p e r a r e c o n s e r e n i t à e c o n c e n t r a z i o n e n e l m o m e n t o p i ù d i f f i c i l e p e r l a s a n i t à m o n d i a l e L a r i s p o s t a , p e r q u a n t o i n d iv i d u a l e , s i è c o m u n q u e c o n f o r m a t a a d u n p r o c e s s o s o s t a n z i a l m e n t e r a p i d o d i a d a t t a m e n t o a l l a n u o va r e a l t à l avo r a t iva t r a m i t e u n a r i n n o va t a e m p a t i a v e r s o i p a z i e n t i e l e l o r o f r a g i l i t à .
“ L e av v e r s i t à p o s s o n o e s s e r e d e l l e f o r m i d a b i l i o c c a s i o n i ” d i c e va Th o m a s M a n n , u n p e n s i e r o q u a n t o m a i a t t i n e n t e a l l o s p i r i t o d i r e s i l i e n z a g e n e r a t o d a l l a p a n d e m i a n e l n o s t r o Pa e s e .

L’ a m p i o s p a z i o d e d i c a t o a l C OV I D n o n c i h a c o m u n q u e i m p e d i t o d i p r e s e n t a r e a l t r i a r g o m e n t i i n t e r e s s a n t i n e l p r e s e n t e f a s c i c o l o . I n p a r t i c o l a r e s e g n a l o a i l e t t o r i u n a r e v i e w s u l t e m a d e l s u i c i d i o n e l l e Fo r z e A r m a t e ch e r i p r e n d e i l f i l o d i u n d i s c o r s o g i à a l t r e vo l t e p r o t a g o n i s t a s u q u e s t e s t e s s e p a g i n e , o p p u r e l a va l u t a z i o n e m e d i c o l e g a l e d e l t r a p i a n t o c a r d i a c o ch e v e d e i l r i t o r n o a l l a “ p e n n a ” d e i c o l l e g h i d e l l a Po l i z i a d i S t a t o .

N e l l ’ a u g u r a r v i b u o n a E s t a t e e b u o n a s a l u t e , v i l a s c i o a d u n ’ a u s p i c a t a b u o n a l e t t u r a !

Durante la pandemia di COVID 19 l’impegno del Gruppo FS Italiane si è tradotto in varie attività di cui la creazione del “treno sanitario” è sicuramente quella più impegnativa tecnologicamente
La speranza è di utilizzarlo il meno possibile, la certezza è avere uno strumento in più nella lotta alla pandemia, oltre che per emergenze e calamità Quando lo vedremo sui binari sapremo che quel treno bianco sta trasportando pazienti verso un reparto specializzato in un luogo lontano dalla propria città o a volte semplicemente verso un ospedale dove c’è una maggiore disponibilità di posti letto Un viaggio in un vero e proprio ospedale mobile con tecnologie avanzate e un pool di medici, infermieri e operatori sanitari a bordo (fino a 45 persone) che, nell’arco di poche ore, raggiunge la stazione di destinazione con l’obiettivo di salvare vite umane.
Si tratta del nuovo treno sanitario, nato dalla collaborazione del Gruppo FS Italiane, attraverso la sua società di trasporto passeggeri Trenitalia, con il Dipartimento della Protezione Civile e l’Agenzia Regionale Emergenza Urgenza della Lombardia (AREU)

Il convoglio bianco, sui cui fianchi campeggia il Tricolore, è composto da 8 carrozze di cui 3 di terapia intensiva, ciascuna con 7 posti letto per un totale di 21 pazienti trasportabili anche se ventilati in modo invasivo; una carrozza rappresenta la zona di filtro tra l’area asettica dei “reparti” di terapia intensiva e l’area operativa, 2 carrozze tecniche sono quelle necessarie per il funzionamento delle apparecchiature medicali e, in particolare, ospitano i gruppi elettrogeni MOSA che creano un sistema indipendente di alimentazione delle dotazioni sani tarie; una carrozza è adibita a posti letto per il personale, una carrozza fa da magazzino per il trasporto di tutti i materiali e dei dispositivi medici.
Anche gli interni del treno sanitario sono tipici di una corsia d’ospedale piuttosto che di un treno come siamo abituati a pensarlo: i vagoni sono stati modificati nella larghezza per ospitare le barelle e possiedono impianti elettrici potenziati e sistemi di distribuzione dell’ossigeno oltre ad una attrezzatura sanitaria composta da 21 ventilatori polmonari; 1 ecografo; 2 emogasanalizzatore; 21 fra monitor, aspiratori e altre attrezzature; 3 postazioni di monitoraggio
Il treno non risponde solo all’emergenza legata alla pandemia da Covid 19 ma può essere attivato per il trasferimento e la cura dei pazienti anche in caso di calamità, come alluvioni o terremoti Un mezzo di trasporto all’avanguardia, dunque che può avere la funzione di trasporto pazienti verso altre zone d’Italia o all’estero per alleggerire la pressione sulle strutture ospedaliere, oltre a rappresentare un’integrazione al servizio sanitario territoriale per la gestione delle emergenze, in caso di utilizzo come Posto Medico Avanzato
Un altro motivo di orgoglio, oltre al valore di contribuire alla ripartenza del Paese, risiede nelle competenze del Gruppo che, nelle Officine Manutenzione Ciclica di Voghera, solitamente adibite alla manutenzione dei treni, ha prodotto questo gioiello tecnologico che è il treno sanitario Prima di entrare in attività sono state fatte insieme al Dipartimento della Protezione Civile e AREU delle esercitazioni in linea e a pieno carico per testare i due generatori MOSA che alimentano le 21 postazioni Insieme al treno sanitario, il polo vaccinale realizzato in collaborazione con la Croce Rossa Italiana in piazza dei Cinquecento, all’esterno della stazione Termini di Roma, è un altro strumento in cui il Gruppo FS ha dato il proprio contributo per superare le difficoltà del Paese legate alla pandemia da Covid 19.
Il Gruppo FS Italiane, fin dalle prime fasi dell’emergenza sanitaria, si è attivato per dare una mano e contribuire alla ripartenza del Paese: ha riconvertito lo stabilimento ONAE RFI di Bologna che da luglio 2020 a oggi ha prodotto milioni di mascherine protettive, ha riservato viaggi gratuiti a medici e infermieri reclutati dalla Protezione Civile per l’emergenza Covid 19, ha continuato a garantire.
Dal1048 ad oggi attraverso i secoli l’Ordine di Malta si è dedicato con passione e costanza all’assistenza dei poveri e dei malati, estendendo la propria attività dalla Gerusalemme dei primi pellegrini all’intero globo. Ad oggi può contare su 13.500 membri ed 80 000 volontari che consentono all’Ordine di gestire centinaia di programmi umanitari e sanitari
A dirigere quest’imponente organizzazione nel settore umanitario è il Grande Ospedaliere, S E Dominique Principe de La Rochefoucauld Montbel, il cui ruolo riunisce le cariche di Ministro della Sanità, degli Affari Sociali, dell’Azione Umanitaria e della Cooperazione Internazionale Classe 1950, dopo gli studi economici presso le più prestigiose istituzione, del vecchio continente, ha svolto la professione nel settore finanziario ed immobiliare ed ha assunto la prestigiosa carica nell’Ordine dal 2014


L’Ordine di Malta ha quasi raggiunto il millesimo dalla sua fondazione ad opera di Fra’ Gerardo. E’ una storia di servizio a favore degli ultimi dell’umanità. Come è stato possibile che un’organizzazione sia così forte e abbia avuto una vita così lunga e di successo?

Grazie per aver detto “di successo ” . Non è di mille anni, ma di nove cento, anche se 900 è un numero di un certo rispetto. In primo luogo è un modello che definirei unico, basato sull’essere un ordine religioso Naturalmente ci sono altri ordini anche più datati e ancora esistenti, come i Dominicani, i Benedettini, che hanno avuto alti e bassi, come noi E come noi hanno una vocazione unica di essere al servizio dei poveri e gli ammalati Da ciò, la questione si riduce alla domanda: hai un lungo passato, avrai un futuro lungo? E la risposta è molto semplice: finché vi saranno poveri e malati, l’Ordine continuerà la propria missione. L’atti vità di “spedalieri” , che abbiamo da sempre come ordine religioso, ha le sue prerogative sovrane, per questioni storiche: lasciare la Terra Santa per Rodi, prendere e portare la sovranità a Malta Tutto fu mantenuto anche dopo aver perso l’isola per mano di Bonaparte, che sarebbe dive nuto Napoleone da lì a poco Dopo il “transito nel deserto”, come è chia mato, nel sud Italia, l’Ordine fu accolto nello Stato Pontificio nel 1834 ed è tornato, per così dire, “ su piazza” E’ un ’organizzazione in continuo adattamento. Ad esempio, quando l’Ordine era a Rodi era definito una Religione. Furono costruiti ben due ospedali tra i più grandi. Tuttavia, essendo ai confini geografici della cristianità, era piuttosto forte definire i Cavalieri di San Giovanni, Gerusalemme e Rodi “ una Religione”. Quando l’Ordine era a Malta, all’inizio dovette sopportare il difficile compito di difendere l’isola e la cristianità. Anche in quel caso costruirono un ospedale chiamato “La Sacra Infermeria” che operava sulla base del Regolamento de La Sacra Infermeria di Malta, che è molto moderno nei suoi aspetti, alcuni dei quali sono ancora validi oggi Fu istituito, ad esempio, il concetto di quarantena e altri simili Quindi, l’Ordine ha sempre avuto questo spirito di adattamento ed evoluzione nella sua natura e nella sua vocazione Poco dopo
Il Grande Ospedaliere, S E Dominique Principe de La Rochefoucauld Montbel

la creazione della croce rossa da parte di Dunant, che era protestante, si sentì l’urgenza, nel mondo cristiano, in particolare di quello cattolico, di creare un ’assistenza riservata non solo ai civili, ma anche ai militari Anche in questo caso fu un plasmare l’Ordine attra verso la tradizione Questo perché l’Ordine stesso si adatta Ciò portò alla creazione del Corpo Militare e dell’ACISMOM (Associazione italiana Ordine di Malta) nel 1877 Ebbene, da allora, l’Ordine è cresciuto, principalmente attraverso l’opera dell’ACISMOM e del Corpo Militare nel corso delle due guerre mondiali, l’Ospedale di Santa Margherita, i treni ospedale Ho verificato recentemente che anche fino agli anni ’80 ‘90 c ’ erano treni ospedale con le insegne della Croce Rossa di Malta a Malta e in Italia.
Recentemente, anche le Ferrovie Italiane hanno rinnovato questa tradizione creando un treno sanitario per il COVID-19
E’ interessante quello che dice Innanzitutto sottolineerei che il Corpo Militare e l’Ordine hanno una grande tradizione nel pren dersi cura o movimentare i malati a mezzo treno Riguardo al COVID, lo scorso anno, nella Francia orientale, gli ospedali erano stra colmi di pazienti Si è parlato di trasferirne alcuni nelle parte occidentale e sud occidentale del Paese Ci è stato chiesto di fornire sostegno trasferendo le persone con i treni E questo perché ogni anno trasferiamo migliaia di malati a Lourdes per i pellegrinaggi E lo facciamo in treno Questo è un esempio di modernità attraverso la tradizione e dell’essere capaci di fare diverse cose
Tornando alla storia, ritengo incredibile che proprio nei luoghi in cui la Cristianità non era così radicata, e Geru salemme è uno di questi, voi siate fortemente coinvolti. E’ un ricorso della storia.
Essendo un’istituzione religiosa, cattolica, con caratteristiche di sovranità, ci occupiamo degli esseri umani, indipendentemente dalla loro Religione od origine E direi che Gerusalemme e il Medio Oriente sono le nostre radici Non è solo il reparto maternità di Betlemme, ma è il lavoro che facciamo in Libano, la presenza dell’Ordine in Siria, i suoi elementi, ad esempio il Corpo Militare quando gli è richiesto di unirsi a un dispositivo delle Nazioni Unite La Religione non è un problema: ciò di cui ci dobbiamo occupare sono le persone Nel reparto maternità di Betlemme all’interno dell’Unità di terapia intensiva neonatale (NICU) ci sono più di 1000 bambini, più di 4000 nati ogni anno, gestiti secondo standard d’eccellenza. Ma facciamo lo stesso in Africa. C’è una tradizione di servizio, svilup pata anche attraverso una delle nostre nuove componenti, una ONG chiamata Malteser International. Ecco perché siamo coinvolti in così tanti Paesi da 20, 30, 50 anni. Ho celebrato i 50 anni di relazioni con molti paesi, addirittura i 60 in Senegal, 60 anni di presenza! E non una presenza per dire, quanto una presenza sanitaria, sicuramente importante I nostri ospedali locali sono tutti stati ampliati per divenire ospedali d’area, regionali, di riferimento, centri di formazione sanitaria In alcuni paesi abbiamo introdotto qualifiche chirurgiche, dove siamo gli unici che si occupano della formazione dei medici locali Gli staff sono interamente locali Ciò è molto importante per noi: essere parte della società locale Ogni volta che firmiamo un accordo questo è significativo tutti gli accordi sulle cure sanitarie vengono sempre sottoscritti con il Ministero della Salute, il Ministero della Difesa e quello dell’Università Siamo in questi paesi per formare le persone Ecco perché facciamo parte dei loro programmi, con l’esclusività degli accordi governativi e quindi non dipendiamo da alcuna organizzazione multilaterale, né da Stati.
Credo sia la vostra forza, specie se raffrontati ad una ONG. Le ONG sono entità di tipo associativo, non hanno l’autorevolezza di uno Stato

Sono d’accordo E la differenza è che noi siamo ciò che siamo Ciò significa che possiamo agire come ente religioso, istituzione reli giosa della Chiesa Cattolica, che per noi è vincolante dal punto di vista etico, ma possiamo anche essere indipendenti nelle nostre scelte di dove recarci, conducendo le nostre attività senza prendere le parti di nessuno Una ONG è sempre legata a qualcuno, a uno Stato o un ’organizzazione multilaterale Noi abbiamo le nostre ONG Ad esempio, Malteser International è una ONG Direi però che ci basiamo sulle Opere che dipendono dai Gran Priorati o dalle Associazioni Nazionali, come ACISMOM che ne fa parte, in Germania abbiamo Malteser Hilfsdienst, in Francia l’Ordre de Malte de France. Sono l’espressione delle Opere, sono i nostri strumenti, all’interno dei quali abbiamo tra 80 e 85mila volontari e più di 40mila dipendenti. E’ una vera e propria forza che guida le nostre attività nel mondo.
Mil 2021; 171(2): 97 108
Analizziamo la vostra caratteristica duale. Mi riferisco al vostro essere sia militari sia religiosi. E’ molto simile alla situazione dei medici militari nel contesto delle Forze Armate: medico e soldato Siamo quindi molto simili Due diverse visioni in una sola persona. Cos’è più importante nel vostro lavoro quotidiano: la fede o lo spirito di servizio. Come dicevo, siamo prima di tutto un ordine religioso della Chiesa Cattolica. In questo senso, dipendiamo dal diritto canonico. Allo stesso tempo, siamo un Ordine Ospedaliero e questa è la nostra vocazione. Non credo ci sia dualità, né sdoppiamento. C’è una vocazione, la quale è la “Tuitio Fidei et Obsequium Pauperum” , difendere la Fede e servire i poveri , e la testimonianza della nostra fede come cattolici. La definizione “militare” è entrata a far parte dell’Ordine solo recentemente Naturalmente avevamo il dovere di difendere la Terra Santa ed era più una vocazione religiosa che militare e non sono convinto che i religiosi all’inizio fossero combattenti, anche se S Bernardo di Chiaravalle inventò la spada a doppio filo Ciò è esistito e certamente l’Ordine era fortemente militare attraverso la Marina, a Rodi, a Malta: la battaglia di Lepanto in cui abbiamo combattuto è un esempio C’è stata questa realtà, ma l’essenza vera dell’Ordine è quella di quando eravamo a Rodi, dove eravamo chiamati “La Religione” A Malta eravamo chiamati “L’Ospedale” Si vede come i due aspetti sono da sempre intimamente legati E’ attraverso le situazioni locali che siamo diventati militari La prima volta che l’espressione “militare” si è attestata nell’Ordine è stata in occasione della Riforma del Codice Emmanuel de Rohan nel 1782, laddove l’Ordine viene chiamato Sacro Militare Ordine di Malta Il riferimento è sempre a Gerusalemme, Rodi o Malta, ma non c ’ era mai stato l’aggettivo “militare” Successivamente, nella riforma del 1961, il nome ufficiale è divenuto “Sovrano Militare Ordine Ospedaliero di San Giovanni, di Gerusalemme, Rodi e Malta.” Tutta la nostra storia in un nome. Direi non che c’è un modo laico di affrontare le cose da un lato e religioso dall’altro. No, i mezzi con cui operiamo si fondano sull’etica di cura medica della Chiesa Cattolica. Sono dimensioni che esistono insieme, non ce n’è una separata dall’altra, una che prevale, una che segue Sono insieme Il nome dell’ordine di oggi riassume l’unicità dell’Ordine Non si può copiare
Come ha affrontato l'Ordine di Malta l'emergenza pandemica?
A poche settimane dallo scoppio della crisi sanitaria causata dal Covid 19, l'Ordine di Malta è stato in grado di assicurare la prose cuzione di molte delle sue attività, e per farlo ha raddoppiato i suoi sforzi Siamo stati costretti a ripensare le strutture dei nostri progetti di assistenza, per adattarle al nuovo scenario e a rispondere alle nuove e maggiori richieste di aiuto Quando le mense per i poveri sono state chiuse per motivi di salute, abbiamo consegnato pacchi di cibo in sostituzione; quando gli ospedali hanno raggiunto la loro piena capacità, ne abbiamo costruiti di nuovi; quando i nostri malati sono rimasti a casa isolati abbiamo fornito dispositivi tecnologici per mantenere i nostri ospiti virtualmente in contatto tra loro. Sono state sviluppate anche nuove attività: Centri di sostegno psicologico, evacuazioni mediche, posti di pre screening e centri di vaccinazione. E così, sono orgoglioso di dire che mentre tutti venivano lasciati soli, i paesi chiudevano le loro frontiere e sospendevano il sostegno internazionale, sono stati realizzati altri progetti transnazionali
L'Ordine di Malta ha intrapreso qualche attività diplomatica considerando che la pandemia rappresenta una minaccia comune e transnazionale?
L'iniziativa dell'Ordine di Malta "Doctors to Doctors" , lanciata nel marzo 2020, è stata creata come una piattaforma di scambi oriz zontali attraverso quattro continenti: competenze, esperienze e lezioni apprese sono state condivise e molti specialisti della sanità hanno potuto essere meglio informati All'inizio si sapeva ben poco del Covid 19 che ha fatto più vittime di una grande guerra La mancanza di attrezzature di protezione, poi la produzione e la ricerca di tamponi per lo screening e la rilevazione, per finire con la corsa impari ai vaccini e alle cure. Questi temi sono stati al centro delle numerose riunioni svolte grazie alla piattaforma “Doctor to Doctor”.
La lotta alle malattie pandemiche, soprattutto quelle trascurate, continua ad essere al centro della missione dell'Ordine di Malta?
Fin dalle sue origini l'Ordine di Malta ha combattuto le malattie infettive dalla peste al morbo di Hansen, dalla tubercolosi alla malaria, seguendo la sua tradizione, ma sempre moderno nel proprio operare Per l'Ordine di Malta, in questa terribile situa zione, sostenere i bisognosi non era un 'opzione, ma un dovere Il naturale perseguimento della sua vocazione originaria: raffor zare la Fede e alleviare la Sofferenza La mia gratitudine va a tutti i membri, volontari e personale che hanno continuato, con instancabile dedizione le attività dell'Ordine mettendo spesso a rischio la loro salute e proseguendo nell’assistenza alle persone affette da patologie “antiche” e spesso neglette
G Med Mil 2021; 171(2): 97 108
1 0 5 1 0 5

Un recente studio del CENSIS ha confermato l’assoluto valore percepito dei Distributori Intermedi del Farmaco a tutela e a garanzia della salute dei cittadini italiani garantendone l’essenzialità e l’universalità del servizio anche e soprattutto nei piccoli centri rurali Durante gli ultimi 16 mesi di pandemia questo è stato ancora più reso visibile grazie alle attività di screening (prima) e di vaccinazione (ora) compiute dalle 19 mila Farmacie sul territorio In questo scenario FederFARMA CO (centrale di proprietà delle Società di Farmacisti in forma aggregata) ha svolto un essenziale ruolo sia nella prima che nella seconda ondata Maurizio Stroppa, ex Ufficiale di complemento della Brigata Paracadutisti Folgore, avvocato e Direttore Generale di FederFARMA.CO ripercorre gli ultimi mesi alla guida dell’Azienda partendo proprio dal suo ingresso in piena emergenza pandemica.
Direttore, partiamo dal ruolo di FederFARMA CO nell’ambito della distribuzione del farmaco e dal suo modello di business Che cos’è oggi FederFARMA CO?
FederFARMA.CO è uno degli attori principali del panorama della distribuzione intermedia del farmaco in Italia, caratterizzandosi come una centrale d’acquisto a cui afferiscono le principali società di farmacisti (in forma di capitale o di azionariato diffuso) Il ruolo di FederFARMA CO è quello di poter metter a fattor comune i benefici che la centrale stessa trae interfacciandosi con le principali industrie di marca del farmaco e con i più importanti fornitori di servizi nel rappresentare un unico interlocutore: forte, credibile e guidato dall’interesse comune È un ruolo, non le nascondo, che si è modificato nell’ultimo periodo soprattutto durante l’anno pandemico
Che ruolo ha avuto FederFARMA CO, nei mesi della pandemia, che coincidevano con il suo ingresso in Azienda?
I miei primi mesi in FederFARMA.CO, ad inizio 2020, sono quelli che tutti abbiamo ancora ben presenti nella nostra mente. Un virus letale, imprevisto, e completamente sconosciuto irrompeva nella nostra ordinarietà con una forza dirompente, obbligando le istituzioni a misure drastiche. Erano i tempi, ricorderà, dove per i movimenti consentiti diventava obbligatorio l’utilizzo della mascherina, ma era pressoché impossibile recuperarle sul mercato Abbiamo ritenuto essenziale allora lavorare come di consueto in piena sinergia con le nostre consociate, ma uscendo dagli schemi ordinari Sedendoci dunque in un tavolo comune con la nostra rappresen tanza politico istituzionale, Federfarma Servizi e con la stessa Struttura del Commissario Straordinario per l’emergenza Questo ci ha permesso fra l’altro di rafforzare, con il nostro ruolo di “motore operativo centrale”, il servizio dell’intera catena di rifornimento: la fornitura e distribuzione in urgenza di quanto necessario attraverso ponti istituzionali ed internazionali, con il pieno coinvolgimento delle strutture consociate, di FederFARMA CO ed infine delle farmacie Con l’obiettivo di coprire al meglio le urgenze della collettività, rendendo direttamente disponibili nei punti territoriali decine di milioni di mascherine, in una situazione diventata critica a causa di una domanda imprevista nei quantitativi e nelle tempistiche Un successo reso possibile da team straordinari che sono stati capaci davvero di lavorare insieme nell’interesse comune e, mi lasci aggiungere, spinti da motivazioni ulteriori rispetto alle logiche commer ciali connaturate alle tipicità delle aziende coinvolte La distribuzione intermedia del farmaco, le società dei farmacisti, le farmacie e la stessa FederFARMA.CO hanno svolto senza clamori un ruolo essenziale nel combattere l’avanzata del virus. Personalmente è stato un “battesimo del fuoco” di grande motivazione nella guida di una realtà così centrale nel contesto di emergenza sanitaria globale di inizio 2020.

Un ruolo fondamentale, avvocato, che è andato a crescere via via nei mesi e che ha sempre di più visto le Farmacie come baluardi della sanità territoriale e veri avamposti di prossimità nella lotta al COVID. L’altra iniziativa che vi ha visto protagonisti nella maggior parte delle farmacie è stato il lancio dell’auto test sierologico Covid
Esattamente Pensi ai mesi dove ancora nelle farmacie non era possibile eseguire le PCR per le rilevazioni del SARS CoV2 e la sanità pubblica e le strutture convenzionate erano prese d’assalto Il singolo cittadino non era in grado di verificare autonomamente se avesse contratto l’infezione e se ne avesse sviluppato gli anticorpi È in questo scenario che siamo stati i primi ad introdurre sul mercato, grazie a PROFAR®, il nostro marchio, il Self Test COVID 19 in autodiagnosi in grado di rilevare la presenza di anticorpi di tipo G e di tipo M, con un forte vantaggio per la collettività
La portata era tale che ci tenemmo, forti della coscienza istituzionale, a condividerlo con il Ministero della Salute in un colloquio con la Direzione Generale della Prevenzione Sanitaria nella persona del Prof Giovanni Rezza a capo della stessa struttura Ora è il tempo della sua seconda versione che ci vede in Farmacia da pochi giorni con la sua evoluzione: il nuovo test in grado di rilevare quanti tativamente la presenza di anticorpi da vaccino Un ulteriore elemento, questo, a sostegno ed in supporto della campagna vaccinale che il Gen Figliuolo sta guidando negli ultimi mesi
Questi sono solo due esempi di come abbiamo saputo, assieme, innovare e trarre ispirazione in un periodo particolarmente complesso, ma dal quale abbiamo imparato a gettare le basi in termini di differenziazione di prodotto per il prossimo periodo Un risultato, Direttore, conseguito al fianco dei farmacisti e che immagino abbia visto le vostre consociate fare squadra comune?

L’introduzione del primo test autodiagnostico è stato sicuramente un utile strumento di autodiagnosi che ha continuato a vedere nel farmacista, come diceva nell’intervista sul precedente numero del Giornale il Presidente degli Ordini dei Farmacisti Italiani, l’on. Andrea Mandelli l’amico colto del cittadino. Nei punti di salute territoriale hanno saputo guidare l’utente nell’utilizzo del test e soprattutto nella lettura dei risultati con la consueta professionalità che da sempre li guida

Tornando al ruolo di FederFARMA.CO, qual è il livello di cooperazione fra gli attori e quali sono i piani rispetto al futuro?
La principale attività di FederFARMA CO rimane la stessa, ma con ingredienti nuovi: quella di mettere a vantaggio delle consociate e delle farmacie il valore aggiunto generato dal canale lavorando in sinergia, attraverso un rinnovato spirito di trasparenza e condi visione Abbiamo un Comitato Direttivo forte, formato dai vertici istituzionali ed organizzativi delle principali aziende consociate al cui tavolo sono portate le scelte strategiche ed operative legate alle attività commerciali, di servizio alle farmacie e di sviluppo dei prodotti PROFAR® L’evoluzione di FederFARMA CO è oggi guidata da un piano strategico pluriennale condiviso a cui si affiancano regolari valutazioni tattiche rispetto ad un mercato in continuo cambiamento, anche al di là del contesto pandemico
Ci fa alcuni esempi?
Stiamo discutendo con grande attenzione di temi attuali, degli sviluppi del canale e commerce, di home delivery, di sistemi ibridi di distribuzione off e on line. Il tavolo è uno, le idee ed i punti di vista sono molti e dal confronto costante individuiamo le strade da seguire. È il primo anno che il nostro marchio PROFAR® ha avuto una un piano marketing ed una roadmap definita e condivisa ad inizio anno fra tutti gli attori Infine, il lancio dell’app Mia Farmacia (la catena virtuale che fa riferimento a Farmacentro) è stato frutto di un “ una triplice intesa” e di numerosi elementi di condivisione comune fra il team di FederFARMA CO, gli sviluppatori e la commissione digital della stessa catena virtuale Il risultato è un ’ app moderna, al servizio del cittadino e della collettività creata e pensata dal valore dell’eterogeneità di persone con esperienze e punti di vista e di utilizzo differenti Cosa prevede dott Stroppa per il futuro di FederFARMA CO?
In questo particolare momento storico il ruolo di una Centrale il cui obiettivo resta quello di dare efficacia, efficienza e valore ai suoi partecipanti è un elemento strategico essenziale del canale, i cui benefici sono strettamente legati alla reale e non scontata capacità di fare fronte comune e di riuscire a realizzare quanto definito nel piano strategico, sempre con un occhio ad un mercato costantemente più veloce nei cambiamenti La capacità di fare ulteriormente sistema e di inno vare saranno dunque sicuramente alla base dello sviluppo delle attività di Feder FARMA.CO, su tutti i fronti: dallo sviluppo di PROFAR® all’omnicanalità, dalla digitalizzazione all’efficienza operativa, dalla cyber security a tutela dei processi operativi alla creazione di partnership commerciali di valore, osservando i prin cipali mutamenti sia del nostro che dei principali mercati. Non è una sfida semplice, dato il contesto Ma abbiamo dimostrato ottime basi per poter raggiungere risultati di primissimo piano Ricordando che tutto questo è reso possibile dal valore delle persone: mi permetta un ultimo, ma importante momento per aggiungere un plauso e un ringraziamento per l’ec cezionale competenza ed impegno che quotidianamente vedo Come per l’esperienza con “le stellette” anche in questo caso non posso che confermare quanto il lavoro in team sia alla base di ogni importante risultato raggiunto

Riassunto Introduzione: La pandemia da SARS CoV 2 ha reso necessaria una riorganizzazione della rete ospedaliera e territoriale, coinvol gendo inevitabilmente anche l’ambito cardiologico con una forte rimodulazione dei protocolli e dei percorsi diagnostici e terapeutici Scopo: È stato condotto uno studio qualitativo con lo scopo di valutare l’impatto dell’emergenza SARS CoV2 nell’assistenza ai pazienti cardio logici. Materiali e metodi: Lo studio è stato condotto nel periodo maggio settembre 2020 attraverso una serie di interviste semi strutturate. Il campione di riferimento per le interviste è composto da 14 infermieri e 2 tecnici di fisiopatologia cardiocircolatoria e perfusione cardio vascolare (TFCPC) Ri s u l t a t i : I contenuti espressi dagli intervistasti sono stati codificati in 140 c o d e s raggruppati in 8 differenti f a m i l y Le tematiche principali emerse dalle interviste hanno riguardato la riorganizzazione del sistema sanitario ospedaliero, gli outcome e le perce zioni dei pazienti cardiologici, il ruolo dei professionisti sanitari durante l’emergenza e i loro stati d’animo, con uno sguardo rivolto alle proposte future di assistenza. Conclusioni: Al termine dello studio è possibile asserire che la professionalità espressa dal personale sanitario ha portato, attraverso un concreto spirito di adattamento a risultati positivi, malgrado le incertezze emerse soprattutto durante la prima ondata pandemica
Parole chiave: SARS CoV 2, COVID 19, professionisti sanitari, pazienti cardiologici, studio qualitativo
Messaggi chiave:

• Il contesto pandemico ha determinato il cambiamento radicale dell’organizzazione strutturale e funzionale della sanità ospedaliera e territoriale • Il personale sanitario ha risposto ai cambiamenti dettati dalla pandemia da SARS CoV 2 con atteggiamento adattivo, malgrado le difficoltà vissute soprattutto nella prima ondata pandemica
La pandemia SARS CoV 2 ha rappre sentato e rappresenta tutt’oggi una grande sfida imprevista per il Paese e per l’intero Sistema Sanitario Nazionale.
Sebbene l’intera comunità scientifica abbia lavorato senza sosta per trovare approcci terapeutici a breve termine e una soluzione vaccinale a lungo termine
per ridurre la diffusione e frenare la morbilità e la mortalità del COVID 19, vanno ancora risolte le urgenti questioni relative alla produzione e alla distribu zione di massa dei vaccini e delle altre strategie terapeutiche (1).
Il coinvolgimento cardiovascolare è al primo posto tra gli effetti del COVID 19 (2). Diversi trials clinici hanno dimo strato come la malattia COVID 19 abbia,
nei pazienti con comorbidità cardiova scolari, un’incidenza maggiore ed un più elevato tasso di mortalità (3)
Per far fronte all’emergenza, è stata necessaria una riorganizzazione sia della rete ospedaliera che territoriale, coinvolgendo inevitabilmente anche l’ambito cardiologico, con una forte rimodulazione dei protocolli e dei percorsi diagnostici e terapeutici (4). Se
* Mar Sa (inf) Scuola di Sanità e Veterinaria Militare, Roma
** Col Sa (me) Vice Capo UOC Emodinamica e Cardiochirurgia Policlinico Militare Roma
° Ten Sa Capo Sezione Istituto Scienze Infermieristiche Scuola di Sanità e Veterinaria Militare Roma
Corrispondenza: Mar Sa (inf) Nicolas LANNI Email: nicolaslanni@hotmail it

da un lato i pazienti spaventati dalle informazioni mediatiche sull’anda mento dei casi della pandemia sono stati reticenti nel recarsi presso le strutture sanitarie, dall’altro, gli ospedali, gli ambulatori e i presidi di primo soccorso hanno dovuto riadattare le misure di ospedalizzazione e di gestione del paziente, sia in emergenza (conside rando tutti gli utenti potenzialmente positivi e indirizzando i casi indifferibili alle strutture HUB), sia in elezione, rior ganizzando i reparti di degenza in “COVID” e “No COVID” con personale dedicato e protocolli definiti (4).
L’emergenza non ha riguardato il solo sistema organizzativo, ma anche quello professionale degli operatori sanitari coinvolti Questi ultimi hanno dovuto far fronte alle incertezze, ai cambiamenti della routine lavorativa e alle modifiche dei protocolli aziendali Il personale sani tario ha dovuto far leva sulle proprie competenze clinico assistenziali per supportare al meglio pazienti soli e spaventati (5)
Alla luce dei dati forniti dalla lettera tura sulla correlazione fra COVID 19 e comorbidità cardiovascolari, appare chiara l’importanza della valutazione dei cambiamenti dell’assistenza ai pazienti cardiologici (6)
Considerando l’assenza di strumenti standardizzati per valutare l’impatto dell’emergenza SARS CoV2 nell’assi stenza ai pazienti cardiologici, è stato condotto uno studio qualitativo con l’obiettivo di valutare le esperienze e il vissuto di infermieri e di altri professio nisti sanitari impegnati in prima linea in tale ambito, con particolare riferimento alla pratica clinico assistenziale, agli

outcome osservati, alle percezioni e alle prospettive future in ambito cardiologico
In base ai risultati emersi dallo studio potrà essere possibile pianificare gli obiettivi per una migliore programma zione assistenziale sia in ambito ospeda liero che territoriale
È stato condotto uno studio qualita tivo di tipo fenomenologico per descri vere il significato attribuito dal campione di riferimento alle proprie esperienze vissute, riguardanti un concetto o un particolare fenomeno (7). In questo caso, l’esperienza comune è l’emergenza SARS CoV 2 e il fenomeno studiato sarà l’assistenza ai pazienti cardiologici
Il campione di riferimento per le interviste era composto da 14 infermieri e 2 tecnici di fisiopatologia cardiocircola toria e perfusione cardiovascolare (TFCPC) Tutti i professionisti compo nenti il campione ricoprivano ruoli nell’ambito della cardiologia (area ambu latoriale, degenza, terapia intensiva cardiologica, sale emodinamica) Dieci su sedici facevano parte del Gruppo di Studio di Assistenza Infermieristica e Tecnica in Cardiologia della Società Italiana di Cardiologia (SIC)
Lo studio è stato condotto nel periodo maggio settembre 2020 attra verso un'intervista semi strutturata impiegando canali multimediali telema tici (Skype™, Google Meet™, Zoom™) con una durata media di 35 minuti. Considerata la tipologia qualitativa dello studio, le interviste sono state condotte fino al raggiungimento della saturazione dei dati
Mantenendo un’intervista con open ended questions, sono state poste le seguenti domande:
1 L’emergenza coronavirus ha condizio nato le attività sanitarie negli ultimi mesi Secondo la sua opinione ed i suoi vissuti, come l’avvento del COVID 19 può aver condizionato il suo agire quotidiano in ambito cardiologico? Cosa ritiene sia cambiato nel pianifi care ed erogare assistenza ai pazienti cardiologici?
2. Ri p e n s a n d o a l p e r i o d o a p p e n a trascorso, secondo lei, quali sono state l e s i t u a z i o n i o i c a s i c h e p i ù h a n n o s o t t o l i n e a t o q u e s t o c o n d i z i o n a mento?
3. Facendo riferimento al governo clinico dei pazienti cardiologici, quali varia zioni ci sono state nei protocolli di gestione di questi pazienti? Come ne è stato coinvolto?
4 Dal suo punto di vista, come sarebbe intervenuto per migliorare le attività rivolte ai pazienti cardiologici in questo momento così delicato, pensando anche a possibili scenari futuri?
L’analisi del contenuto delle inter viste è stata effettuata in seguito alla loro trascrizione mediante software di testo In una prima fase sono stati considerati i testi procedendo ad una segmentazione analitica del contenuto Lo scopo era quello di individuare in ciascun passaggio del discorso diverse unità analitiche, che potevano essere parole, oppure frasi, affermazioni o interi para grafi dai quali evincere nuclei di signifi cato. Questi nuclei, definibili come “codici”, sono l’esito di processi inferen ziali. I codici correlati a questi nuclei di significato sono stati identificati con sigle o etichette. Considerando la “Grounded Theory” , è stato utilizzato un approccio di tipo bottom up per la ricerca dei dati evidenziati, elaborati tramite il software Atlas ti v 7
Mil 2021; 171(2): 109 134
L’individuazione dei codici è stata condotta in doppio cieco dai due speri mentatori; eventuali divergenze nel coding sono state risolte in collabora zione In una seconda fase sono state individuate le tipologie di relazione tra i codes seguendo il criterio di inclusione Da questa ulteriore analisi sono emerse le “family” , ossia aggregazioni di codici che esprimono il medesimo significato o situazione. Attraverso il software Atlas.ti sono stati sviluppati i grafici contenenti, per ogni family, i codici (evidenziati in base al proprio livello di groundness).
È stato infine strutturato un Word Cloud (Fig. 1) per far emergere i termini maggiormente impiegati dagli intervi stati per raccontare i propri vissuti (www wordcloud com)
L’analisi delle interviste ha portato all’individuazione, nel complesso, di
Fig. 1 Word Cloud risultante dall'analisi delle interviste condotte

140 c o d e s Questi sono stati aggregati in 8 f a m i l y ( Ta b I ) attraverso un criterio basato sulle attività e sui comportamenti dei partecipanti Ai fini
Tab. I Descrizione delle famliy.
della trattazione, per ogni f a m i l y , verranno presentati i c o d e s che hanno trovato più riscontro tra i partecipanti allo studio
Organizzazione (20 codici)
Modificazioni e adattamento della compagine ospedaliera in termini di struttura, personale, dif ficoltà logistiche, creazione di nuovi percorsi, gestione delle attività clinico assistenziali in funzione dell’emergenza SARS CoV2
Esiti, reali e attesi, degli inter venti posti in essere dai professionisti sanitari durante la gestione della pandemia: ruolo della medicina territoriale a supporto nella gestione dei pazienti, valutazione della qualità dell’assistenza e del rapporto con i pazienti, valutazione delle attività ambulatoriali, importanza della sanificazione e della prevenzione delle infezioni, diagnosi e gestione dei pazienti COVID Pazienti (5 codici) Prospettive e atteggiamenti secondo il punto di vista del paziente e loro vissuto
Outcome (20 codici)
Procedure e Protocolli (12 codici)
Variazioni delle procedure e dei protocolli di gestione dei pazienti durante l’emergenza: test di screening, modifiche dei protocolli aziendali, classificazione dei pazienti af ferenti e stratificazione del rischio infettivo con par ticolare attenzione al paziente cardiologico
Professionisti Protezione e sicurezza (8 codici) Atteggiamento dei professionisti sanitari in funzione della sicurezza personale, verso i pazienti e i propri cari

Professionisti Attività (27 codici) Inter venti assistenziali dei professionisti sanitari durante l’emergenza
Professionisti Percezioni ed emozioni (29 codici) Stato emozionale e percezioni degli operatori sanitari Proposte per il futuro (19 codici) Prospettive di miglioramento che comprendono la sfera aziendale, professionale e assistenziale
Med Mil 2021; 171(2): 109 134


Le problematiche organizzative hanno ritrovato particolare riscontro tra i temi trattati nelle interviste In particolare, tra tutti i c o d e s raffigurati nella f i g u r a 2 , è emerso la “ Cr e a z i o n e p e r c o r s i e d a r e e d e d i c a t e p e r i p a z i e n t i COV I D ” Il contesto emergen ziale ha richiamato l’attenzione sulla creazione di percorsi ad hoc per i pazienti afferenti alle strutture di cura al fine di minimizzare il rischio di contagio: “[…] Sono stati messi dei check point fuori l’ospedale, per creare un percorso sicuro; chi presentava rialzo febbrile o sintomato logia veniva inviato ad un altro percorso ” (A Z );
“[ ] quando ci si trovava che il tampone era poi negativo, li si spostava nella
sezione NO COVID della nostra terapia intensiva, in modo tale che la gestione potesse modificarsi e tornare alla gestione precedente” (C A )
Un’altra tematica emersa è stata la “Difficoltà nel garantire la presenza dei familiari con i pazienti” Le restri zioni all’accesso dei familiari hanno condizionato l’agire dei professionisti, i quali hanno incontrato diverse difficoltà nel garantire principalmente le relazioni paziente caregiver: “[…] Sicuramente, abbiamo dovuto porre dei limiti a quello che prima era una prassi ospedaliera riguardante le visite dei fami liari” (P.DA.).
La “Riorganizzazione della strut tura sanitaria”, sia in ambito strutturale che gestionale è stato un altro ambito di particolare interesse emerso dalle inter
viste: “[ ] la cardiologia è stato un reparto che si è cercato di mantenere pulito più a lungo possibile Poi è stato unificato con un altro reparto, in virtù dell’esigenza di creare più reparti di emergenza in cui mettere i pazienti positivi [ ] Sicura mente mi resterà sempre impresso nella mente l’immagine delle persone in pronto soccorso sulle barelle in attesa di avere un posto. Lì davvero la sensazione è stata quella di essere in guerra. Perché erano lì da soli, con la loro bombola di ossigeno, in luoghi dove prima magari c ’ era una sala d’attesa” (A.Z.).
L’emergenza ha portato anche alla “Riorganizzazione delle attività ambu latoriali” di area cardiologica, settore particolarmente in fase di sviluppo negli ultimi anni Durante la pandemia, molti
ambulatori sono stati riadattati per la gestione diretta dei pazienti positivi al COVID 19 e per l’effettuazione dei test di screening:
“[ ] Se c ’ erano dei problemi dei device e comparivano i sintomi che non erano pret tamente associati ai controlli dei device, si cercava di non far venire il paziente risol vendo la problematica imminente, ma facendolo venire successivamente in ambulatorio cardiologico o comunque indirizzandolo verso il professionista più appropriato. Si evitava di far accedere i pazienti in ambulatorio” (C.S.).
Anche le “Difficoltà logistiche nell’approvvigionamento dei DPI” ha rappresentato una tematica particolar mente comune agli intervistati, che hanno evidenziato la scarsità delle risorse e le difficoltà nel reperire materiali idonei alla protezione del personale sanitario e dei
pazienti soprattutto durante la fase iniziale dell’emergenza:
“[ ] e pensare di ricevere i DPI contingentati quotidianamente è stata una cosa a cui non eravamo pronti, perché di solito la fornitura è settimanale e non così limitata” (A Z );
“[ ]la nostra preoccupazione erano i dispositivi di protezione individuale che sono stati un problema per tutti all’inizio di questa pandemia, dispositivi che scar seggiavano” (L.M.).
disinfettanti e degli antisettici, il giusto approccio ai pazienti contagiati e non, l’igiene delle mani, la sanificazione, sono concetti emersi da più professionisti:
La family definita come “Outcome” (Fig. 3) ha avuto, come code maggior mente rappresentato quello denominato “COVID che ha riportato l’attenzione sui percorsi di igiene e sanificazione”
La scrupolosa attenzione alle norme di prevenzione delle infezioni, l’utilizzo dei
“[ ] Unica cosa da parte di tutti i sanitari, si è cercato di avere un ’attenzione maniacale nelle cose particolari, a cui magari prima non davamo la giusta importanza Durante la visita cerchiamo di rimanere più distanziati dal paziente, manteniamo le mascherine anche quando siamo nel corridoio, cerchiamo di tenere l’unità del malato molto pulita, controlliamo la sanificazione delle pareti; prima non facevamo molta attenzione a come si facessero queste cose. Controlliamo come la ditta passa il cloro sulle pareti, che le lenzuola non stazionino nei sacchi aperti. Manteniamo le vie del pulito e dello sporco molto più scru polosamente” (V R )
Uno dei concetti negativi riassunti dalla pandemia è stato codificato come:
Med Mil 2021; 171(2): 109 134


“Riduzione degli accessi d’emergenza per paura di contagio”: “[ ] C’è stata anche una riduzione degli accessi in pronto soccorso per infarto, che poi si è manifestato con aumento delle forme più tardive” (A T ); “[ ] L’unica cosa che so è che nel post lock down non ho mai visto tante urgenze peggiorate, coronarie brutte, infarti brutti con lesioni multiple e complicate. Tutto ciò dovuto al fatto che il paziente non veniva in pronto soccorso ” (M.L.R.).
Parallelamente alla riduzione degli accessi in PS, dallo studio è emerso altresì un preoccupante “Aumento degli outcome negativi per paura del contagio”: “[ ] Sembravamo un po ’ una ditta di traslochi a un certo punto, perché durante il COVID sembrava che nessuno avesse gli infarti, durante il periodo clou; sono ripar titi dopo, come se tutte le malattie fossero
andate in sospensione Dopo sono arrivati infarti tardivi o misconosciuti di cui non si erano accorti durante la quarantena, e quindi arrivavano anche situazioni anche più complesse” (C A )
Tematica affrontata da buona parte degli intervistati ha riguardato la sfera relazionale tra personale sanitario e paziente, racchiusa nel code “Riduzione dell’assistenza relazionale con i pazienti a causa del COVID”:
“[…] È cambiata tanto la nostra capa cità di avvicinarci, che poi pian piano è stata recuperata dopo i primi attimi di paura che penso sia stato normale avere. Comunque, anche per noi professionisti era difficile dire mi avvicino spesso. L’idea era quella di fare tutto insieme in modo tale da andare meno volte dal paziente È cambiato molto dal punto di vista dell’approccio Mentre prima si cercava di stare molto e vicino col paziente, ora non lo si poteva fare” (C A )

In questa family gli intervistati hanno sottolineato la percezione espressa dai pazienti in questo periodo storico Tra i c o d e s rilevati, spicca quello denominato “ S f i d u c i a n e i c o n f r o n t i d el S S N e d ei p r o f es s i o n i s t i sanitari”:
“[…] paura delle persone nel farsi curare in un ambiente che per loro era simbolo di contagio. C’era poca fiducia nelle strutture sanitarie” (P.DA.).

Il code più rappresentato dagli inter vistati (Fig 4) è stato: “Protocolli di gestione COVID”, con particolare riferi mento all’adattamento delle attività tecniche ed assistenziali al nuovo scenario pandemico:
Mil 2021; 171(2): 109 134
“[ ] Abbiamo dovuto cambiare tutti gli aspetti, soprattutto per quanto riguarda l’accoglienza, la tipologia di accoglienza dei pazienti, la metodologia” (I B );
“[ ] Tutti i pazienti che dovevano fare i controlli dei device, non provenienti dai reparti COVID ad alta e bassa intensità, non potevano più accedere agli ambulatori ma venivano dirottati sui reparti” (C S )
Tra i protocolli citati dagli intervi stati, emerge quello legato alla “Gestione dei pazienti come se fossero COVID positivi a prescindere”: “[…] Il problema era che bisognava gestire tutti i pazienti come positivi, perché non avevi informazioni di loro. Molte volte capitava che all’anamnesi del paziente: “Ha avuto contatti? Ha avuto febbre?” era tutta negativa, poi il tampone arrivava positivo Nel caso non si riuscisse ad andare direttamente in sala, il pz veniva accompagnato in un nostro settore filtro, in modo tale che noi lo gestissimo come positivo” (C A )
I “Test di screening generalizzati” sono stati una delle più precoci proce dure di preospedalizzazione nelle prime fasi della pandemia, e, ancora di più, nella cosiddetta Fase 2: “[ ] Inizialmente si effettuavano solo tamponi, ma verso maggio si è iniziato ad effettuare anche dei test sierologici Nella nostra struttura si è adottato anche il protocollo della TC: subito dopo il tampone si faceva la coronarografia e in seguito, qualora il paziente fosse uno STEMI, e quindi necessitava di un inter vento in urgenza, veniva effettuata la TC: in questo caso, il quesito clinico veniva analizzato incrociando i risultati di tutti e tre gli accertamenti, in quanto la TC con l’evidenza dello specialista infettivologico, mostrava un aspetto non da polmonite e trattato come sospetto COVID” (V D G )
Tra gli effetti riscontrati nelle proce dure e protocolli, è emerso il code “Adattamento dei protocolli cardiologici”, dove gli intervistati hanno sottolineato come proprio l’ambito cardiologico sia stato il più coinvolto in cambiamenti e variazioni:
“[ ] Parlo per le acuzie, ovviamente, perché sono quelle che ci riguardano Dato che non si poteva aspettare di tutti l’esito del tampone prima di agire sul paziente o di smistarlo, quando arrivava uno STEMI, il pronto soccorso o il territorio ci chia mava, perché durante il COVID eravamo centro di riferimento di tutta la provincia, eravamo l’HUB, e quindi si è dovuto orga nizzare un protocollo di gestione del paziente cardiologico Si è cercato in modo ancora maggiore di recuperare la golden hour C’era l’accesso diretto alla sala emodinamica dall’ambulanza” (C A )
lavoro avrei dovuto far rientro a casa Lì ti ritrovavi a pensare a quel paziente sospetto e ti venivano mille domande: chissà se ho adottato la giusta tecnica di vestizione e svestizione? Chissà se ho prestato la giusta attenzione” (S C )
Alcuni di essi hanno adottato stra tegie di “Isolamento dalle proprie fami glie per contagio COVID”: “[…] Io non sono più tornata a casa dai miei parenti che non sono di qui e ho fatto bene perché poi ho scoperto di aver avuto il COVID” (A.Z.).

I codes emersi in questa family hanno riguardato gli atteggiamenti dei profes sionisti sanitari condizionati dall’emer genza e dalla paura di un possibile contagio Il code più rappresentato è stato “Paura per contagio da pazienti”: “[ ] L’altro risvolto della medaglia, è che il paziente che aveva fatto meno esami, dopo qualche giorno, magari dopo 5 giorni in UTIC, veniva messo in isola mento. […] E capire anche che livello di rischio ci fosse nel prestare la nostra assi stenza” (N.S.).
Oltre alla paura per un possibile contagio, i professionisti hanno espresso “Timore di essere veicolo di contagio per i familiari”:
“[ ] Prestavo molta più attenzione anche per evitare di portare contagi nell’am biente esterno, sapendo che al termine del
In questa family sono stati raccolti tutti i codes che hanno in qualche modo identificato l’agire professionale degli intervistati Il code più rappresentato in questa family di contenuti è stato: “Inter vento di medici e infermieri a garanzia dei rapporti con i familiari”, in netta sovrapposizione a quanto emerso nella family “Organizzazione”: “[ ] Quindi ci siamo attrezzati con tablet, piuttosto che con altri device per poterli mettere in comunicazione con i parenti e abbiamo cercato di mantenere rapporti telefonici più stretti con la famiglia dacchè non avevamo la possibilità di avere il fami liare in presenza ” (I B )
A testimonianza degli sforzi intrapresi a favore dei pazienti, emerge il code “Professionista che si sostituisce alla figura del familiare durante il ricovero”: “[…] Sapere che sei tu il suo parente in quel momento è stata una parte difficile. Tu hai il volto di sua figlia, hai il volto di sua moglie, di sua madre, hai il volto di tutti È stata una cosa orgogliosa da fare, ti fa sentire quanto tu gli stia dando ma moral mente devastante” (C A )
Un effetto riscontrato da molti degli intervistati è stato anche l’”Aumento dei carichi di lavoro” e la “Disponibilità degli infermieri per ulteriori attività”: “[ ] Per garantire lo stesso numero di prestazioni abbiamo dovuto aumentare i turni di lavoro” (C S ) “[ ] c’è stata una riorganizzazione del personale Tutti abbiamo dovuto dare disponibilità per altri reparti” (A.T.).

La tematica in f i g u r a 5 , legata alle “professioni percezioni ed emozioni” è stata largamente trattata in maniera trasversale da tutti gli intervistati In essa, la family con maggiore ground ness è stata racchiusa nel c o d e “ G e n e rale soddisfazione per quello che si è fatto”:
“[ ] Non mi sento di dare grandi giudizi perché è stato fatto davvero tanto da parte di tutti e soprattutto quando da metà aprile tutti si sono iniziati ad ammalare abbiamo capito veramente che era stato fatto l’impos sibile Magari ci sono state delle mancanze a tutti i livelli, però è stata un ’ emergenza, una cosa che davvero non conoscevamo e che è esplosa all’improvviso” (A Z );
“[…] Tutto sommato con i pazienti cardiolo gici ce la siamo cavata anche piuttosto bene” (C.A.).
Contrariamente al code precedente, sono emersi anche emozioni e percezioni negative dalle attività assistenziali legate ai pazienti cardiologici durante la pandemia Ne sono testimonianza il code denominato “Difficoltà lavorative con DPI avanzati”:

“[ ] Quindi la gestione è più compli cata da tutto ovviamente Dai camici,
doppi guanti anche solo per fare un ’ eco grafia; bisognava avere già tutto pronto, per essere il più autonomo possibile” (C A )
Il code denominato “Disagio operatori per mancata garanzia presenza familiari”: “[ ] Il supporto della famiglia in questo momento ci è venuto a mancare ed è stato veramente complesso anche dare comunica zione al telefono, è stata una roba veramente ingestibile: da ciò proprio l’aspetto sentimen tale è stato molto particolare in quei pazienti anche perché erano pazienti che, volenti o nolenti, non potevi far visitare” (I.B.).
Ed, infine, il code “Iniziale imprepa razione al COVID”: “[ ] Quello che inizialmente ci ha spaven tato più di tutto, era la grande incognita che questo virus potesse cambiarci e in qualche modo renderci meno forti più vulnerabili Avevamo timore di tutto” (L M )
L’intervista strutturata proposta non ha solo cercato di evidenziare i vissuti dei professionisti intervistati, ma anche di individuare eventuali lezioni apprese dai medesimi Tra gli spunti rappresentati in Figura 6, uno dei più interessanti è stato raccolto nel code “Proposta riorganizza zione supporto sanitario territoriale”: “[…] Fossi ai vertici di tutto, il territorio sarebbe ciò che svilupperei ai massimi di gestione” (C.A.); “[…] forse creare una rete territoriale più forte potrebbe essere d’aiuto” (A.Z.).
Anche i DPI sono stati oggetto di inte resse da parte degli intervistati Verso di essi è possibile riconoscere la presenza del code “Standardizzare impiego DPI”, anche in ottica futura: “ [ ] L’ o b i e t t i v o è q u e l l o d i f a v o r i r e l a
presenza e il corretto utilizzo dei DPI in s a l a , d a l l a v e s t i z i o n e a l l a s v e s t i z i o n e , s o p r a t t u t t o i n a m b i e n t i r a d i o e s p o s t i ”
(P DA )
Dai risultati sono emerse proposte sull’adattamento delle strutture ospeda liere e dei reparti I contributi, in tal senso, sono stati individuati nel code “Adeguamento strutturale stanze di degenza”:
“[…] Secondo me abbiamo un problema soprattutto strutturale. Faccio un esempio: l’ospedale in cui presto servizio è nato nel 1960, pertanto ha una struttura concepita per un ambiente di quell’epoca, quindi c’è solo la porta di entrata; mentre, in periodi come questo ci sarebbe bisogno di zone filtro, una gestione della sala di UTIC e un filtro di uscita, cosa che penso sarà prevista nella struttura degli ospe dali che nasceranno da qui in avanti
Purtroppo la maggior parte delle strut ture presenti in Italia non sono state create per fronteggiare situazioni simili Inoltre, secondo, me sarà necessario prevedere in ogni reparto ospedaliero delle zone di isolamento per prevenire situazioni del genere, siano esse dovute al COVID 19 o ad altre patologie che potreb bero colpirci in futuro facendo in questo modo sia prevenzione che un conteni mento delle varie situazioni” (V.R.)

In Italia, nell’ambito del monito raggio sanitario relativo alla diffusione del Coronavirus sul territorio, alla data del 29 febbraio 2020 risultavano 1049 persone positive al virus (8) Oggi si contano più di 97 600 decessi e oltre 2 925 000 contagi (9)

Questo studio, basato su un progetto di ricerca fenomenologica, ha permesso di far emergere i vissuti dei professionisti sanitari di area cardiolo gica durante le fasi inziali della pandemia da SARS CoV 2 La peculia rità di questo approccio metodologico ha evidenziato differenti aspetti espe rienziali di infermieri e tecnici di fisio patologia cardiocircolatoria e perfu sione cardiovascolare, altrimenti non riscontrabili con metodologie quantita tive. Le interviste semi strutturate, inoltre, hanno garantito la possibilità di esplorare, in maniera mirata, aspetti di particolare interesse. Dal WordCloud presentato in f i g u r a 6 , emergono i termini maggiormente impiegati dai professionisti intervistati: spicca la centralità del paziente, ma anche il contesto COVID e gli elementi legati al cambiamento
Dalla decodifica dei testi delle inter viste raccolte riguardo l’impatto dell’e mergenza da SARS CoV 2, è emersa una serie di temi (family) principalmente legate agli attori di questa pandemia: personale sanitario, pazienti e aziende ospedaliere
L’ambito legato al personale sanitario è stato principalmente coinvolto in cita zioni afferenti alle attività svolte, alle emozioni percepite, all’aspetto relazionale con i pazienti ed i loro familiari Invece, l’ambito legato ai pazienti ha fatto riferi mento principalmente ai loro bisogni, ai loro outcome ed alle emozioni che essi hanno fatto trasparire nei confronti del personale intervistato. Infine, l’organizza zione è stata menzionata principalmente come oggetto di profonde e radicali trasformazioni, di adattamenti strutturali ed organizzativi e di attenzioni relative ai possibili scenari futuri

La tematica “organizzazione” risulta chiaramente una delle più condivise tra i
vari professionisti intervistati L’emer genza ha portato alla necessità di creare nuovi percorsi e nuove strutture, nonché aree dedicate alla gestione dei pazienti positivi al coronavirus e percorsi clinico assistenziali ad hoc per i pazienti negativi o potenzialmente sospetti Sono state create aree di triage per lo screening dei pazienti, zone filtro per i casi sospetti e diverse aree di isolamento, tutte gestite da personale dedicato, prassi adottata soprattutto in caso di procedure di chirurgia cardio toracica (10). Questo adattamento strutturale ha condizionato anche l’operato dei professionisti che, se da un lato avevano bisogno di indicazioni più chiare e standardizzate per la gestione dei pazienti, dall’altro hanno dovuto attendere diverso tempo prima che i nuovi protocolli fossero validati e resi operativi Tra questi, il protocollo che più ha condizionato l’organizzazione lavora tiva all’interno dei reparti, è stato il divieto d’ingresso ai familiari dei pazienti Infatti, i partecipanti allo studio raccontano di aver avuto molte difficoltà nella gestione dei pazienti, i quali, lontani dai propri cari si sentivano abbandonati e disorientati con conseguente peggioramento delle condi zioni, non solo cliniche, ma anche legate alla propria sfera personale Per garantire la comunicazione e una continuità del rapporto con le famiglie, molti reparti si sono organizzati distribuendo persino dispositivi elettronici ai pazienti; talvolta, alcuni infermieri raccontano di essersi dovuti sostituire alla figura dei parenti. Questi bisogni, emersi dai pazienti, hanno avuto inevitabili ripercussioni emotive sugli operatori, spesso mascherate dai DPI: proprio quei dispositivi di protezione individuale che sono stati oggetto di discussione durante le interviste
Le difficoltà di approvvigionamento e di utilizzo dei dispositivi di protezione individuale sono emerse soprattutto tra
gli operatori provenienti dalle zone più colpite dall’emergenza, con particolare riferimento alle fasi iniziali, quando le richieste di materiale erano incompatibili con le effettive disponibilità Molti infer mieri si sono dovuti adattare, come meglio potevano, sia per ridurre il rischio di contagio tra i pazienti, che per proteggersi da essi Successivamente, le aziende ospe daliere hanno saputo affrontare le diffi coltà logistiche, garantendo ai pazienti e agli operatori protezioni adeguate. Alcuni intervistati hanno riportato particolari difficoltà nella gestione dei presidi di protezione più avanzati, nonché la mancanza di formazione e di protocolli standardizzati per il loro utilizzo, tanto da ricorrere a tutorial informatici o ai sugge rimenti dei colleghi più esperti Anche in questo caso, le aziende hanno provveduto, solo in un momento successivo, a dira mare le opportune indicazioni colmando un gap forse prevenibile; nella sfera della prevedibilità, secondo gli intervistati, rica drebbero anche potenziali carenze strut turali dei reparti di impiego
Sul piano organizzativo, il principale effetto della situazione emergenziale contingente è stata la repentina sospen sione delle attività programmate in regime ordinario per lasciare spazio alla gestione dei casi positivi e delle acuzie All’inizio, gli ambulatori hanno avuto una spinta positiva nella gestione dei pazienti cardiologici cronici, continuando, e anzi incrementando, la gestione dei follow up a garanzia dei propri pazienti, evitando, di fatto, il rischio di possibili contagi tramite attività di telemonitoring (11). Nella fase centrale della pandemia, invece, soprattutto nei centri maggior mente colpiti del nord Italia (12), quando il numero di pazienti ospedalizzati era diventato insostenibile, le aziende ospe daliere hanno dovuto sospendere anche le attività ambulatoriali programmate,
Mil 2021; 171(2): 109 134
per sfruttare al massimo le poche risorse disponibili per i ricoveri In ragione di questa necessità, i reparti di cardiologia hanno dovuto effettuare scelte complesse in merito alle urgenze (13) Questa forma di riorganizzazione ha coinvolto la maggior parte delle strutture ospedaliere, comprendendo anche i centri HUB, i quali hanno dovuto assorbire un elevato numero di emergenze cardiologiche che le strutture SPOKE non sarebbero riuscite a trattare, in quanto dedicate alla gestione dei pazienti COVID positivi (14). Cionono stante, i nuovi protocolli, non essendo variati nel timing, hanno potuto garantire comunque gli interventi in urgenza; inoltre, si è percepito un graduale aumento delle misure di sicurezza a tutela del personale e dei pazienti Questi ultimi venivano sottoposti a controlli seriati della temperatura corporea e a tampone naso faringeo, a prescindere dal motivo del ricovero

Tra gli elementi proattivi maggior mente rappresentati nelle interviste, emerge la grande adattabilità espressa dal nostro Sistema Sanitario durante l’emergenza, nonostante le mille diffi coltà logistiche ed organizzative Garan tire un percorso sicuro per la gestione delle urgenze cardiologiche, assistere il paziente con sindrome coronarica acuta, ridurre il rischio di contagio durante le procedure invasive, erogare un ’assistenza dedicata al paziente durante e dopo tali procedure hanno rappresentato elementi inderogabili a garanzia del paziente, nonostante una generale e profonda riorganizzazione sanitaria. Secondo gli intervistati, gli aspetti che hanno condizionato maggiormente l’assistenza infermieri stica e tecnica durante le procedure di urgenza cardiologica sono stati fonda mentalmente: l’esecuzione dei test di screening (tampone) prima o dopo
intervento in sala emodinamica, l’uti lizzo dei DPI ed i processi di sanifica zione Sia dalle interviste che dalla lette ratura (12) si evince come l’esito del tampone non fosse vincolante per l’inizio delle procedure di rivascolariz zazione; il paziente veniva gestito come positivo a prescindere, adottando tutte le misure di protezione individuale, di sanificazione e di isolamento fino all’e sito del tampone.
Nonostante il sistema abbia garantito una certa sicurezza nelle tempistiche e nei trattamenti dei pazienti con eventi cardiovascolari, nella family “pazienti” emerge la loro paura di recarsi in ospe dale e la sfiducia nei confronti del Sistema Sanitario e degli operatori, visti come untori e non più come “eroi” come era mediaticamente solito identificarli all’inizio della pandemia
Da questa paura si possono far deri vare gli “outcome” dei pazienti cardio logici Molti infermieri in servizio presso le unità di terapia intensiva cardiologica o pronto soccorso, dichia rano di aver percepito un brusco calo, sia negli accessi, che nelle procedure Alcuni descrivono casi di infarti tardivi o di rottura di cuore, complicanze post ischemiche che non si registravano ormai da tempo, vista l’efficiente rete di emergenza sanitaria sul territorio Molti pazienti giungevano in ospedale già deceduti per le riacutizzazioni, altri sceglievano di non riferire la propria sintomatologia per paura di essere rico verati e dover lasciare, senza la certezza di un ritorno, le proprie fami glie. Quello che ci si aspetta dal futuro, secondo alcuni operatori, sarà un importante aumento dei casi di scom penso cardiaco riacutizzato, con un aumento generale delle patologie cardiache, vista la reticenza e la paura generata dall’emergenza
Nonostante queste previsioni non rassicuranti, l’outcome relativo alla qualità dell’assistenza infermieristica al paziente cardiologico sembrerebbe apparentemente migliorato, in quanto il rapporto infermiere paziente, inteso come carico di lavoro 1:1, è stato favorito dalle disposizioni dettate dalla pandemia: l’infermiere, senza caregiver a supporto e con scarsi DPI a disposizione, ha dovuto gestire autonomamente e continuativamente ogni singolo paziente, per soddisfare tutti i suoi bisogni e sopperire alla mancanza dei familiari, una sorta di patient centered care.
Anche da parte loro però emergono paure, senso di inadeguatezza e timore di possibili contagi; tra queste sensa zioni, la più temuta era il timore di essere veicolo di contagio per i propri cari, più che per sé stessi Molti di loro hanno scelto di vivere lontani dalle proprie famiglie, altri attendevano i risultati dei tamponi dei pazienti prima di andare via, generando attese lunghe ed estenuanti, benché necessarie per escludere il rischio e poter tornare alle proprie vite Lo sforzo degli operatori sanitari è stato imponente nella gestione dell’emergenza, come ampia mente descritto in letteratura e ripor tato nell’esperienza bergamasca del “Papa Giovanni XXIII” (15) Tutto questo si riscontra sia in letteratura (16) che dai contributi emersi dagli intervistati, identificato nella family “professionisti”: aumento dei carichi di lavoro per garan tire l’efficienza dei reparti, disponibilità a ricoprire turni lasciati scoperti da colleghi perché positivi al COVID 19, azioni di sostegno verso i familiari che avevano perso i propri cari, supporto reciproco tra colleghi, gestione dei pazienti da remoto Sono molte le tema tiche emerse dai partecipanti, alcune di queste raccontate con soddisfazione,
altre invece, descritte con malinconia, come l’impotenza davanti agli esiti negativi dei pazienti cardiologici o l’aspetto relativo alla gestione delle salme Molti infermieri ricordano con tristezza di aver avuto difficoltà nel comunicare alle famiglie la scomparsa del proprio caro e soprattutto, di non aver potuto garantire la dignitosa ritualità nei confronti del defunto e delle famiglie. Questo aspetto, oltre a molti altri, è uno degli effetti dell’emer genza che i partecipanti chiedono di cambiare in vista di una seconda ondata pandemica.
Pensando al futuro, infine, dallo studio emergono diverse tematiche. Da una parte si evince come gli intervistati si ritengano soddisfatti per la gestione globale dell’e mergenza, facendo riscoprire un forte senso di appartenenza alla professione Dall’altra, si solleva il comune auspicio verso la risoluzione delle criticità emerse per le tempistiche di sviluppo dei proto colli, per la definizione dei percorsi di gestione dei pazienti COVID e per la stan dardizzazione delle procedure di scree ning a tutela degli operatori sanitari Dai dati forniti dallo studio è interessante notare come tutti i professionisti non augurino un ritorno alle fasi primitive dell’emergenza, ma dichiarano di essere ormai pronti e di avere i giusti strumenti per fronteggiare, con risultati immediati, un ’eventuale seconda ondata pandemica da SARS CoV 2.
I partecipanti allo studio, visti gli ottimi risultati ottenuti nella gestione dei pazienti cronici, attraverso la collabora zione con gli specialisti e medici di medi cina generale, sperano in un potenzia mento della telemedicina e nel migliora mento della gestione dei pazienti cardio logici a livello ospedaliero attraverso un’importante attività di pianificazione e partecipazione della sanità territoriale
L’emergenza SARS CoV 2 ha condi zionato le attività economiche, sociali e culturali a livello internazionale In Italia ha rappresentato, e tutt’ora rappresenta, una sfida per il Sistema Sanitario Nazio nale Attraverso le percezioni e le espe rienze sul campo dei professionisti del settore, lo studio fenomenologico quali tativo ha potuto evidenziare “nuovi” aspetti nelle dinamiche clinico assisten ziali relative alla qualità di prestazione fornita ai pazienti cardiologici.
Le tematiche principali emerse dalle interviste riguardano la riorganizzazione del sistema sanitario ospedaliero, gli outcome e le percezioni dei pazienti cardiologici, il ruolo dei professionisti sanitari durante l’emergenza e i loro stati d’animo, con uno sguardo rivolto alle proposte future di assistenza
Secondo i dati emersi dallo studio, l’assistenza sanitaria ai pazienti cardiolo gici è stata condizionata soprattutto nei percorsi di gestione dei pazienti positivi al COVID 19, ponendo un giusto focus sull’importanza della prevenzione delle infezioni e sui protocolli di igiene e sani ficazione quotidiana
Le attività assistenziali hanno richiesto uno sforzo maggiore da parte di tutti gli operatori sanitari, sottoposti a carichi di lavoro aumentati, con ripercus sioni a livello sia fisico che emotivo.
La gestione dei pazienti cardiologici cronici ha avuto ottimi risultati grazie alla telemedicina e alla collaborazione con il Sistema Sanitario territoriale. Gli interventi atti a gestire le emergenze cardiologiche sono stati comunque garantiti, attraverso dei percorsi di gestione validati e standardizzati
L’aspetto relazionale infermiere paziente è stato fortemente condizionato
dall’emergenza; tuttavia lo spirito critico e la dedizione per la propria missione hanno saputo accorciare le distanze dettate dalla pandemia.
Per il futuro, i professionisti sanitari auspicano il potenziamento della sanità territoriale, riscoperto pilastro fondamen tale dell’assistenza, e una rivisitazione proattiva dell’organizzazione ospedaliera.
In conclusione, l’emergenza SARS CoV 2 si è abbattuta con una forza disarmante e silenziosa Tuttavia, il nostro Sistema Sani tario e i nostri ospedali hanno risposto adeguatamente grazie alla determinazione di tutti gli operatori, che con orgoglio e senso di appartenenza, si sono spesi per il bene dei loro pazienti e dei loro cari
1 Izda V, Jeffries MA, Sawalha AH COVID 19: A review of therapeutic strategies and vaccine candidates Clin Immunol [Internet] 2021;222:108634 Available from: http://www ncbi nlm nih gov/pubmed/3 3217545.

2. Pecora D, La Greca C, Pezzotti E, Botti P, Campana M, Cuccia C : An unusual presentation of cardiac involvement during the COVID 19 pandemic G Ital Cardiol (Rome) [Internet] 2020 Aug;21(8):594 7 Available from: http://www ncbi nlm nih gov/pubmed/3 2686784
3. Lauer SA, Grantz KH, Bi Q, Jones FK, Zheng Q, Meredith HR, et al : The incubation period of coronavirus disease 2019 (CoVID 19) from publicly reported confirmed cases: Estimation and application Ann Intern Med 2020;172(9):577 82.
4 Scotto di Uccio F, Valente S, Colivicchi F, Murrone A, Caldarola P, Di Lenarda A, et al : ANMCO POSITION PAPER: Network Organization for the Treatment of Acute Coronary Syndrome Patients during the Emergency COVID 19 Pandemic Eur Hear J Suppl 2020;22( Supplement G):G223 7
Mil 2021; 171(2): 109 134
5 Scattoni ML, Fulceri F, D’Ancona F, Costantino A, Zuddas A, De Girolamo G, et al.: Indicazioni ad interim per un appropriato sostegno degli operatori sanitari e sociosanitari durante lo scenario emergenziale SARS COV 2 [Internet] 2020 Available from: https://www iss it/documents/20126/0/ Rapporto+ISS+COVID 19+22 2020+rev pdf/4e74375d d7a5 705e 0d68 57768aa2eca4?t=1590750750447.
6. Iacobazzi D, Baquedano M, Madeddu P, Caputo M.: COVID 19, State of the Adult and Pediatric Heart: From Myocardial Injury to Cardiac Effect of Potential Therapeutic Intervention Front Cardiovasc Med 2020;7(July):1 9
7. Semeraro R.: L’analisi qualitativa dei dati di ricerca in educazione Ital J Educ Res 2014;(7):97 106
8 Covid 19: i casi in Italia alle ore 18 del 29 febbraio [Internet] 2021 [cited 2020 Oct 1] Available from: http://www salute gov it/portale/news/p 3 2 1 1 1 jsp?lingua=italiano&menu=noti zie&p=dalministero&id=4133#:~:text=Ne ll’ambito del monitoraggio sanitario,persone risultano positive al virus
9 Civile P : Numeri Pandemia Italia [Internet] 2021 [cited 2021 Feb 28] Available from:

https://opendatadpc maps arcgis com/ap ps/opsdashboard/index html#/b0c68bce 2cce478eaac82fe38d4138b1.
10. Bonalumi G, di Mauro M, Garatti A, Barili F, Gerosa G, Parolari A.: The COVID 19 outbreak and its impact on hospitals in Italy: the model of cardiac surgery Eur J Cardiothorac Surg 2020;57(6):1025 8
11. Kołtowski Ł, Krzowski B, Boszko M, Paskudzka D, Peller M, Lodziński P. et al.: Cardiological teleconsultation in the coronavirus disease 2019 era: patient’s and physician’s perspective Kardiol Pol [Internet] 2021;79(1):76 8 Available from: http://www ncbi nlm nih gov/pubmed/3 3399297
12. Stefanini GG, Azzolini E, Condorelli G.: Critical Organizational Issues for Cardiologists in the COVID 19 Outbreak: A Frontline Experience from Milan, Italy Circulation 2020;1597 9
13 Khazanie P, Wynia MK, Dickert NW : Forced Choices: Ethical Challenges in Cardiology During the COVID 19 Pandemic. Circulation [Internet]. 2020;142(3):194 6 Available from: http://www ncbi nlm nih gov/pubmed/3 2392096
14 Cortese B : COVID 19 pandemic Some cardiovascular considerations from the trench Am Heart J 2020;(July):1 2
15 Senni M : COVID 19 experience in Bergamo, Italy Eur Heart J 2020;41(19):1783 4.
16. Han JJ, Luc JGY, Pak E.: Ethical Dilemmas Associated With the COVID 19 Pandemic: Dealing With the Unknowns and Unanswerables During Training J Am Coll Cardiol [Internet] 2020 Sep 8;76(10):1266 9 Available from: http://www ncbi nlm nih gov/pubmed/3 2883420.
Disclosures:
Gli Autori dichiarano nessun conflitto di interessi
Articolo ricevuto il 20 02 2021; rivisto il 28 02 2021; accettato il 15 04 2021
G Med Mil 2021; 171(2): 109 134
Abstrect Introduction: The required The reorganisation of the hospital and territorial network due to the SARS CoV 2 pandemic has inevi tably involved cardiology and caused the strong remodelling of protocols and diagnostic and therapeutic procedures. Purpose: A qualitative study was carried out to assess the impact of the SARS CoV 2 emergency on cardiac patients' care M a t e r i a l s a n d m e t h o d s : The study was conducted from May to September 2020 through semi structured interviews The sample for the interviews is composed of 14 nurses and 2 technicians of cardiocirculatory physiopathology and cardiovascular perfusion (TFCPC) Results: The content of the interviews was classified with 140 codes grouped into 8 different sections The main issues that emerged from the interviews concerned the reorganisation of the hospital health system, the outcome and perception of cardiologic patients, the role of health care providers and their moods during the emergency, with an eye to future care proposals Conclusion: At the end of the study, we can say that the professionalism expressed by the health care providers has led to positive results through a concrete spirit of adaptation and despite the uncertainties that emerged, especially during the first pandemic wave
Key words: SARS CoV 2, COVID 19, health care providers, cardiac patients, qualitative study.

• The pandemic has led to radical changes in the structural and functional organisation of hospitals and local health care
• Health care providers adapted to the changes dictated by the SARS CoV 2 pandemic, despite the difficulties they have experienced, especially in the first pandemic wave
The SARS CoV 2 pandemic still represents a great and unexpected chal lenge for our country and its national health system.
Although the entire scientific commu nity has worked tirelessly to find short term therapeutic approaches and a long term vaccine solution to reduce the spread of COVID 19 and curb its morbidity and mortality, the pressing issues surrounding
the production and mass distribution of vaccines and other therapeutic strategies still need to be resolved (1)
Cardiovascular involvement ranks first among the effects of COVID 19 (2) Several clinical trials shown that COVID 19 has a higher incidence and a higher mortality rate in patients with cardiova scular comorbidities (3).
A reorganisation of both hospital and territorial network was necessary to cope with the emergency, inevitably
involving the cardiology field with a strong remodelling of protocols and diagnostic and therapeutic pathways (4) While most patients were frightened by media information on the progress of the pandemic cases and were reluctant to go to health facilities, hospitals, clinics and first aid units had to readjust hospitalisa tion and emergency measures and patient management. This was achieved both during the emergency phase by considering all potentially positive users
* Warrant Officer 1 (Nurse) Military School of Medicine and Veterinary Sciences, Rome.

** Col , MD Military General Hospital, Rome Deputy Head of Haemodynamics and Cardiac Surgery, Rome
° Lt , Nurse Military School of Medicine and Veterinary Sciences Section Head, Nursing Sciences Institute, Rome
Corresponding author: Warrant Officer 1 Nicolas Nicolas LANNI Email: nicolaslanni@hotmail it
and directing non deferrable cases to hubs, and by election, by through reorga nisation of general wards into "COVID" / "Non COVID" wards with dedicated staff and defined protocols (4)


The emergency did not concern the organisation alone, but also the profes sional system of health care providers They had to cope with uncertainties, changes in work routines and protocols. Health care personnel had to leverage their clinical care skills to better support lonely and frightened patients (5).
In light of data provided by the litera ture on the correlation between COVID 19 and cardiovascular comorbidities, the importance of evaluating changes in care for cardiologic patients appears clear (6)
Considering the absence of standar dised tools to assess the impact of the SARS CoV2 emergency in the care of cardiac patients, a qualitative study was conducted to evaluate the experiences of nurses and other committed health care providers at the forefront in this area, with particular reference to clinical care practice, observed outcomes, percep tions and future perspectives in the cardiology field
Based on the results that emerged from the study, it may be possible to plan objectives for better care planning in the hospital and the local area.
phenomenon (7) In this case, the common experience is the SARS CoV 2 pandemic, and the phenomenon we studied is the care of cardiac patients
The sample for the interviews was composed of 14 nurses and 2 technicians, i e all experts dedicated to cardiovascular pathophysiology and cardiovascular perfusion (TFCPC) All health care provi ders making up the sample held roles in cardiology (outpatient area, hospitalisa tion, cardiologic intensive care, hemody namic room). Ten out of sixteen were part of the Study Group of Nursing and Tech nical Assistance in Cardiology of the Italian Society of Cardiology.
The study was conducted in May September 2020 through a semi struc tured interview using remote connection platforms (Skype ™ , Google Meet ™ , Zoom ™) with an average duration of 35 minutes Considering the qualitative nature of the study, the interviews were conducted until data was saturated
The following open ended questions were asked during the interview:
1 The coronavirus emergency has affected health care activities in recent months In your opinion and expe rience, how could the advent of COVID 19 affected your daily life in the cardio logy field? What do you think has changed in planning and providing care for cardiac patients?
2. If you look back at the last period, what were the cases that most emphasised this condition in your opinion?
Interview transcripts were analysed using textual software In the first phase, the transcripts underwent analytical segmentation of content The aim was to identify different analytical units in each passage of the discourse, which could be words, sentences, statements, or entire paragraphs from which it is possible to extract common patterns These patters, defined as "codes", are the result of infe rential processes. The codes related to patterns of meaning werere then identi fied with abbreviations or labels. Consi dering the "Grounded Theory", a bottom up approach was used to search for high lighted data, that have been processed via Atlas.ti v.7 software.
The identification of codes was carried out in a double blind approach by two investigators; any differences in coding were resolved in cooperation In a second phase, the types of relationship between the codes were identified following the inclusion criterion From this further analysis, "sections" emerged, that is, aggregations of codes that express the same meaning or situation Using Atlas ti, graphs were developed contai ning codes for each section (highlighted according to their level of groundness)
Finally, a word cloud (www word cloud com) (Figure 1) was structured to bring out the terms most frequently used by the interviewees to describe their experience.
A qualitative phenomenological study was conducted to describe the meaning the elements of the sample attributed to their own experience referred to a particular concept or
3. Referring to the clinical governance of cardiac patients, haw have the mana gement protocols of these patients changed? How did you get involved?
4. From your perspective, how would you intervene to improve the activities aimed at cardiac patients in this sensi tive time, also thinking about possible future scenarios?
The analysis of the interviews led to the identification of 140 codes, which were aggregated into 8 sections (Table I) based on participants’ activities and behaviour criteria For each section, the codes that found the most response among the participants in the study will be presented for the discussion
G Med Mil 2021; 171(2): 109 134
Fig. 1 Word Cloud from the analysis of the interviews transcripts.

Organisational issues found confir mation among the topics dealt with in the
interviews Among all the codes shown in figure 2, the “Creation of dedicated paths and areas for COVID patients” emerged particularly The emergency
Tab. I Section description.
drew attention onto the creation of ad hoc paths for patients within care facili ties to minimize the risk of contagion: "[ ] Checkpoints were set up outside the hospital to create a safe path; those who presented with feverish symptoms or symptoms were sent to another path” (A Z );
"[ ] when it happened that the swab was negative, they were then moved to the NO COVID section of our intensive care, so that the management could change and return to the previous regime" (C.A.).
Another issue that emerged was the "Difficulty in guaranteeing the presence of relatives to patients" . The restrictions on the access of patients’ relatives affected the health care provi ders' actions, who encountered many difficulties in ensuring patient caregiver relationships:
“[ ] Surely, we had to put limits on what was previously a hospital practice regar ding family visits” (P DA )
Organisation (20 codes)
Outcome (20 codes)
Patients (5 codes)
Procedures and Protocols (12 codes)
Health care providers Protection and security (8 codes)

Health care providers Perceptions and emotions (29 codes)
Proposals for the future (19 codes)
Modifications and adaptation of the hospital structure in terms of staf f, logistical dif ficulties, creation of new dedicated paths, management of clinical assistance activities concerning the SARS CoV 2 emergency
Actual and expected outcomes of the inter ventions put in place by health care providers during the pandemic: role of territorial medicine in suppor t of patient management, assessment of care and relationship quality with patients, outpatient activities assessment, the impor tance of sanitation and prevention in infections, diagnosis and management of COVID patients
Perspectives and attitudes according to the patient's point of view and their experience
Changes in patient management procedures and protocols during the emergency: screening tests, changes in hospital protocols, classification of af ferent patients and infectious risk stratification with par ticular attention to the cardiac patient
The attitude of health care providers to personal safety towards patients and their loved ones
Emotional state and perception of health care providers
Prospects for improvement which includes hospital, professional and care settings fields
Mil 2021; 171(2): 109 134
The "Reorganisation of the health care " , both in the structural and manage rial context, was another area of parti cular interest that emerged from the interviews:
“[ ] Cardiology was a department that we tried to keep clean as long as possible Then it was merged with another depart ment to create more emergency depart ments in which to put positive patients [ ] Surely, I shall never forget the image of people in the emergency room on stret chers waiting for a bed. There was a feeling of being at war because they were there alone, with their oxygen tank, in rooms which might have been waiting rooms"(A.Z.).
The emergency has led to the “Reor ganisation of outpatient activities” in the cardiology area, a sector particularly under development in recent years
During the pandemic, many outpatient clinics were adapted for the management of CAVID 19 positive patients and carrying out screening tests
“[ ] If there were device problems and symptoms appeared that were not strictly associated with the device controls, we did not let patients come in, but by solving the imminent problem, we let them come later to the cardiology clinic or, in many cases, direct them to the most appropriate health care provider. We avoided having patients access the clinic” (C.S.).
The "Logistic difficulties in the PPE procurement" was also a prevalent issue for the interviewees. They highlighted the scarcity of resources and difficulties in finding suitable materials to protect health care providers and patients, espe cially during the initial phase of the emergency:
“[ ] And thinking of receiving PPE quota daily was something we were not ready for because it is usually a weekly supply and it is not so limited” (A Z );
"[ ] our concern was the personal protec tive equipment that was a problem for everyone at the beginning of this pandemic: devices that were in short supply" (L M )

As the most frequently occurring code, the one defined as "Outcome" (Figure 3) contained one called "COVID drawing attention onto hygiene and sanitation" . The scrupulous attention to infection prevention rules, the use of disinfectants and antiseptics, the right approach to infected and non infected patients, hand hygiene, sanitation are all

concepts that emerged from several health care providers:
"[
] All health care providers tried to pay meticulous attention to particular things that we were not used to giving much importance to During the visit of patients’ relatives, we stayed further away from patients; we kept our masks on even when we were in the corridor, kept the patient's unit very clean and checked sanitation of the walls. We did not pay much attention to how these things were done before then. We checked how the cleaning staff passes the chlorine on the walls, that the sheets were not left in the open bags while keeping the ways of cleanliness and dirt much more scrupulously" (V.R.)
One of the negative concepts summa rised by the pandemic was codified as "Reduction in emergency access due to fear of contagion" :
"[ ] There was also a reduction in access to the emergency room for heart attacks, which then led to an increase in many consequences " (A T );
"[ ] The only thing I know is that, after lock down, I’ve never seen so many bad emergen cies, ugly coronary artery diseases, ugly heart attacks with multiple and compli cated lesions All this because patients did not come to the emergency room " (M L R )
In parallel with the reduction in the access to the emergency room, the study also revealed a worrying " I n c r e a s e i n n e g a t i v e o u t c o m e s d u e t o f e a r o f contagion" :
"[...] At one point, we looked a bit like a moving company because, during COVID, it seemed that no one had heart attacks during the peak period They started again afterwards as if all the illnesses had gone into suspension Later, we saw unre
cognised or late heart attacks that were not noticed during the quarantine: even more complex situations” (C A )

The issue addressed by most of the interviewees concerned the relationship between health care providers and patients, as expressed by code: "Reduc tion in relational assistance to patients due to COVID" : “[…] Our ability to get close has changed a lot, but then slowly, it has recovered after the first moments of fear that I think it was normal to have. However, even for us health care providers, it was difficult to say I often get close. The idea was to do everything together in such a way as to go to the patient fewer times. A lot has changed from the point of view of the approach Whereas before we tried to be very close to the patient, now it could not be done” (C A )

In this section, the interviewees underlined the perception expressed by patients in this historical time Among the codes detected, the one called "Distrust in the national health service and health care providers" stands out “[ ] Fear of people being treated in an environment that for them was a symbol of contagion. There was little trust in the health facilities "(P.DA.).

The code most represented by the interviewees (Figure 4) was "COVID management protocols", with particular reference to the adaptation of technical and assistance activities to the new pandemic scenario:
"[ ] We had to change all aspects, espe
cially as regards the reception, the type of patient reception, the methodology" (I B ); "[ ] All the patients who had to check the devices not coming from the high and low intensity COVID wards could no longer access the outpatient clinics but were diverted to the departments" (C S )
Among the protocols cited by the interviewees, the one related to the "Management of patients as if they were COVID positive" emerges: “[…] times that at the patient's anamnesis: "Did you have any contact? Did you have a fever?" was negative, and then the swab came positive. If it was not possible to go directly to the room, patients were accom panied to one of our filter sectors, so that we would handle them as positive "(C A )
The "Generalised screening tests" were one of the earliest pre hospitalisa tion procedures in the initial stages of the

pandemic, and even more in the so called “Phase 2”:
“[ ] Initially, only swabs were carried out, but since May, serological tests were also used In our facility, the CT protocol was also adopted: coronary angiography was done immediately after the swab, and later, if the patient was a STEMI and therefore needed an emergency interven tion, the CT was performed. In this case, the clinical question was analysed by cross referencing the results of all three tests, as the CT scan with the evidence of the infectious disease specialist showed a non pneumonia aspect and treated as a suspected COVID case ” (VDG);
Among the effects found in the proce dures and protocols, the "Adaptation of cardiac protocols" code emerged, where the interviewees stressed that the cardiologic field was the most involved in changes and variation:
“[ ] I speak for the acuteness, of course, because they are what concern us Since we could not wait for the outcome of everyone ' s swab before acting on the patient or sorting s/he out when a STEMI arrived, the emergency room or the terri tory called us because, during COVID, we were the reference centre for the whole province We were the HUB, and therefore a cardiac patient management protocol had to be organized. An even greater effort has been made to make up for the golden hour. There was direct access to the haemodynamics room from the ambu lance" (C.A.):

The codes that emerged in this section concerned the attitudes of health care providers conditioned by the emer gency and fear of possible contagion The most represented code was "Fear of contagion from patients" : “[ ] The upside is that patients who had d o n e f e w e r e x a m s , a f t e r a f e w d a y s , p e r h a p s a f t e r 5 d a y s i n C I C U, w e r e p l a c e d i n i s o l a t i o n [ ] An d a l s o u n d e r s t a n d i n g t h e r i s k i n v o l v e d i n p r o v i d i n g assistance” (N S )
In addition to fear of possible conta gion, the health care providers expressed "Fear of being a source of contagion for their family members" : "[...] I also paid much more attention to avoid bringing infections into the outside environment, knowing that, at the end of my shift, I had to go home. You found your self thinking about that suspicious patient, and asking yourself a thousand questions: who knows if I adopted the right dressing and undressing technique? Who knows if I paid enough attention?" (S C )
Some of them adopted strategies of "Isolation from their families for COVID contagion" : "[ ] I have never returned home to my relatives who are not from here, and I was right because I later discovered I had COVID" (A Z )
Mil 2021; 171(2): 109 134
All the codes that identified the professional actions of the interviewees were collected in this section. The most frequent code was "Intervention by doctors and nurses to guarantee rela tionships with relatives" . It clearly over laps with the "Organisation" family: "[ ] So, we equipped ourselves with tablets, rather than with other devices to be able to put them in communication with relatives, and we tried to maintain relationships with family on the phone since we did not have the possibility to see family members personally" (I B )
As evidence of the efforts undertaken in favour of patients, the code "A health care provider replacing a patient’s relative during hospitalisation" emerges: “[ ] Being aware that you are her/his rela tive at that moment was a difficult part You have the face of a patient’s daughter, wife or mother; you have the face of everyone It was something we were proud to do; it made you feel how much you were giving, but it was emotionally devastating" (C.A.).
An effect found by many of the inter viewees was also the "Increase in work loads" and "Nurses’ willingness to perform further activities" : "[...] To guarantee the same number of services we had to extend our shifts" (C S ) "[ ] there was staff reorganisation All of us had to be available for other depart ments” (A T )
The issue in Figure 5, linked to "Health care providers perceptions and emotions" , was widely referred to by all interviewees The section with greater groundness was included under the code "General satisfaction for what has been done" : “[...] I do not feel like giving great judg ments because so much was done by everyone and especially when since mid April everyone started to get sick, we really understood that the impossible was done. Maybe there were some shortco mings at every level, but it was an emer gency, something we really didn't know, something that exploded” (A Z ); “[ ] All in all, we got along quite well with the cardiac patients” (C A )
Unlike to the previous code, nega tive emotions and perceptions also emerged from the care activities related to cardiac patients during the pandemic Proof of this is the code called " Wo r k i n g d i f f i c u l t i e s w i t h advanced PPE" : “[ ] Management is the most complicated aspect obviously From the medical gown to double gloves to do a simple ultrasound; you had to have everything ready to be as autonomous as possible" (C A )
The code called "Operators’ discomfort due to lack of guarantee for family members" :
"[...] The support of patients’ relatives at this moment failed us and it was tough to c o m m u n i c a t e w i t h t h e m o n t h e p h o n e , t o o ; i t w a s r e a l l y u n m a n a g e a b l e s t u f f . T h e s e n t i m e n t a l a s p e c t w a s v e r y p a r t i cular in those patients also because they were patients who, willy nilly, could not b e a l l o w e d t o b e v i s i t e d b y t h e i r r e l a tives" (IB)
And, finally, the code "Initial unpreparedness for COVID" : “[ ] What initially frightened us most of all was the great unknown that this virus could change us and somehow make us less strong and more vulnerable We were afraid of everything” (L M )

The proposed structured interview sought to highlight the experiences of the health care providers we inter viewed and identify any lessons learned by them. Among the ideas represented in figure 6, one of the most interesting was collected in the code "Proposal for the r e o r g a n i s a t i o n o f t e r r i t o r i a l h e a l t h support "
"[ ] If I were at the top of everything, the territorial network would be what I would develop at the top of management" (C A ); "[ ] perhaps creating a stronger territo rial network could help" (A Z )
PPE was also of interest to respon dents, and here it is possible to recognize the presence of the code "Standardise use of PPE" in the future: "[...] The goal is to encourage the presence and correct use of PPE in the room, from dressing to undressing, especially in radio exposed environments" (P.DA.).

From the results, proposals on hospi tals and departments’ adaptation emerged Contributions were identified under the code "Structural adaptation of hospitalisation rooms":
“ [ ] I n m y o p i n i o n , w e h a v e m a i n l y a s t r u c t u r a l p r o b l e m L e t m e g i v e y o u a n e x a m p l e : t h e h o s p i t a l w h e r e I w o r k o p e n e d i n 1 9 6 0 I t w a s d e s i g n e d f o r a n e n v i r o n m e n t o f t h e p a s t , s o t h e r e i s , f o r e x a m p l e , o n l y o n e e n t r a n c e d o o r H o w e v e r , i n t i m e s l i k e t h i s , t h e r e i s a n e e d f o r b u f f e r z o n e s , m a n a g e m e n t o f t h e Ca r d i a c I n t e n s i v e Ca r e U n i t a n d a n o u t l e t f i l t e r t h a t I t h i n k w e ' l l s e e i n h o s p i t a l s i n t h e f u t u r e . U n f o r t u n a t e l y , m o s t o f t h e s t r u c t u r e s i n I t a l y w e r e n o t c r e a t e d t o c o p e w i t h s i m i l a r s i t u a t i o n s . I n m y o p i n i o n , i s o l a t i o n a r e a s w i l l b e r e q u i r e d i n e v e r y w a r d t o p r e v e n t p r o b l e m s , w h e t h e r t h e y a r e d u e t o C OV I D 1 9 o r o t h e r d i s e a s e s t h a t c o u l d a f f e c t u s i n t h e f u t u r e , t h u s b o t h p r e v e n t i n g a n d c o n t a i n i n g v a r i o u s s i t u a t i o n s " ( V R )
In February 29, 2020, 1049 people tested positive for COVID 19 in Italy (8) Today, there are more than 2,925,000 infections and over 97,600 deaths (9)
Based on a phenomenological research project, this study revealed the experiences of health care provi ders in cardiology during the initial phases of the SARS CoV 2 pandemic. The peculiarity of this methodological approach is that it has highlighted diffe rent aspects of the experiences of nurses and technicians of cardiocircula tory pathophysiology and cardiova scular perfusion, otherwise not found with quantitative methodologies Furthermore, the semi structured nature of the interviews ensured the exploration of emerging aspects in a


targeted manner In the word cloud presented in Figure 6, we see the terms most frequently used by the health care providers we interviewed: the centra lity of the patient, the COVID 19 context, and the elements linked to change
Decoding the interview transcripts on the impact of the SARS CoV 2 emer gency revealed a series of sections related to the main actors of this pandemic: health care personnel, patients and hospitals.
Discussion on the environment of health care personnel has allowed the study to identify their activities, perceived emotions and relational aspect with patients and their families. On the other hand, the discussion linked to patients mainly referred to their needs, outcomes, and feelings that they revealed to the interviewed staff
Finally, the organisation was mentioned mainly as the subject of profound and radical transformations, structural and organisational adapta tions and attention related to possible future scenarios
The "organisation" section is clearly one of the most shared among health care providers interviewed The emer gency has brought the need to create new pathways and new facilities and areas dedicated to the management of coronavirus positive patients and ad hoc clinical care pathways for negative or potentially suspicious patients. dedi cated personnel was assigned to manage the triage areas for patient screening, buffer areas for suspected cases, and various isolation areas that had been created This is a practice adopted especially in cardiothoracic surgery procedures (10) This struc
tural adaptation had also affected health care providers who needed clearer and more standardised indications for patient management However, personnel had to wait a long time before the new protocols were validated and adopted Among these, the protocol that most influenced the work organisation within the wards was the ban on entry to patients' families. Participants said they had many difficulties managing patients who, far from their loved ones, felt aban doned and disoriented with a conse quent worsening of conditions, not only clinical but also related to their personal sphere. To ensure communication and continuity of the relationship with fami lies, many departments managed to distribute electronic devices to patients
Some nurses said they had to replace the patient relatives These needs, which emerged from patients, inevitably had emotional repercussions on operators, often masked by PPE, that is, the equip ment that was discussed during the interviews

Difficulties in supplying and using personal protective equipment emerged especially among operators from the areas most affected by the emergency, with particular reference to the initial stages, when requests for material were incompatible with actual availability Many nurses had to cope as best they could, to reduce the risk of contagion among patients and protect themselves from them. Afterwards, hospitals were able to face logistical difficulties and guarantee adequate protection to patients and operators. Some inter viewees reported difficulties in mana ging the most advanced protection devices due to a lack of training and stan dardised usage protocols, so much so that they resorted to online tutorials or suggestions from more experienced
colleagues The manufacturers issued the appropriate indications only at a later stage in this case as well According to the interviewees, there would also be poten tial structural deficiencies in the employ ment departments On the organisational level, the main effect of the emergency was the sudden suspension of the activi ties scheduled under the ordinary regime to make way for positive and acute cases
In the beginning, the outpatient clinics had a positive push in managing chronic cardiac patients. They continued and indeed increased the management of follow ups, effectively avoiding the risk of infections through tele monitoring (11). During the main phase of the pandemic, however, especially in the viral core in northern Italy (12), where the number of hospitalised patients had become unsustainable, hospitals also had to suspend their scheduled outpatient activities to make the most of the few resources available for hospitalisations
Because of this, cardiology departments had to make complex choices regarding emergencies (13) This type of reorgani sation involved most of the hospital structures, including the hubs The latter had to absorb many cardiologic emer gencies that the SPOKE structures would not be able to deal with, as they were committed to the management of COVID 19 patients (14) Nonetheless, with timings unchanged, the new protocols were still able to guarantee urgent inter ventions. In addition, there was a gradual increase in safety measures to protect staff and patients, who underwent regular body temperature checks and nasopharyngeal swabs, regardless of the reason for hospitalisation.
Despite the many logistical and organisational difficulties, one of the proactive elements most represented in the interviews is the remarkable adap
tiveness of our national health service during the emergency Identifying safe paths for the management of cardio logic emergencies, assisting patients with acute coronary syndrome, redu cing the risk of contagion during inva sive procedures, providing dedicated assistance to the patient during and after such procedures were all essential elements that emerged in a general health reorganisation. According to the interviewees, the aspects that most influenced nursing and technical assi stance during cardiologic emergency procedures were mainly two: the execution of screening tests (swab) before or after surgery in the haemody namics room, the use of PPE, and the sanitation processes Both the inter views and the literature (12) show that the revascularisation procedures were not bound to the outcome of the swab; patients were managed as positive regardless, adopting individual protec tion, sanitation and isolation measures until the outcome was known
Although the system has achieved a certain degree safety in the timing and treatment of patients with cardiova scular events, fear of going to the hospital still emerged This, coupled with a general distrust in the national health service, caused health care workers to be seen as smearers and no longer as "heroes", as they were called by the media in the beginning of the pandemic.
The “outcomes” of cardiologic patients can originate from this fear. Many nurses serving in cardiac inten sive care units or emergency rooms said they perceived a sharp decline in both patients and procedures Some describe cases of late heart attacks or heart ruptures, post ischemic compli cations that were not recorded for
Med Mil 2021; 171(2): 109 134
some time, given the efficient health emergency network in the area Many patients came to the hospital already dead from exacerbations, others chose not to report their symptoms for fear of being hospitalised and having to leave their families without certainty of returning home According to some operators, they expected a significant rise in cases of exacerbated heart failure in the future, with a general increase in heart disease, given the uncommunicativeness and fear gene rated by the emergency.
Despite these non reassuring fore casts, the quality of nursing care for the cardiac patient would seem to have improved as the 1:1 nurse patient ratio was favoured by the provisions dictated by the pandemic Without supportive caregivers and with scarce PPE avai lable, nurses had to manage each patient independently and conti nuously to satisfy all their needs and make up for the lack of family members in a sort of patient centred care
The results also reveal diagnostic uncertainty, which affected the mana gement of patients while assessing the risk of contagion, forcing operators to manage all cases relating to the struc tures as positive, pending the results of the swabs carried out in a generalised manner This choice, validated by hospital protocols and necessary for the prevention of virus transmission, affected the nurse patient relationship during assistance, creating a relational void overcome after an initial phase of adaptation thanks to the resourceful ness of health care providers.
However, even on their part, fears and sense of inadequacy emerged Among these feelings, the biggest fear for patients was to become a source of contagion for the loved ones rather
than for themselves Many of them chose to live far from their own fami lies; others waited for their patients' swabs results before leaving, genera ting long and exhausting waits, although necessary to exclude the risk and be able to return to their life The effort of health workers has been impressive in managing the emergency, as widely described in the literature and reported in the Bergamo expe rience of Pope John XXIII (15). Evidence of this is found both in the literature (16) and in the contributions that emerged from the interviewees in the "health care providers" section. Work load increase to ensure efficiency of departments, willingness to fill shifts left uncovered by colleagues who tested positive for COVID 19, support actions for family members who had lost their loved ones, mutual support between colleagues, remote patient manage ment Many issues emerged from the participants Some of these were described with pride, others with melancholy, such as the impotence in the face of negative outcomes of cardiac patients, or the management of the deceased Sadly, many nurses had diffi culty communicating the death to their patients’ families and, above all, for being unable to guarantee dignified rituals towards the deceased and their families. In addition to many others, this aspect is one of the effects of the emergency that the participants asked to change in view of a second pandemic wave.
Finally, thinking about the future, several issues emerged from the study.
On the one hand, participants were sati sfied with the global management of the emergency and rediscovered a strong sense of belonging to their profession
On the other hand, the common desire
was to resolve the critical issues that emerged for developing protocols, defi ning management paths for COVID 19 patients, and standardising screening procedures to protect health care providers No participant wished that the previous phases of the emergency could return They stated that they have the right tools to face a second wave of SARS CoV 2 pandemic and feel ready for that.
Given the excellent results obtained in managing chronic patients, through collaboration with specialists and general practitioners, the participants in the study hope that telemedicine and cardiac patients’ management in hospi tals can improve through planning and participation in the local health care efforts Conclusion
The SARS CoV 2 emergency affected economic, social and cultural activities internationally In Italy, it represented and still represents a challenge for the National Health Service Through the perceptions and experiences of health care providers, the qualitative pheno menological study highlighted new aspects in the clinical care dynamic relating to the quality of service provided to cardiac patients.
The main issues that emerged from the interviews concern the reorganisa tion of the hospital health system, the outcomes and perceptions of cardiac patients, the role of health care provi ders during an emergency and their moods, with an eye to future care proposals
According to the data that emerged from the study, the quality of health care for cardiac patients declined for
Mil 2021; 171(2): 109 134

those patients who were COVID 19 positive In turn, this has put the impor tance of infection prevention and daily hygiene and sanitation protocols in the spotlight Care activities required a greater effort on the part of all health care providers who, due to the increased workloads, suffered physical and emotional repercussions
The management of chronic cardiac patients had excellent results thanks to telemedicine and collaboration with the local health system. In any case, the interventions aimed at managing cardiac emergencies were guaranteed through validated and standardised management paths.
The nurse patient relational aspect was strongly influenced by the emer gency; however, the critical spirit and dedication to one ' s mission were able to shorten the distances dictated by the pandemic
For the future, health care providers hope to strengthen the local health care system, which was discovered as a fundamental pillar of care, and a proac tive hospital organisation review.
In conclusion, the SARS CoV 2 emergency hit us all with a disarming and silent force.
However, hospitals and, more gene rally, the National Health Service responded adequately thanks to the

determination of all operators who, with pride and a sense of belonging, spent themselves for the good of their patients and their loved ones
The Authors declare that they have no relationships relevant to the contents of this paper to Disclose
Manuscript received February 20, 2021; revised February 28, 2021; accepted April 15, 2021
G Med Mil 2021; 171(2): 109 134

Riassunto L’articolo intende indagare, attraverso una revisione narrativa della letteratura, il fenomeno del suicidio all’interno delle Forze Armate. Specificamente è stata eseguita una review della letteratura che ha come obiettivo il mostrare l’evolversi del fenomeno del suicidio all’interno delle Forze Armate negli ultimi cinquant’anni Per raggiungere l’obiettivo dello studio è stata effettuata una ricerca bibliografica attraverso alcune banche dati quali: google scholar, pubmed e proquest Nelle conclusioni viene effettuata una lettura critica dei dati identificati attraverso la revisione della letteratura, inoltre sono anche discussi i contributi teorici che tentano di spiegare l’eziologia e la prevenzione del fenomeno all’interno delle Forze Armate Specificamente, viene presentato un modello integrato interpersonale intersoggettivo che pone al centro del disagio degli arruolati nelle Forze Armate il possibile mancato riconoscimento della propria sofferenza, che può concorrere a generare un senso di “ eccesso ” e isolamento
Parole chiave: Suicidio, Forze Armate, Autolesionismo, Stigma, Prevenzione, Isolamento.

• La revisione narrativa della letteratura ha permesso di osservare come negli ultimi cinquant’anni vi è stato un progressivo aumento del tasso di suicidi all’interno delle Forze Armate italiane che estere
• Il fenomeno dello stigma sulla sofferenza psicologica presente nelle Forze Armate contribuisce alla formazione di un senso di isolamento ed “ eccesso ” che, secondo la teoria interpersonale di Joiner, possono contribuire alla messa in atto di un gesto estremo come il suicidio
Il suicidio rappresenta un evento eclatante che molto spesso raccoglie il clamore della cronaca giornalistica In effetti si tratta di un gesto estremo che rimane impresso nella mente della popo lazione, e in modo particolare nella mente dei familiari del suicida.
Secondo l’Organizzazione Mondiale della Sanità (OMS) nel mondo ogni anno il suicidio causa un milione di morti: ogni giorno all’incirca 2.000 persone perdono
la vita per suicidio Il tasso di mortalità per suicidio nella popolazione mondiale è generalmente di 14,5 su 100 000 abitanti Nei paesi industrializzati il suicidio sembra essere la seconda o la terza causa di morte tra gli adolescenti e i giovani adulti, per tale motivo secondo l’OMS la prevenzione al suicidio assume un’importanza centrale nella sanità pubblica degli ultimi anni.
I fattori che contribuiscono al feno meno del suicidio sono molteplici e multi determinati. Una recente lettera
tura relativa agli studi di suicidologia (1) ha rilevato la presenza di precisi fattori di rischio da tenere in considera zione: 1) fattori di rischio bio psico sociali che comprendono: disturbi mentali, in particolar modo i disturbi dell’umore, schizofrenia, ansia grave e disturbi di personalità, alcolismo e abuso di sostanze, mancanza di speranza nel proprio futuro, tendenze impulsive o aggressive, storia di traumi e abusi, presenza di patologie mediche gravi, precedenti tentativi di suicidio e
* Psicologo specializzando in psicoterapia presso la scuola di specializzazione sper imentale dell’Asl Napoli 1
** Psicoterapeuta e analista junghiano, Vice della Scuola di psicoterapia analitica AION di Bologna; Responsabile nazionale dei Centri ANANAKE Villa Miralago specializzati nella cura dei disturbi del comportamento alimentare, referente regionale SIRIDAP (Società Italiana di Riabilitazione Interdisciplinare Disturbi Alimentari e del Peso); Presidente di PSICOTERAPICAMENTE
Corrispondenza: Email: a raggi@psicoterapicamente it


e s s a n d r o R a g
casi di suicidio in famiglia; 2) fattori di rischio ambientali come: perdita del lavoro o difficoltà finanziare, perdite relazionali e sociali, facile accesso ad armi da fuoco; 3) fattori di rischio socio culturali quali: mancanza di sostegno sociale e senso di isolamento, stigma associato alla necessità di aiuto, ostacoli con l’accedere ad aiuti medici, credenze culturali e religiose, esposizione ad atti di suicidio anche indiretta (attraverso i mass media).
Nessuno dei seguenti fattori di rischio, però, è in grado di spiegare singolarmente il fenomeno del suicidio. Infatti, per la comprensione di un feno meno così complesso, è importante valutare la relazione tra i diversi fattori di rischio Ad esempio, un fattore di rischio ambientale come la perdita del lavoro può portare all’insorgenza di pensieri relativi al suicidio in persone che presentano già una sintomatologia depressiva o un disturbo di persona lità Le caratteristiche psico struttu rali, dunque, sembrano interagire con le cause ambientali nella genesi del fenomeno
Dal punto di vista psicologico, l’atto suicidario può rappresentare la manife stazione di un agito aggressivo auto diretto Un tentativo da parte dell’indi viduo di eleminare una parte del sé considerata “cattiva” Secondo la psicoa nalisi (2) il suicidio tende a rappresen tare un “omicidio mancato”: nei soggetti melanconici l’aggressività inconscia diretta nei confronti dell’oggetto esterno può condurre l’individuo a vivere un senso di colpa nei confronti dell’Io intol lerabile, dove l’unica scappatoia è rappresentata dal suicidio. Diversi studi, (3)(4)(5), hanno osservato dal punto di vista clinico come nei pazienti affetti da depressione, che manifestano un elevato tasso di aggressività espressa o inibita, vi
sia un rischio significativamente maggiore di commettere atti autolesioni stici come il suicidio
Sia la letteratura psicoanalitica che gli studi effettuati in ambito psicopatolo gico sembrano suggerire una relazione tra aggressività, sia etero diretta che auto diretta, e rischio di suicidio
Negli ultimi anni si è cominciato a studiare il fenomeno del suicidio anche all’interno delle Forze Armate, cercando di analizzare l’evoluzione del fenomeno negli ultimi cinquant’anni. Recentemente in una interrogazione parlamentare verso il Ministero della Difesa, è stata posta all’attenzione dei partecipanti l’al larmante aumento dei casi di suicidio all’interno delle Forze Armate: in parti colar modo tra i Carabinieri Un carabi niere o più in generale un militare che si suicida, genera attenzione e clamore, alimentato dalla diffusione da parte dei mass media della notizia, che vede aumentato così il generale senso di allar mismo
In Italia il Ministero della Difesa, a partire dal 2006, con il supporto del Comando di Vertice della Sanità militare Interforze, ha istituito un Osservatorio Permanente sul fenomeno suicidi, che dal 2013 è stato rinominato Osservatorio Epidemiologico della Difesa (OED) Il Ministero della Difesa ha organizzato nel Settembre 2019 una giornata formativa sulla prevenzione del suicidio nelle Forze Armate, dove attraverso i contributi del Comitato Tecnico Scientifico di Psichia tria e Psicologia Militare è stata ribadita l’importanza del monitoraggio del feno meno, poiché attraverso indagini stati stico epidemiologiche è possibile otte nere una fotografia istantanea del feno meno e di comprenderne i possibili fattori di rischio
In accordo con l’Osservatorio Epide miologico della Difesa (OED), messo in
atto dal Governo italiano, il suicidio rappresenta la terza causa di morte all’interno delle Forze Armate, andando a rappresentare un tema di rilievo per la salute delle Forze Armate Secondo Favasuli (1) il fenomeno del suicidio nel comparto Difesa sembra essere posto all’attenzione dei cittadini dai mass media e dalla cronaca Nell’opinione comune il fatto che un soldato o un carabiniere si possa togliere la vita rappresenta un evento scandaloso, che attrae maggiormente l’attenzione rispetto alla manifestazione di gesti autolesivi all’interno della popolazione civile. Nella realtà sembra che la media di suicidi nelle Forze Armate si discosti poco dalla media di suicidi osservati all’interno della popolazione generale Nonostante questa evidenza più gene rale, nel 2003 una relazione sullo stato della disciplina militare e dell’organiz zazione delle Forze Armate presentata in parlamento, ha evidenziato come nello stesso anno ci sia stato un aumento significato dei casi di suicidio in ambito militare
Quindi, sebbene la media degli atti autolesivi all’interno delle Forze Armate sembri essere in linea con la popola zione generale, negli ultimi anni si è assistito a una crescita esponenziale di casi di suicidio in ambito militare, che ha portato molti clinici a indagare il fenomeno, a livello sia nazionale che internazionale.

In linea con le indicazioni del Mini stero della Difesa sulla necessità di moni torare il suicidio nelle Forze Armate, l’obiettivo di questa review è di indagare il fenomeno del suicidio all’interno del comparto negli ultimi 50 anni
Mil 2021; 171(2): 135 150
E‘ stata condotta una revisione narra tiva della letteratura attraverso l’uso di banche dati quali: google scholar, pubmed e proquest, inserendo termini di ricerca come: “suicidio nelle Forze Armate”, “self injury in armed forces” e “psychopa tology and armed forces” La revisione è stata effettuata prendendo in considera zione pubblicazioni nell’intervallo di tempo tra Aprile 2020 e Luglio 2020.

Sono state identificate più di 100 pubblicazioni tra cui solo 10 sono state prese in considerazione poiché consi derate le uniche pertinenti all’obiettivo posto da questa ricerca, 7 di esse sono studi scientifici mentre tre rappresen tano dei report pubblicati dai ministeri della difesa di diversi paesi In partico lare, sono state identificate due pubbli cazioni relative al contesto italiano, tre pubblicazioni relative al contesto inglese, due pubblicazioni relative al contesto statunitense, una pubblica zione relativa al contesto francese, una pubblicazione relativa al contesto cana dese e infine una pubblicazione relativa al contesto israeliano Tutte le pubbli cazioni prese in esame sono state rias sunte nella Tabella 1 (lo studio inglese di Hawton, sebbene sia stato preso in considerazione, non è stato inserito nella tabella riassuntiva poiché descrive tentativi di suicidio e non vere e proprie morti per suicidio). Attra verso studi condotti dall’Osservatorio Epidemiologico della Difesa (OED), Favasulli (1) ha potuto osservare come tra il 2006 e il 2014 in Italia si sono manifestati 155 atti di suicidio tra i membri delle Forze Armate, con media
Tab 1. Tabella riassuntiva con riferimento al periodo, alla nazione e al numero di decessi per suicidio degli studi trovati in letteratura
annuale pari a 20 casi Il 60% dei casi è stato riscontrato all’interno dei Carabi nieri È in ogni caso rilevante notare come il numero di casi sia aumentato di anno in anno: nel 2006 si è riscontrata la presenza di soli 6 casi, mentre nel 2013 si sono manifestati 23 casi.
L’Osservatorio Nazionale dei suicidi all’interno delle Forze dell’ordine, promosso dalla piattaforma online “cerchioblu”, che si occupa di sostegno psicologico nella Polizia Italiana, mostra che dal 2014 al 2019 ci sono stati in Italia 258 casi di suicidio tra le Forze Armate (grafico 1)
Per quanto riguarda invece il tasso di suicidi all’interno delle Forze Armate
estere, l’Osservatorio Nazionale promosso dal Ministero della Difesa inglese ha osservato che dal 2000 al 2019 ci sono stati 309 casi di suicidio L’Osservatorio Nazionale statunitense, invece, promosso dal Ministero della Difesa USA, ha osservato che nel 2018 ci sono stati 541 morti per suicidio tra le Forze Armate.
Per quanto riguarda le ricerche scien tifiche promosse da enti privati, nel 2009 Hawton e colleghi (6) hanno osservato come nelle Forze Armate inglesi, nel periodo che va dal 1989 al 2003, vi siano stati 166 casi di tentato suicidio tra mili tari Anche in questo caso gli autori hanno osservato come col passare degli
Med Mil 2021; 171(2): 135 150

anni i tentativi di suicidio aumentavano in modo significativo: nel periodo che va dal 1999 al 2003 vi è stato un incremento del 40%

Desjeux e colleghi (7) nel loro studio hanno verificato come nel 1998, 40 mili tari delle Forze Armate francesi si siano suicidati, mentre 105 militari hanno messo in atto tentativi di suicidio Gli autori hanno sottolineato come il rischio di suicidio era maggiormente associato a difficoltà relazionali e non alla presenza di specifici disturbi mentali
Un recente studio canadese (8) ha analizzato come nel periodo tra il 1972 e il 2006 vi sia stato un rischio di 1,46 volte maggiore di morte per suicidio tra i vete rani delle Forze Armate canadesi rispetto alla popolazione generale. In questo lasso di tempo i militari morti per suicidio sono stati 930. Nella popolazione mili tare canadese il suicidio rappresenta la seconda causa di morte. Gli autori, inoltre, hanno osservato come nel periodo che va dal 1998 al 2009, ogni anno il 5,8 % dei militari ha rivelato di aver avuto ideazioni suicidarie
Kapur e colleghi (9) hanno invece voluto osservare il tasso di mortalità dei militari inglesi che hanno lasciato le
Forze Armate. Dal loro studio si può osservare che tra i militari che hanno abbandonato le Forze Armate tra il 1996 e il 2005, 224 sono morti per suicidio Secondo un documento del Armed Forces Health Surveillance Center (10) diffuso nel 2012, negli ultimi anni si è registrato un aumento di decessi per suicidio all’interno delle Forze Armate americane In particolar modo, dal 1998 al 2011, 2990 militari americani sono morti a causa di suicidio Per l’AFHSC il suicidio rappresenta la seconda causa di morte all’interno delle Forze Armate, inferiore come numero solo a quello dei militari morti in guerra
Infine, Rotherm e Ben ari (11) hanno osservato come anche all’interno delle Forze Armate israeliane in un anno si siano verificati 34 casi di decesso per suicidio.

Come si può osservare dai dati forniti dalle pubblicazioni identificate il feno meno del suicidio tra i militari è in aumento negli ultimi anni, a livello sia nazionale che internazionale, come
dimostrano le pubblicazioni relative al contesto statunitense, francese, inglese, canadese e israeliano Il fenomeno suici dario all’interno delle Forze Armate rappresenta per il sistema sanitario un tema di primaria importanza
Nella maggior parte degli studi si è osservato che il suicidio rappresenta la seconda causa di morte all’interno delle Forze Armate Sebbene via sia un aumento considerevole anche all’interno delle Forze Armate italiane, il dato più rilevante proviene dagli Stati Uniti, dove il tasso di mortalità per suicidio tra i mili tari è nettamente superiore a tutti i dati riscontrati nei paesi europei. C’è però da dire che il governo statunitense investe molto nelle Forze Armate, presentando un tasso di soldati arruolati nettamente maggiore rispetto a tutti i paesi presenti in Europa
Analisi dei risultati alla luce della letteratura
Come è stato osservato da Favasuli, Rocchetti, Vento e Lastilla (12), in ambito militare, dal punto di vista stati stico, la distribuzione dei suicidi risulta sovrapponibile a quella della popola zione generale Va però considerato che all’interno delle Forze Armate la popola zione tende a essere più selezionata dal punto di vista sanitario e periodica mente controllata Questa potrebbe essere la motivazione della potenziale maggior “copertura” dal rischio di insor genza di alcune patologie rispetto alla popolazione generale: ciò che viene defi nito come “Healthy soldier effect” .
Sebbene la media di suicidi nelle Forze Armate sembri sovrapporsi alla media generale, non va trascurato il problema della salute mentale all’interno del sistema militare Infatti, il fenomeno suicidario ha posto al Ministero della Difesa italiano, e non solo, il problema di
occuparsi maggiormente della salute psicologica dei militari, incentivando l’istituzione di team specifici, ad esempio come il Comitato Tecnico Scientifico di Psichiatria e Psicologia Militare, atti a promuovere campagne di sensibilizza zione sul benessere psicologico Dal punto di vista metodologico può essere errato confrontare la media di due popolazioni con caratteristiche differenti, infatti, come è stato detto in precedenza, la popolazione militare rispetto a quella generale si caratterizza per la presenza dell’ h e a l t h y s o l d i e r e f f e c t , che dal punto di vista statistico può falsare il confronto. Risulta maggiormente fruttuoso, invece, valu tare come il fenomeno suicidario si sia manifestato all’interno delle Forze Armate in uno specifico lasso di tempo, osservando l’andamento del fenomeno nei diversi anni Come si è potuto vedere dai dati raccolti in questo studio, il suicidio, e in generale il disagio psichico, negli ultimi cinquant’anni sembra aver avuto, nel contesto militare, un incre mento, sia a livello nazionale che inter nazionale
In Italia, ad esempio, attraverso gli studi condotti dall’Osservatorio Epide miologico della Difesa (OED), si è potuto osservare che dal 2006 al 2013 vi è stato un aumento considerevole di casi di suicidio, che negli ultimi anni sembra essersi assestato su una media di 40 suicidi all’anno. Un numero che va certa mente preso in considerazione per lo sviluppo di programmi adeguati di prevenzione.
Il suicidio è nella maggior parte delle Forze Armate internazionali la seconda causa di morte, un dato che da solo pone alla salute pubblica una maggior atten zione sul fenomeno e una seria rifles sione sulle modalità con cui è possibile prevenirlo

Il Ministero della Difesa italiano per contrastare il fenomeno del suicidio nelle Forze Armate, nel 2018 ha orga nizzato un tavolo tecnico promosso dal Capo di Stato Maggiore della Difesa in cui sono stati discussi piani di preven zione sia a breve termine che a lungo termine (13)(14) Le analisi condotte dal tavolo tecnico (15) hanno permesso di individuare alcune misure di preven zione a breve termine basate principal mente su campagne pubblicitarie di sensibilizzazione al problema. Sono state realizzate brochure informative sui fattori di rischio del suicidio distri buite a tutto il personale delle Forze Armate, sono stati creati dei team operativi specifici per il contrasto del disagio psicologico e inoltre è stato rafforzato il network sanitario con strutture pubbliche esterne alle Forze Armate
La campagna pubblicitaria di sensibi lizzazione è stata effettuata attraverso l’istituzione di un sito web e di un ’appli cazione per smartphone utilizzati nella prevenzione del disagio psichico Promuovere campagne di informazione permette di ridurre il forte stigma nei confronti del disagio psichico ancora non del tutto scomparso all’interno delle Forze Armate, aumentando le cono scenze relative sui possibili fattori di rischio e sui centri di supporto. L’obiet tivo generale è quello di sviluppare un sistema di protezione e miglioramento del benessere personale del soldato e della sua famiglia, sia dal punto di vista fisico che psichico.
La campagna informativa, effettuata attraverso il sito web e l’applicazione per telefono, non è rivolta esclusiva mente al suicidio, ma ad ogni forma di disagio psichico, incentivando la promo zione di un generale benessere psicolo
gico Infatti, è possibile trovare informa zioni sulla gestione dello stress, sullo sviluppo della resilienza, sull’impor tanza delle relazioni come fattore di protezione
Avvalendosi dell’Osservatorio Epide miologico della Difesa (OED), il Comitato Tecnico Scientifico di Psichiatria e Psico logia Militare, per prevenire e contra stare il fenomeno suicidario, ha intro dotto una scheda di segnalazione in cui sono inserite domande relative ai fattori di rischio per il suicidio identificati dalla letteratura scientifica.
La scheda viene distribuita al perso nale militare in servizio per monitorare e contrastare il fenomeno suicidario. Particolare enfasi viene posta ad uno dei fattori di rischio maggiormente presenti nel contesto militare: il facile accesso ad armi letali L’oggetto “ arma ” riveste un ruolo specifico nella costitu zione dell’identità professionale del militare, per alcune mansioni il possesso dell’arma è a livello identi tario qualificante ed efficiente Il peri colo di ritiro dell’arma per restrizioni professionali dovute a difficoltà psico logiche può far aumentare il tabù sulla salute mentale all’interno delle Forze Armate Perdere l’arma, per molti professionisti militari vuol dire perdere una parte del Sé professionale, indi spensabile nello svolgimento della propria mansione. Una perdita intolle rabile per alcuni, che può mettere in discussione la propria identità di soldato, costringendo l’individuo a una forte umiliazione. Per tali ragioni è indi spensabile favorire campagne di sensi bilizzazione che riducano lo stigma e gli stereotipi ancora presenti nelle Forze Armate La prevenzione passa prima riamente dalla diffusione di informa zioni utili atte a contrastare il disagio psichico in tutte le sue forme
Med Mil 2021; 171(2): 135 150
Aggressività, stigma e pregiudizi come fattori legati al fenomeno del suicidio nelle Forze Armate
Nel paragrafo introduttivo si è affer mato che la presenza di un elevato tasso di aggressività espressa, o inibita, nei pazienti con difficoltà emotiva può rappresentare un fattorie di rischio da tenere in considerazione per la manife stazione di gesti autolesivi come il suicidio. Come ha osservato Favasulli (1) tra le Forze Armate esiste un forte stigma nell’espressione di difficoltà psicolo giche, infatti, molto spesso gli arruolati che vivono un disagio psicologico, come la depressone o uno stato ansioso legato a un eccessivo stress lavorativo, sono costretti a dover nascondere le proprie problematiche col timore di poter essere messi da parte, o persino congedati dal servizio
Nelle Forze Armate è ancora presente il pregiudizio legato alla malattia mentale come handicap insuperabile e inammis sibile: coloro che manifestano tali proble matiche vengono, non di rado, etichettati come deboli, o incapaci di ricoprire il ruolo a loro assegnato Per questi motivi, lo stato di negazione e di scotomizza zione del disagio psicologico può risul tare per un militare protettivo rispetto al mantenimento del ruolo e dello status Questa negazione però non fa altro che aumentare il senso di disagio, dispera zione e rabbia all’interno del soggetto, aumentando così il rischio di compiere un gesto estremo come il suicidio. La mancanza, dovuta allo stigma, di preven zione e trattamento di problemi di natura psichica e relazionale all’interno delle Forze Armate non fa altro che accrescere la percezione di isolamento e sofferenza che può poi portare a tentativi di suicidio
Uno studio italiano (16) ha osservato che le guardie giurate con arma di ordi nanza sono più inclini rispetto alla popo
lazione normale a commettere gesti aggressivi come l’omicidio e il suicidio
La facile reperibilità di armi da fuoco all’interno delle Forze Armate e le diffi coltà nell’espressione e nel trattamento del disagio psicologico, possono portare il militare a commettere un gesto aggres sivo estremo Negli individui con predi sposizione al senso di colpa o a stati depressivi, la rabbia accumulata dall’esi genza di sottacere e nascondere il proprio disagio psichico, può far aumen tare il rischio di mettere in atto tentativi di suicidio.
Diverse sono le fonti stressanti che possono far nascere tra i militari un senso di disagio. Secondo Patterson (17) vi sono quattro grandi stressor nella vita di un militare: 1) eventi stressanti esterni all’organizzazione burocratica dell’istitu zione; 2) eventi stressanti interni connessi alla burocrazia e alle procedure all’interno dell’organizzazione militare (la mancanza di supporto, di un adeguato training, equipaggiamento e/o supervi sione, una bassa paga oppure eventi legati all’organizzazione come la mancanza di comunicazione, inadeguate opportunità di carriera, lavoro in turni e impossibilità di passare ad altre sezioni); 3) eventi stressanti legati alla mansione; 4) eventi stressanti individuali non legati all’ambiente lavorativo
Gli eventi stressanti qui riportati, se non vengono adeguatamente trattati attraverso protocolli di prevenzione, possono far nascere un disagio psichico che può in alcuni casi culminare con tentativi di suicidio, soprattutto quando l’individuo è costretto a dover negare la propria condizione di disagio.
La negazione di un proprio stato del sé da parte di un altro, o di un’istituzione, ha per l’individuo un impatto “trauma tico” poiché esso non si sente ricono sciuto nella propria sofferenza, rima
nendo isolato nel proprio dolore, accre scendo così il senso di disperazione e rabbia che può trasformarsi in un gesto autolesionistico come il suicidio Esclu sione e senso di disperazione per il mancato riconoscimento della propria sofferenza, possono aumentare il rischio di suicidio negli individui appartenenti alle Forze Armate che sperimentano stati depressivi, che spesso l’istituzione non riconosce.
In uno stato di sofferenza non rico nosciuta, infatti, l’individuo può iniziare a dubitare di sé stesso, cadendo in uno stato di sofferenza dovuto al senso di colpa per aver richiesto un legittimo riconoscimento a un proprio disagio, ma che viene interpretato come richiesta eccessiva, non idonea a un membro delle Forze Armate Da un punto di vista inter soggettivo (18) in queste condizioni la soggettività del soggetto sofferente non viene riconosciuta, ma anzi viene etichettata come eccessiva e inadeguata per il ruolo richiesto Quest’eccesso, all’interno dei membri delle Forze Armate, può rivolgersi contro il sé, mettendo in atto tentativi estremi di eliminare quella parte della propria personalità che è deragliata fuori dal “binario” imposto dall’istituzione

Il suicidio può rappresentare una soluzione per poter eliminare quella parte del sé non in linea con la vita mili tare, che è anche fonte di sofferenza e vergogna a causa dello stigma ancora presente.
La teoria interpersonale psicologica del suicidio
Secondo la teoria interpersonale psicologica proposta da Joiner (19) l’atto di compiere un suicidio sarebbe determi nato da tre elementi: un sentimento di burdensomeness, un senso di isolamento e dalla possibilità di mettere in atto il
Mil 2021; 171(2): 135 150
tentativo di suicidio I primi due elementi fanno riferimento al desiderio di commettere un suicidio: infatti essi rappresentano i due elementi cardine nel rischio di ideazione suicidaria
Il sentimento di burdensomeness fa riferimento ad uno stato del sé avvertito come “fardello”: il soggetto si sente un peso per gli altri e per chi gli sta attorno, preferendo la morte alla vita. Molto spesso si accompagna a tale sentimento un senso di isolamento sociale, tale per cui l’individuo non si sente appoggiato dal proprio gruppo di pari e della propria rete familiare. Sebbene entrambi i costrutti presi singolarmente possano essere responsabili di ideazioni suici darie, il rischio di mettere in atto tenta tivi di suicidio cresce incredibilmente quando entrambe le condizioni si mani festano assieme
Secondo J o i n e r (19) questi due elementi però non bastano a mettere in atto un vero e proprio tentativo di suicidio, infatti, spesso si hanno diversi casi in cui queste due condizioni si espli cano attraverso ideazioni suicidarie e non con dei veri e propri tentativi agiti nel concreto Per l’autore affinché un individuo possa mettere in atto un vero e proprio tentativo di suicidio, oltre a sentirsi un “fardello” e isolato, egli deve anche essere capace di commettere un gesto che va, in qualche modo, “contro natura”. Questa capacità di commettere un atto che va contro la spinta pulsio nale alla vita, può essere appressa attra verso una storia di esposizioni a eventi che hanno direttamente, o indiretta mente, esposto il soggetto a tentativi di suicidio. Coloro che acquisiscono la capacità di poter mettere in atto un gesto così atroce sono caratterizzati da un elevata capacità di sopportare stati penosi e una completa assenza di paura nei confronti della morte Esperienze
fortemente violente e traumatiche nella storia individuale possono nel soggetto contribuire alla capacità di poter commettere in seguito un gesto estremo come il suicidio Dal punto di vista psicoanalitico sembra che per poter mettere in atto un suicidio durante la propria esperienza di vita, un individuo deve essere messo davanti a episodi che rompono l’equilibrio tra spinta alla vita e spinta alla morte, con il prevalere di quest’ultima.
Come si è osservato nel paragrafo precedente lo stigma all’interno delle Forze Armate può portare l’individuo a dover negare una parte di sé percepita come in “ eccesso ” , non in linea con le regole imposte dalle Forze Armate, un eccesso che si avvicina molto al concetto di burdensomeness sottolineato dalla teoria interpersonale sul suicidio Il non riconoscimento della propria sofferenza può portare l’individuo a vivere un terri bile senso di solitudine: altro fattore di rischio per il suicidio secondo la teoria interpersonale
Integrando il punto di vista inter personale esposto da Joiner (19) e quello intersoggettivo (18), lo stigma presente nella vita militare legato ai disturbi mentali aumenta il rischio di “ non riconoscimento” negli arruolati dei propri stati di malessere psicolo gico, un mancato riconoscimento che può a sua volta portare a un senso di burdensomeness e di isolamento, che rappresentano due fattori di rischio importanti nella genesi di ideazioni suicidarie. L’esposizione vissuta dagli appartenenti alle forze dell’ordine ad atti violenti e aggressivi può far nascere quella capacità acquisita di mettere in atto tentativi di suicidio descritta da Joiner come terzo elemento fondamentale affinché un individuo si possa suicidare

Dai dati fin qui raccolti emerge chia ramente la necessità di proseguire nel lavoro di monitoraggio costante e perio dico del rischio di suicidio all’interno delle Forze Armate, anche attraverso studi longitudinali Alcuni degli aspetti fin qui sottolineati potranno essere un contributo per le future campagne di prevenzione tra quelle messe già in pianificazione dal Ministero della Difesa. I tre elementi identificati dalla teoria interpersonale di Joiner burden someness, senso di isolamento e capa cità di mettere in atto un suicidio rappresentano seri fattori di rischio che potranno essere presi in considerazione affinché si possano sempre più miglio rare i già funzionali sistemi di supporto presenti nella Difesa La prevenzione può servire affinché si possa contrastare il senso di isolamento e il sentirsi come un “fardello”, un “ eccesso ” , da parte dei militari Il tavolo tecnico promosso, nel 2018, dal Capo di Stato Maggiore della Difesa ha come obiettivo proprio il rico noscimento istituzionale della sfera psichica del militare, combattendo gli stereotipi che promuovono un ’oggetti vazione del militare, ammettendo a quest’ultimo la sua totalità soggettiva composta anche dalle “debolezze” e sofferenze psicologiche che lo stress lavorativo e relazionale può compor tare. Dichiarare in modo esplicito e quindi anche strutturato, che i militari sono in primis dei Soggetti, può permet tere loro di esprimere liberamente i propri stati interni e fare in modo che quest’ultimi non interferiscano in modo negativo con la professione svolta e vissuta
Proseguendo nell’azione di contrasto dello stigma legato alla malattia mentale, può venir meno un fattore che contri
buisce al senso di isolamento e burden someness, equiparando il disagio psico logico a quello fisico, in un ’ottica di salute bio psico sociale
Un esempio è rappresentato dall’as sociazione italiana “cerchioblu” che cerca di promuovere attivamente piani di prevenzione sulla salute mentale dei cittadini appartenenti alle Forze Armate, e dall’Osservatorio Epidemiolo gico della Difesa (OED) che grazie al contributo del Comitato Tecnico Scienti fico di Psichiatria e Psicologia Militare ha promosso diverse campagne di prevenzione.
La review qui presentata ha permesso di osservare come il fenomeno dello stigma e dei pregiudizi sul disagio psichico all’interno delle Forze Armate, rappresenta nonostante gli sforzi effet tuati, un ostacolo verso il riconoscimento di tutte quelle condizioni psicologiche che hanno bisogno di un supporto specia listico Il senso di vergogna e di rabbia associato alle difficoltà nel riuscire a esternare il proprio disagio possono nel militare scatenare un ’escalation di vissuti emotivi che può culminare con un gesto estremo come il suicidio
Il non riconoscimento del proprio stato di malessere, inoltre, può indurre nel militare quello stato di burdensome ness che Joiner assieme al senso di isola mento ha identificato come fattore di rischio per la messa in atto di idee suici dare.
In conclusione, è altresì auspicabile che l’attenzione posta verso il fenomeno suicidario all’interno delle Forze Armate possa essere ulteriormente ampliata anche ad altre forme di disagio psicolo gico: come il caso dei disturbi alimentari, che attualmente sia dal punto di vista epidemiologico che teorico sembrano essere ancora poco studiati nel contesto militare internazionale
1. Favasuli M.A.: Suicidio: Linee di comprensione e di epidemiologia Giornale di Medicina Militare, 2014; 164(2): 165 182.
2 Freud S : Lutto e melanconia In Metapsicologia Torino: Bollati Boringhieri; 1978
3. Yesavage J.A., Brink T.L., Rose T.I., Lum O , Huang V , Adey M , & Leirer V O : Development and validation of a geriatric depression screening scale: a preliminary report Journal of Psychiatric Research,1983; 17(1): 37 49
4 Farmer R : Hostility and deliberate self poisoning: The role of depression The British Journal of Psychiatry, 1987; 150(5): 609 614
5. Weissman M., Fox K., & Klerman G. L.: Hostility and depression associated with suicide attempts The American Journal of Psychiatry, 1973; 130(4): 450 455
6. Hawton K., Harriss L., Casey D., Simkin S , Harrison K , Bray I , & Blatchley N : Self harm in UK armed forces personnel: descriptive and case control study of general hospital presentations The British Journal of Psychiatry, 2009; 194: 266 272.
7 Desjeux G , Lemardeley P , Vallet D , Pascal B , & Labarere J : Données épidémiologiques sur les suicides et tentatives de suicide dans les armées en 1998. Encephale, 2001; 4(27): 320 324.
8 Thompson J M , Heber A , Carrese L , VanTil L , Simkus K , Sareen J , & Pedlar D.: Life course well being framework for suicide prevention in Canadian Armed Forces Veterans. Journal of Military, Veteran and Family Health, 2019; 5(2)
9 Kapur N , While D , Blatchley N , Bray I , & Harrison K.: yhuicide aft 34ë c er leaving the UK Armed Forces A cohort study. Plos Medicine, 2009; 6(3).
10 Armed Forces Health Surveillance Center : Deaths by suicide while on active duty, active and reserve components, U S Armed Forces, 1998 2011 MSMR, 2012; 19(6): 7 10.
11 Rotherm N , & Ben ari E : Mutuality and the study of suicide: Psychological notions on military suicides in Israeli courts The Sociological Review, 2019; 67(6): 1282 1299.
12 Favasuli M A , Rocchetti A , Vento R , & Lastilla M : L’osservazione del fenomeno suicidario in ambito militare Giornale di Medicina Militare, 2019; 169 (3): 197 204
16 Clerici C A , Invernizzi R , Veneroni L , & De Micheli A : Suicidi e omicidi con l’arma di ordinanza Analisi della casistica nelle guardie particolari giurate in Italia Giornale Italiano di Medicina del Lavoro ed Ergonomia, 2009; 31(1): 10 15
17 Patterson G T (2001): The relationship between demographic variables and exposure to traumatic incidents among police officers. The Australasian Journal of Disaster and Trauma Studies, 2001; 2
18 Benjamin J : Il riconoscimento reciproco L’intersoggettività e il Terzo Milano: Raffaello Cortina Editore; 2019
19 Joiner Jr T E : Why people die by suicide Cambridge: Harvard University Press; 2005
13 Ravecca F (2019): La prevenzione del suicidio nelle Forze Armate: Analisi di un programma di intervento http://www.prevenireilsuicidio.it/index. php?option=com content&view=article&i d=172:poster 2019&catid=2:non categorizzato&Itemid=101
14. Murgia F., & Zorzi E. (2019): Dalla prevenzione del suicidio nelle Forze Armate alla promozione del benessere del personale e della sua famiglia http://www prevenireilsuicidio it/ index php?option=com content&view=art icle&id=172:poster 2019&catid=2:non categorizzato&Itemid=101
15 Comitato Tecnico Scientifico di Psichiatria e Psicologia Militare (2019). La prevenzione del suicidio nelle Forze Armate, convegno 25 settembre 2019 https://www difesa it/GiornaleMedicina/ Pagine/La Prevenzione del suicidio nelle Forze Armate aspx
Gli Autori dichiarano nessun conflitto di interessi
Articolo ricevuto il 04 02 2021; rivisto il 26.03.2021; accettato il 27.04.2021.
2021; 171(2): 135 150

Abstract This article intends to investigate, through a narrative review of existing literature, the phenomenon of suicide within the armed forces Specifically, a review of the literature was carried out to show the evolution of the phenomenon of suicide within the armed forces over the last fifty years To achieve the objective of the study, a bibliographic search was carried out through google scholar, pubmed and proquest The conclusions present a critical reading of the data identified through the literature review The theoretical contributions that attempt to explain the etiology and prevention of suicide within the armed forces are also discussed. Specifically, an integrated interper sonal intersubjective model is presented which places the possible lack of recognition of their suffering at the centre of the discomfort of servicepersons, which can contribute to generating a sense of " excess " and isolation
Keywords: suicide, Armed Forces, self harm, stigma, prevention, isolation
Key messages:

• The narrative review of the literature has allowed us to observe how in the last fifty years there has been a progressive increase in the rate of suicides within the Italian Armed Forces, as well as within other countries’ Armed Forces


• The stigma on psychological suffering within the Armed Forces contributes to a sense of isolation and " excess " that, according to Joiner's interpersonal theory, can contribute to such an extreme gesture as suicide.
Suicide is a striking event that very often attracts the attention of the press In fact, it is an extreme gesture that sticks in the mind of the population, and espe cially in the minds of the suicide's family
According to the World Health Orga nisation (WHO), suicide causes one million deaths worldwide every year: around 2,000 people die by suicide every day. The mortality rate for suicide in the world population is generally 14.5 per 100,000 inhabitants. In industrialised
countries, suicide appears to be the second or third most common cause of death among adolescents and young adults, which is why, according to the WHO, suicide prevention has become central to public health in recent years
The factors contributing to the phenomenon of suicide are multiple and multi determined. Recent literature on suicidology studies (1) has revealed the presence of precise risk factors to be taken into account: 1) bio psycho social risk factors that include mental disor ders, especially mood disorders, schi
zophrenia, severe anxiety and persona lity disorders, alcoholism and substance abuse, lack of hope in one ' s own future, impulsive or aggressive tendencies, history of trauma and abuse, presence of serious medical pathologies, previous suicide attempts and cases of suicide in the family; 2) environmental risk factors such as job loss or financial difficulties, interpersonal and social losses, easy access to firearms; 3) sociocultural risk factors such as lack of social support and sense of isolation, stigma associated with the need for help, difficult access to
* Psychologist specializing in psychotherapy at the ASL Napoli 1 exper imental specialization school ** Psychotherapist and Jungian analist, Deputy of the AION School of Analytical Psychotherapy in Bologna, National manager of ANANAKE Villa Miralago centers specialized in the treatment of eating disorders, regional referent SIRIDAO (Italian Society of Interdisciplinary Rehabilitation Eating and Weight Disorders); President of PSYCHOTHERAPY.
Corresponding author: Email: a raggi@psicoterapicamente it

medical help, cultural and religious beliefs, exposure to suicide acts even indirectly (through mass media)
None of the following risk factors, however, can individually explain the phenomenon of suicide In fact, to under stand such a complex phenomenon, it is important to evaluate the relationship between the different risk factors For example, an environmental risk factor such as job loss can lead to the onset of thoughts of suicide in people who already have depressive symptoms or a personality disorder. Psycho structural characteristics, therefore, seem to inte ract with environmental causes in the genesis of the phenomenon.
From the psychological point of view, a suicidal act may represent the manife station of a self directed aggressive act, an attempt by the individual to eliminate a part of the self that is considered 'bad' According to psychoanalysis (2), suicide tends to represent a "missed murder": in melancholic subjects, unconscious aggressiveness towards the external object can lead the individual to expe rience an intolerable sense of guilt towards the Ego, where suicide is the only possible loophole Several studies (3)(4)(5) have observed from a clinical point of view that in patients suffering from depression, who show a high level of expressed or inhibited aggression, there is a significantly higher risk of committing self harming acts such as suicide.
Both psychoanalytic literature and the studies carried out in the psycho pathological field seem to suggest a rela tionship between aggressiveness, both hetero directed and self directed, and the risk of suicide
In recent years, studies have begun to examine the phenomenon of suicide also within the Armed Forces, trying to
analyse the evolution of the phenomenon over the last fifty years In a recent parlia mentary inquiry to the Ministry of Defence, the alarming increase of suicide cases within the Armed Forces, in parti cular among the Carabinieri, was brought to the attention of the participants, A Carabiniere, or more generally a service person who commits suicide, generates attention and clamour, fuelled by the spread of the news by the mass media, which thus increases the general sense of alarmism.
In Italy, since 2006, the Ministry of Defence, with the support of the Joint Health Command (Comando di Vertice della Sanità militare Interforze), has set up a Permanent Observatory on suicide, which was renamed the Defence Epide miological Observatory (Osservatorio Epidemiologico della Difesa OED) in 2013 In September 2019, the Ministry of Defence organised a training day on suicide prevention in the Armed Forces, where the contributions of the Technical Scientific Committee of Military Psychiatry and Psychology highlighted the importance of monitoring the pheno menon In fact, through statistical epide miological surveys it is possible to obtain a snapshot of the phenomenon and to understand its possible risk factors

According to the Defence Epidemio logical Observatory, implemented by the Italian Government, suicide is the third leading cause of death within the Armed Forces and represents a relevant health related issue for the Armed Forces. According to Favasuli (1), it seems that the phenomenon of suicide in the Defence sector is brought to the atten tion of the general public by the mass media and the news Public opinion considers the fact that a soldier or a carabiniere can take his or her own life a scandalous event, which attracts more
attention than self damaging acts within the civilian population As a matter of fact, it seems that the average number of suicides in the Armed Forces differs little from the average number of suicides observed in the general population Despite this more general evidence, in 2003 a report on the state of military discipline and organisation of the Armed Forces, submitted to Parliament, showed that in the same year there had been a significant increase in suicide cases in the military.
Thus, although the average number of self harming acts within the Armed Forces seems to be in line with the general population, in recent years there has been an exponential growth in mili tary suicide cases, which has led many clinicians to investigate the pheno menon, both nationally and internatio nally Objective
Conforming to the Ministry of Defen ce ’ s guidelines on the need to monitor suicide in the Armed Forces, the objec tive of this review is to investigate the phenomenon of suicide within the mili tary over the last 50 years
A narrative review of the literature was conducted using databases such as: google scholar, pubmed and proquest, using search terms such as: "suicide in the armed forces", "self injury in armed forces" and "psychopathology and armed forces" The review was carried out on the basis of publications in the time interval between April 2020 and July 2020
Mil 2021; 171(2): 135 150
Among the 100 publications identi fied, just 10 were actually used, being the only ones relevant to the objective of this research; seven of them are scientific studies and three are reports published by the ministries of defence of different countries In particular, these include: two publications related to the Italian context, three publications related to the English context, two publications related to the US context, one publication related to the French context, one publication related to the Canadian context and finally one publication related to the Israeli context. Table 1 summarises all the publications examined The English study by Hawton, although taken into consideration, has not been included in the summary table because it describes suicide attempts and not actual deaths by suicide Through studies conducted by the Defence Epidemiological Observa tory, Favasulli (1) was able to observe that between 2006 and 2014 in Italy 155 acts of suicide occurred among members of the Armed Forces, with an annual average of 20 cases Sixty per cent of the cases occurred within the Carabinieri However, it is important to note that the number of cases has increased year by year: in 2006 there were only 6 cases, while in 2013 there were 23 cases

The National Observatory on Suicides within the Police Force, promoted by the online platform "cerchioblu", which deals with psycholo gical support in the Italian Police, shows that from 2014 to 2019 there were 258 cases of suicide among the Armed Forces in Italy (Chart 1).

As regards, instead, the suicide rate within foreign Armed Forces, the National Observatory promoted by the British Ministry of Defence observed that
Table 1. Overview of existing literature regarding period, nation, and number of deaths by suicide
Chart 1 Number of suicide cases within the Italian Armed Forces from 2014 to 2020

from 2000 to 2019 there were 309 cases of suicide The US National Observatory, on the other hand, promoted by the US Department of Defence, noted that in 2018 there were 541 deaths by suicide within the Armed Forces
As to scientific research promoted by private bodies, in 2009 Hawton and collea gues (6) observed that in the British Armed Forces, in the period between 1989 and 2003, there were 166 cases of attempted suicide among servicemembers. In this case, too, the authors observed that suicide attempts increased significantly over the years: in the period from 1999 to 2003, there was an increase of 40%.
Desjeux and colleagues (7) verified that in 1998, 40 soldiers of the French Armed Forces committed suicide, while 105 servicepersons made suicide attempts The authors pointed out that the risk of suicide was associated with interpersonal difficulties and not with the presence of specific mental disorders
A recent Canadian study (8) analysed how in the period between 1972 and 2006 there was a 1 46 times higher risk of death by suicide among veterans of the Canadian Armed Forces compared to the general population During this period, 930 military personnel died by suicide In the Canadian military population, suicide is the second leading cause of death The authors also noted that between 1998 and 2009, 5.8% of military personnel revealed suicidal ideation each year.
Kapur and colleagues (9), on the other hand, wanted to observe the mortality rate of British military personnel who had left the Armed Forces. Their study shows that 224 soldiers who left the armed forces between 1996 and 2005 died by suicide
According to a document by the Armed Forces Health Surveillance Center (10) published in 2012, there has been an

increase in the number of deaths by suicide within the US Armed Forces in recent years Specifically, from 1998 to 2011, 2990 US military personnel died by suicide According to the AFHSC (Armed Forces Health Surveillance Center), suicide is the second leading cause of death in the armed forces, lower only than the number of military fatalities in war
Finally, Rotherm and Ben ari (11) observed that also within the Israeli Armed Forces, 34 cases of death by suicide occurred in one year.
in the military and in the general popula tion are superimposable However, one should note that within the Armed Forces the population is generally more care fully selected in terms of health and undergoes regular medical check ups This could explain the potential larger protection against the risk of onset of some pathologies compared to the general population: what is defined as the "healthy soldier effect".
The data provided in these publica tions shows that the phenomenon of suicide among military personnel has been increasing in recent years, both at the national and international level as demonstrated by the US, French, UK, Canadian and Israeli publications Suicide in the Armed Forces is a major issue for the health system
Most studies show that suicide is the second most common cause of death in the armed forces Although there has been a considerable increase also within the Italian Armed Forces, the most rele vant data comes from the United States, where the mortality rate for suicide among military personnel is much higher than in any European country. However, it should be noted that the US govern ment invests considerably in the Armed Forces, which in fact comprise a much higher number of servicepersons than any other country in Europe.
As observed by Favasuli, Rocchetti, Vento and Lastilla (12), from a statistical point of view, the distribution of suicides
Although the average number of suicides in the Armed Forces seems to overlap with the general average, the problem of mental health within the mili tary system should not be overlooked. In fact, the suicide phenomenon has posed an issue for, yet nor exclusively, the Italian Ministry of Defence, as regards dealing more with the psychological health of the military, encouraging the establishment of specific teams such as the Technical Scientific Committee of Psychiatry and Military Psychology to promote awareness rising campaigns for psychological well being
From a methodological point of view, it may be wrong to compare the average of two populations with diffe rent characteristics, because, as previously mentioned, in comparison with the general population, the mili tary population is characterised by the healthy soldier effect, which can distort the comparison in statistical terms. It is more fruitful, instead, to assess how the suicide phenomenon occurred within the Armed Forces during a specific period, observing the trend of the phenomenon in the different years. As shown by the data collected in this study, suicide, and in general psycholo gical distress, seems to have increased in the military context over the last fifty years, at both the national and interna tional level
In Italy, for example, through studies conducted by the Defence Epidemiological Observatory, it has been observed that from 2006 to 2013 there has been a consi derable increase in suicide cases, which in recent years seem to have settled at an average of 40 suicides per year This is a number that should certainly be taken into account in developing appropriate prevention programmes.
Suicide is the second most common cause of death in the international Armed Forces, a fact that alone calls for greater public health attention to the pheno menon and serious reflection on how it can be prevented.
In 2018, the Italian Ministry of Defence, in order to counter the pheno menon of suicide in the Armed Forces, organised a technical round table promoted by the Chief of Defence Staff where both short term and long term prevention plans were discussed (13)(14) The analyses conducted by the technical round table (15) made it possible to identify some short term prevention measures based mainly on advertising campaigns to raise aware ness of the problem Information brochures on suicide risk factors have been made and distributed to all Armed Forces personnel Specific operational teams have been created to combat psychological distress and the health network with public structures outside the Armed Forces has been strengthened.

The awareness rising campaign was carried out by creating a website and an application for smartphones used in the prevention of psychological distress. Promoting information campaigns allows to reduce the strong stigma on psychic distress which has not yet completely disappeared within the
Armed Forces by increasing knowledge of possible risk factors and support centres The overall objective is to develop a system to protect and improve the personal well being of servicemem bers and their families, in both physical and psychological terms
The information campaign, carried out through the website and the telephone application, is not only aimed at suicide, but at all forms of psycholo gical distress, encouraging the promo tion of general psychological well being. Therefore, it is possible to find informa tion on stress management, on resilience development, and on the importance of relationships as a protective factor.
With the help of the Defence Epide miological Observatory and in order to prevent and combat suicide, the Tech nical Scientific Committee of Military Psychiatry and Psychology has intro duced a report card with questions on suicide risk factors identified in the scientific literature
The form is distributed to serving military personnel to monitor and coun teract suicide Particular emphasis is placed on one of the most important risk factors in the military context: easy access to lethal weapons The object " weapon " plays a specific role in the development of a servicemember’s professional identity; for some tasks possessing a weapon is a qualifying and efficiency factor in terms of identity. The danger of having one ’ s weapon with drawn due to professional restrictions caused by psychological difficulties may increase the taboo on mental health within the Armed Forces. For many mili tary professionals, losing their weapon means losing a part of their professional self, which is indispensable in carrying out their duties To some of them, this is an intolerable loss that can call into
question their identity as soldiers, forcing them to suffer severe humiliation
For these reasons, it is essential to promote awareness raising campaigns that reduce the stigma and stereotypes still present in the Armed Forces Preven tion is primarily based on the dissemina tion of useful information to combat psychological distress in all its forms
As explained in the introductory paragraph, the presence of a high level of expressed or inhibited aggression in patients with emotional difficulties can represent a risk factor to be taken into account for the manifestation of self harming acts such as suicide As Favasulli (1) observed, among the Armed Forces the stigma attached to the expression of psychological difficulties is strong In fact, very often enlisted personnel who experience psychological discomfort, such as depression or a state of anxiety linked to excessive work stress, are forced to hide their problems for fear of being sidelined, or even discharged from service
In the Armed Forces, there is still a prejudice against mental illness as an insuperable and inadmissible handicap: those with such problems are often labelled as weak or unable to fulfil their assigned role. For these reasons, the state of denial and scotomisation of psycholo gical discomfort can be a way for a servi cemember to protect their own role and status. This denial, however, only increases the sense of unease, despair, and anger within the subject, thus increa sing the risk of an extreme gesture such as suicide The lack, due to stigma, of prevention and treatment of psycholo gical and interpersonal problems within
Med Mil 2021; 171(2): 135 150
the Armed Forces only increases the perception of isolation and suffering which can then lead to suicide attempts
An Italian study (16) has observed that security guards with service weapons are more prone than the normal population to commit aggressive acts such as homicide and suicide The easy availability of firearms within the Armed Forces and the difficulties in expressing and treating psychological distress can lead a serviceperson to commit an extreme aggressive gesture. In individuals with a predisposition to guilt or depression, the anger accumu lated due the need to conceal and hide their psychological distress can increase the risk of suicide attempts
There are various stressful factors that can give rise to a sense of unease among servicepersons According to Patterson (17) there are four major stressors in the life of a serviceperson: 1) stressful events external to the bureau cratic organisation of the institution; 2) internal stressful events related to the bureaucracy and procedures within the military organisation (lack of support, of adequate training, equipment and/or supervision, low pay or organisational events such as lack of communication, inadequate career opportunities, shift work and inability to transfer to other sections); 3) job related stressful events; 4) individual stressful events not related to the work environment.
If not adequately treated through prevention protocols, these stressful events can lead to psychological distress that may in some cases culminate in suicide attempts, especially when the individual is forced to deny their own distressful condition
The denial of their own state of the self by another, or by an institution, has a 'traumatic' impact on the individual
because they do not feel recognised in their suffering, remaining isolated in their pain, thus increasing the sense of despair and anger that can turn into a self damaging act such as suicide Exclu sion and despair due to the lack of reco gnition of one ' s own suffering can increase the risk of suicide in Armed Forces personnel who experience depressive states, which are often not recognised by the institution.
In fact, in a state of unacknowledged suffering, the individual may begin to doubt themselves, falling into a state of suffering due to a sense of guilt for having requested the legitimate acknow ledgement of their own discomfort, which is interpreted instead as an exces sive request, unsuitable for a member of the Armed Forces From an intersubjec tive point of view (18), in these condi tions the subjectivity of the suffering subject is not recognised but rather labelled as excessive and unsuitable for the requested role This excess, within the members of the Armed Forces, can turn against the self, and translate into extreme attempts to eliminate that part of one ' s personality which has derailed outside the "track" imposed by the insti tution
Suicide can be a solution to eliminate that part of the self that is not consistent with military life, which is also a source of suffering and shame because of the stigma still existing.
The interpersonal psychological theory of suicide
According to the interpersonal psychological theory proposed by Joiner (19), the act of committing suicide is determined by three elements: a feeling of burdensomeness, a sense of isolation and the possibility of carrying out the suicide attempt The first two elements
refer to the desire to commit suicide: in fact, they represent the two pivotal elements in the risk of suicidal ideation

The feeling of burdensomeness refers to a state of the self that is perceived as a "burden": the subject feels to be a burden to others and to those around himself or herself, preferring death to life Very often, this feeling is accompanied by a sense of social isola tion, whereby one does not feel supported by one ’ s peer group and family network. Although both constructs taken individually can be responsible for suicidal ideation, the risk of suicide attempts increases dramati cally when both conditions occur together
According to Joiner (19), however, these two elements are not sufficient to carry out a real suicide attempt In fact, often these two conditions translate into suicidal ideations and not actual attempts made in practice For the author, in order for an individual to make a real suicide attempt, in addition to feeling a 'burden' and isolated, he or she must also be capable of committing an act that is somehow, 'against nature' This capacity to commit an act that goes against the drive to live can be learned through a history of exposure to events that have directly, or indirectly, exposed the subject to suicide attempts Those who acquire the capacity to carry out such an atrocious act have a strong ability to endure painful states and completely lack fear of death. Strongly violent and traumatic experiences in the individual's history can contribute to the ability to commit an extreme act such as suicide. From a psychoanalytic point of view, it seems that in order to be able to commit suicide during their life expe rience, an individual must be confronted with episodes that break the balance
Mil 2021; 171(2): 135 150
between the drive for life and the drive for death, with the latter prevailing
As noted in the previous paragraph, the stigma within the Armed Forces can lead the individual to deny a part of themselves perceived as in " excess " , not in line with the rules imposed by the Armed Forces, an excess that is remarkably close to the concept of burdensomeness underlined by the interpersonal theory on suicide. The non recognition of their own suffering can lead the individual to experience a terrible sense of loneliness: another risk factor for suicide according to the inter personal theory.
In integrating the interpersonal point of view presented by Joiner (19) and the intersubjective one (18), the stigma atta ched to mental disorders within the mili tary community increases the risk for servicemembers of " non recognition" of their own states of psychological discomfort This non recognition can in turn lead to a sense of burdensomeness and isolation, which represent two important risk factors in the genesis of suicidal ideations The exposure of law enforcement officers to violent and aggressive acts can give rise to the acquired capacity to make suicide attempts, described by Joiner as the third fundamental element for an individual to commit suicide
Conclusions
The data collected so far clearly show the need to continue the constant and periodic monitoring of suicide risk within the Armed Forces, also through longitudinal studies Some of the aspects highlighted so far could consti tute a contribution to future prevention campaigns among those already
planned by the Ministry of Defence The three elements identified by Joiner's interpersonal theory burdensomeness, sense of isolation and the ability to commit suicide represent serious risk factors that can be taken into account in order to improve the effective support systems already in place within Defence Prevention can help counter the sense of isolation and the feeling of being a 'burden', an ' excess ' , on the part of the military. The technical round table promoted, in 2018, by the Chief of Defence Staff aimed precisely at the institutional recognition of the service person ' s psychological sphere, comba ting stereotypes that promote an objec tification of the military, acknowledging their subjective totality as also compri sing the "weaknesses" and psycholo gical suffering that work and interper sonal stress can entail Declaring expli citly, and therefore also in a structured way, that servicepersons are first and foremost Subjects, can allow them to freely express their inner states and ensure that these do not interfere nega tively with the profession they carry out and experience
By continuing to combat the stigma attached to mental illness, a factor contri buting to the sense of isolation and burdensomeness can be eliminated, thus equating psychological distress with physical distress, in a bio psycho social health perspective.
An example of this is the Italian asso ciation "cerchioblu", which seeks to acti vely promote prevention plans on mental health for citizens belonging to the Armed Forces, as well as the Defence Epidemiological Observatory which, thanks to the contribution of the Tech nical Scientific Committee of Military Psychiatry and Psychology, has promoted several prevention campaigns

The review presented here has made it possible to observe how the pheno menon of stigma and prejudice regarding psychological distress within the Armed Forces represents, despite the efforts made, an obstacle towards the recogni tion of all those psychological conditions that need specialist support The sense of shame and anger associated with the difficulty in expressing one ' s discomfort can trigger an escalation of emotional experiences in servicemembers, which can culminate in an extreme gesture such as suicide.
Moreover, the non recognition of one ' s own discomfort can lead to the burdensomeness that Joiner has identi fied, together with a sense of isolation, as a risk factor for suicidal ideation
In conclusion, one can only hope that the attention paid to the pheno menon of suicide within the Armed Forces can be further extended to other forms of psychological distress such as, for instance, eating disorders, which still seem to be scarcely studied in the international military context both from an epidemiological and theoretical point of view
The Authors declare that they have no relationships relevant to the contents of this paper to Disclose
Manuscript received April 04, 2021; revised March 26, 2021; accepted April 27, 2021

R i a s s u n t o La presente analisi è volta a valorizzare gli effetti positivi della precoce somministrazione di ossigeno iperbarico nel trauma muscolo tendineo occorso a un militare palombaro appartenente al Gruppo Operativo Subacquei della Marina Militare Italiana Le lesioni traumatiche delle estremità che causano l'ischemia dei tessuti sono note per condividere una comune fisiopatologia dinamica Nella medicina iperbarica tali lesioni rientrano in un gruppo di patologie note come ischemie periferiche acute traumatiche (ATPI) In queste patologie, accanto alla zona della lesione primaria si sviluppa un ’ area di lesione “secondaria” caratterizzata da: 1) la triade: ischemia tissutale, ipossia ed edema; 2) un gradiente di lesione tissutale; 3) la capacità della lesione di perpetuarsi da sola L’OTI (Ossigeno terapia iperbarica) svolge un ruolo di fondamentale importanza nel contrastare l’instaurarsi e il propagarsi della lesione secondaria
Parole chiave: ossigenoterapia iperbarica, trauma muscolo tendineo, ischemia tissutale, ipossia, edema, crush syndrome.

• Le lesioni muscolari traumatiche innescano la triade patologica: ischemia tissutale, ipossia, edema La triade patologica tende ad esten dersi coinvolgendo aree di lesione secondarie
• Se non si interviene nel bloccare la progressione del danno, questo si autoalimenterà ampliando notevolmente l’area di tessuto coinvolto
• La precoce somministrazione di ossigeno iperbarico ha effetti positivi sia nell’interrompere la propagazione dell’area di sofferenza tissu tale, sia nel favorire una più rapida guarigione della lesione.
Il meccanismo patogenetico della lesione secondaria di origine traumatica costituisce il razionale in base al quale può essere utile la somministrazione di ossigeno iperbarico(1). La fisiopatologia della lesione secondaria consta di 3 processi tra loro connessi:
1. Ischemia: la diminuita perfusione sanguigna ai tessuti danneggiati costi
tuisce l’evento scatenante che porta all’instaurarsi delle lesioni secondarie L'ischemia può derivare da trauma diretto, con lesione dei vasi sanguigni e del microcircolo, o indiretto, da perdita di liquidi (edema, emorragia), vasocostrizione, stasi, occlusione.
2. I p o s s i a : I processi cellulari coin volti nella riparazione della ferita dipendono fortemente dall'ossi geno. La zona di tessuto danneg
* T.V. (SAN) M.S.I. Capo Sezione Assistenza Camere Iperbariche COMSUBIN.

* C.F. (SAN) M.S.I. Ufficiale Medico specialista in Ortopedia e Traumatologia.

giato e quindi sofferente, presen terà una richiesta di ossigeno molto superiore al normale Tra l’altro in condizioni di ipossia vengono ad essere compromessi i meccanismi di riparazione delle ferite, l’attività dei fibroblasti e la formazione di collagene. Le difese immunitarie si abbassano, la cellule ipossiche non riescono a trattenere l’acqua intra cellulare (edema citogenetico).
° C F (SAN) M S I Ufficiale Medico specialista in Cardiologia, Capo Servizio Sanitario Comsubin Corrispondenza: Email: gualtiero meloni@marina difesa it
G Med Mil 2021; 171(2): 151 158
3 Edema: L'edema contribuisce profon damente ad aggravare l'ipossia tissu tale: quando il liquido si accumula all'interno dello spazio extracellulare, la distanza dalla parete capillare alla cellula danneggiata è maggiore: pertanto, meno ossigeno raggiungerà la cellula danneggiata Inoltre la vaso dilatazione del sistema vascolare arterioso prossimale aumenta il flusso sanguigno al sito della lesione. Questo riflesso provoca a sua volta edema di origine vascolare.
Se non si interviene a bloccare questa triade, il meccanismo del danno provo cato da ischemia, ipossia ed edema, si autoalimenterà ampliando notevolmente l’area di tessuto coinvolto nella lesione secondaria (Fig 1) In questo contesto rientra la somministrazione di ossigeno iperbarico che ha lo scopo di rallentare il processo degenerativo cellulare, velociz zare la guarigione delle ferite per un più rapido recupero dalla malattia ed infine contrastare la formazione e l’amplia mento dell’area di lesione secondaria (2,3,4,5)
Da questo assunto appare verosimile estendere il campo di applicazione dell’OTI anche a traumi muscolo tendinei non direttamente ischemici2, ma che a livello microscopico causino l’instaurarsi della citata triade: ischemia, ipossia, edema, e che vedano coinvolto il microcircolo
La somministrazione dell'ossigeno iperbarico risulta maggiormente efficace quanto più precocemente è iniziata, auspicabilmente entro le 12 ore dal trauma(6,7). In particolare risulta utile non superare le 24 ore dal trauma, il tutto nell’intento di ritardare o annullare il circolo vizioso che si instaura tra danno tissutale, ischemia ed edema che a sua volta causa ipossia e conseguente propa gazione della sofferenza cellulare ai tessuti delle zone contigue alla lesione

Fig. 1 zone di tessuto danneggiato relative alla contusione e propagazione del danno secondario

Si è preso in esame un militare palombaro appartenente al Gruppo Operativo Subacquei di COMSUBIN che durante un addestramento ha riportato un trauma contusivo distrattivo del ventre muscolare del bicipite brachiale. Il militare durante l’effettuazione di un aviolancio con fune di vincolo, al momento di uscire dalla carlinga dell’aereo ha subito un urto da sfrega mento con la fune di vincolo stessa che ha urtato sul braccio destro all’altezza del bicipite brachiale. Una volta a terra, il militare ha ricevuto le prime cure dall’as sistenza sanitaria presente sul posto È stato successivamente trasportato al pronto soccorso civile dell’Ospedale “San
Bartolomeo” di Sarzana da cui è stato dimesso in serata con la seguente diagnosi: “Trauma del braccio destro con lesione del bicipite brachiale e vasto ematoma” e prognosi di 15 gg s c La mattina successiva il militare è stato convocato presso l’infermeria di COMSUBIN per essere visitato. Qui giunto, dopo essere stato accuratamente visitato, è stato trattato con 3 cicli di ossi geno terapia iperbarica.
Sintomatologia riferita: intenso dolore al braccio destro in corrispon denza di tutto il bicipite brachiale con interessamento prossimale dei muscoli grande e piccolo pettorale Notevole limitazione funzionale dell’arto con escursione inferiore a un terzo del movimento totale
Dati anamnestici: paziente in appa rente buona salute, non fumatore, spor tivo, abituato all’iperbarismo in quanto atmosfera strettamente correlata con la sua mansione di palombaro Anamnesi patologica remota e prossima negative
Esame obiettivo: Arto superiore dx edematoso ecchimotico con escoriazioni cutanee nella faccia interna del braccio (Fig. 2), dolente alla digito pressione sul decorso dell’inserzione laterale dei muscoli pettorali, sul decorso del capo breve del bicipite brachiale e sulla metà del ventre muscolare, articolarità passiva completa della spalla dolente ai movi menti di extra rotazione, impotenza funzionale di flessione del avambraccio sul braccio, e di elevazione in anteposi zione del braccio, riferite lievi parestesie e disestesie dell’avambraccio e della mano
Valutazione diagnostica: a seguito di anamnesi, esame obiettivo ed ecografia muscolo scheletrica arto interessato che evidenziava “ in presenza di interru zione della continuità delle fibre musco lari, esteso ematoma nel contesto del m bicipite dell’estensione di circa 10 cm con uno spessore di circa 2 5 cm ” veniva formulata la seguente diagnosi “trauma contusivo distrattivo ventre muscolare bicipite brachiale”
Trattamenti terapeutici: considerato lo stato di buona salute del militare inte ressato, nonché la sua appartenenza al Gruppo Operativo Subacquei con la qualifica di palombaro ed il conseguente stato di allenamento fisico, la naturale confidenza con le atmosfere iperbariche nonché la buona tolleranza alla respira zione di ossigeno iperbarico, è stato deciso di sottoporlo ai seguenti cicli di OTI come da SMM/IS/UEU 138: “Manuale di medicina subacquea ed iper barica per Ufficiali Medici” ed 2015(8): 2 SEDUTE DI ATTACCO: TAB 15/90 (15

Fig. 2 Braccio dx prima del trattamento.
Fin dalla prima seduta di OTI è stato riscontrato un netto miglioramento sia dal punto di vista clinico, con riduzione della sintomatologia algica unitamente al progressivo recupero dell’escursione dell’arto superiore, sia dal punto di vista obiettivo con riduzione ecografica del versamento e conseguente diminuzione del diametro bicipitale.
Dopo il terzo trattamento lo spettro di movimento dell’arto superiore è passato complessivamente da meno di un terzo a oltre la metà permettendo di riclassificare il trauma contusivo da Grado III a Grado I. Inoltre il diametro bicipitale si è ridotto da 37 5 cm a 35 cm (Figg 3,4)

metri /90 min con pausa ad aria ogni 20 min), TAB 15/75 (15 metri/75 min con pausa ad aria ogni 20 min) nella stessa giornata
1 SEDUTA DI CONSOLIDAMENTO: TAB 15/90 (15 metri /90 min con pausa ad aria ogni 20 min) il giorno seguente
I risultati osservati alla fine dei tratta menti sono stati i seguenti:
• Miglioramento sintomatologico
• Aumento R O M (range of motion) arto interessato
• Miglioramento Grading lesione muscolare contusiva: da grado 3 a grado 1


Fig. 3 Diametro bicipitale prima del trattamento: 37.5 cm.
Fig. 4 Diametro bicipitale dopo 3° trattamento OTI: 35 cm
• Riduzione complessiva 1 5 cm diametro bicipitale (riduzione edema/ematoma)

Si è deciso pertanto di non effettuare ulteriori somministrazioni di OTI racco mandando al militare il riposo e l’asten sione dalla movimentazione manuale dei carichi per 15 giorni s c
L’ossigeno terapia iperbarica potrebbe rientrare a pieno titolo nell’ap proccio del trattamento dei traumi muscolo tendinei a partire da quelli contusivi distrattivi di 3°grado descritti nella classificazione succitata di Reid, in quanto svolge un ruolo importante e determinante sia nell’interrompere la propagazione della sofferenza tissutale, se somministrato nelle 24 ore, sia nel favorire la precoce guarigione della lesione
1. Mark F. Buettner, DO, ABEM, Derek Wolkenhauer, RRT, CHT Hyperbaric Oxygen Therapy in the treatment of Open Fractures and Crush Injuries
2. Longobardi P.: Ossigeno Terapia Iperbarica” Capitolo “Introduzione e Principi Fisiologici Edizione 1994 tipolitografia Scaletta.
3. Sullivan S.M., Johnson P.C.: Effect of oxygen on blood flow autoregulation in cat Sartorius muscle Am J Physiol , 24, H807 H815,1981 S
4. Shieffield P.J.: Tissue oxygen measurements In: Davis J C , HuntT K Problem Wound: the role of oxygen pp 17 51, Elsevier, New York, 1988
5. Ehrlich H.P., Grislis G., Hunt T.K.: Metabolic and circulatory contributions to oxygen gradients in wounds Surgery 72, 578 583,1972
6. Kivisaari J., Vihersaari T., Renvall S. et all : Energy metabolism of experimental wounds at various oxygen environements Ann Surg , 181, 823 827,1975
7 Hunt T K , Niinikoski J , Zederfeldt B H , Silver I A : Oxygen in wound healing enhancement: cellular effects of oxygen. In: Davis J C , Hunt T K Hyperbaric Oxygen Therapy pp 111 122 Undersea Maedical Society, Bethesda, 1977
8 SMM/IS/UEU 138: Manuale di medicina subacquea ed iperbarica per Ufficiali Medici Ed 2015
Gli Autori dichiarano nessun conflitto di interessi.
Articolo ricevuto il 15 09 2020; rivisto il 11 01 2021; accettato il 21 04 2021
2021; 171(2): 151 158
Ab s t r a ct This analysis aims to highlight the positive effects of the early administration of hyperbaric oxygen in a muscle tendon trauma that occurred to a military diver of the Italian Navy’s Underwater Operational Group. Limbs’ traumatic injuries causing tissue ischemia are known to share the same dynamic pathophysiology In hyperbaric medicine, these injuries fall into a group of diseases known as Acute Trau matic Peripheral Ischemia (ATPI) In these pathologies, a “secondary” lesion area develops next to a primary lesion area characterized by: 1) the triad: tissue ischemia, hypoxia and oedema; 2) a tissue injury gradient; 3) the ability of the lesion to perpetuate itself The HBOT (Hyper baric Oxygen Therapy) plays a fundamental role in countering the formation and spread of a secondary lesion
Keywords: hyperbaric oxygen therapy, muscle tendon trauma, tissue ischemia, hypoxia, oedema, crush syndrome.
Key messages:
• Traumatic muscle injuries trigger a pathological triad: tissue ischemia, hypoxia, oedema The pathological triad tends to enlarge involving secondary lesion areas
• If no action is taken to stop the progression of tissue damage, the area involved will expand considerably in a self feeding process
• The early administration of hyperbaric oxygen has positive effects in stopping the propagation of suffering tissue and promoting faster healing of a lesion.
The pathogenetic mechanism of the secondary injury of traumatic origin constitutes the rationale based on which the administration of hyperbaric oxygen may be useful(1) The pathophysiology of the secondary lesion consists of 3 inter related processes:
1. Ischemia: a decreased blood perfu sion to damaged tissues is the trigge ring event that leads to the onset of secondary lesions. Ischemia can result from either direct trauma, that cause
damage to blood vessels and microcir culation, or indirect trauma, from loss of fluids (oedema, haemorrhage), vasoconstriction, stasis, occlusion
2 Hypoxia: the cellular process involved in reparation of the wounds is highly dependent on oxygen The injured area, and therefore the suffe ring tissues, will have a much higher oxygen demand than normal. In addi tion, in hypoxic conditions, fibro blasts activity, wound repair mecha nisms, and collagen formation may be compromised. Moreover, the immune
system is weakened, and hypoxic cells are unable to retain intracellular water (cytogenetic oedema)
3 Oedema: oedema contributes deeply to aggravate tissue hypoxia: when fluid accumulates within the extracellular space, the distance from the capillary wall to the damaged cell is greater: therefore, less oxygen will reach the damaged cell. Additionally, vasodila tion of the proximal arterial vascular system increases blood flow to the injury site. This response, in turn, causes oedema of vascular origin.
* Lt., MD Diving and Hyperbaric Medicine Head, Hyperbaric Chambers Assistance Section, “Teseo Tesei” Scuba Raiders Group.
* Cdr., MD Diving and Hyperbaric Medicine Specialist in Ortho & Trauma.
° Cdr , MD Diving and Hyperbaric Medicine Head, Medical Service, “Teseo Tesei” Scuba Raiders Group, Specialist in Cardiology
Corresponding author: Cdr Gualtiero Meloni, MD Email: gualtiero meloni@marina difesa it
G Med Mil 2021; 171(2): 151 158


1 5 5 1 5 5

Suppose action is not taken to stop this triad In that case, the damage mechanism caused by ischemia, hypoxia, and oedema will feed on itself, conside rably expanding the tissue area involved in a secondary lesion (Fig. 1) This scenario may require the administration of hyperbaric oxygen, which slows down cellular degenerative process, quickens wound healing, and finally counteracts the creation and enlargement of a secon dary lesion area(2,3,4,5).
From this assumption, it seems logical to extend the field of HBOT appli cation to also not ischemic(2) muscle tendon trauma, which, at a microscopic level, may cause the triad mentioned above: ischemia, hypoxia, oedema, as well as involving microcirculation
The administration of hyperbaric oxygen is all the more effective the sooner it is started, hopefully within 12 hours of the trauma(6,7) In addition, it is recommended not to detain the therapy more than 24 hours from the trauma to delay or cancel the vicious circle between the damaged tissue, ischemia, and oedema, which in turn causes hypoxia and consequent propagation of cellular suffering to the areas of tissue involved
A COMSUBIN Underwater Operational Group’s diver was examined who suffered from a blunt distracting trauma at the muscle belly of the brachial biceps during training. The injury incurred after exiting an aircraft during a parachute jump, when the diver suffered a rubbing impact with the diving rope, striking his right arm brachial biceps On the ground, he received first aid from a health care assistant Taken to the San Bartolomeo civil hospital’s emergency room in Sarzana, he was
Fig 1 Damaged tissue areas related to a contusion and secondary damage propagation

diagnosed with a trauma to the right arm with a brachial biceps injury and extensive hematoma and was given 15 days prognosis, unless complication arose The next morning, he was summoned to the COMSUBIN infirmary where, after a careful examination, he was treated with three cycles of hyperbaric oxygen therapy.
Reported Symptomatology: intense pain felt in the right arm ’ s brachial bicep with a proximal major and minor pecto ralis involvement. Substantial functional limitation of the limb was registered with a reduction of less than one third of the total movement.
Anamnestic data: the patient was in apparent good health, non smoker, sportsman, accustomed to hyperbaric conditions since being closely correlated
to his job as a diver The patient had no past or present pathological medical history
Physical examination: Ecchymotic edematous right upper limb with skin excoriations on the arm ’ s inner face (Fig. 2), painful to the touch on the course of the lateral insertion of the pectoral muscles, on the course of the short head of the brachial biceps and the middle of the muscle belly, complete passive arti culation of the painful shoulder to extra rotation movements, functional impo tence of flexion of the forearm on the arm, and elevation of the arm in interpo sition, reported mild paraesthesia and dysesthesia of the forearm and hand
Diagnostic evaluation: following anamnesis, physical examination and
Mil 2021; 171(2): 151 158

Fig. 2 Right arm before treatment.

musculoskeletal ultrasound test on the affected limb highlighted “ in the presence of the interruption of conti nuity of muscle fibres, extensive hema toma in biceps with an extension of about 10 cm with a thickness of about 2 5 cm ” , the following diagnosis was formulated: “blunt distracting trauma of the brachial biceps muscle belly”
Therapeutic treatments: considering the diver’s good health, his belonging to the Underwater Operating Group, his state of physical training, natural confi dence with hyperbaric atmospheres and good tolerance to hyperbaric oxygen breathing, it was decided to put him on the following cycles of HBOT as per SMM / IS / UEU 138: “Manual of underwater and hyperbaric medicine for Medical Officers” ed. 2015(8):
2 LOADING PHASE SESSIONS: TAB. 15/90 (15 meters / 90 min with air break every 20 min), TAB. 15/75 (15 meters / 75 min with air break every 20 min) on the same day
1 CONSOLIDATION SESSION: TAB 15/90 (15 meters / 90 min with air break every 20 min) the following day
Since the first session of HBOT, a clear improvement was registered from both a clinical point of view, with pain reduction and progressive recovery of the upper limb excursion, and from an objective point of view, with an ultrasound effu sion reduction a consequent decrease of the bicipital diameter.
After the third treatment, the spec trum of movement of the upper limb went from less than a third to more than a half, allowing the blunt trauma to be reclassi fied from Grade III to Grade I. Further more, the bicipital diameter was reduced from 37.5 cm to 35 cm (Figs. 3,4).
The results observed at the end of the treatments were the following:
• Symptomatic improvement
• ROM (range of motion) increase
• Grading improvement in blunt muscle injury: from Grade III to Grade I
• Overall reduction of 1 5 cm biceps diameter (oedema/hematoma reduc tion)


It was therefore decided not to carry out any further HBOT administration and

Fig. 4 bicipital diameter after the third HBOT treatment: 35 cm
instead to advise the diver to rest and abstain from manual handling of loads for 15 days, unless complications arise
Hyperbaric oxygen therapy could be fully part of treating muscle tendon trauma starting from the 3rd degree blunt distracting ones described in the aforementioned Reid classification, as it plays an important and decisive role in interrupting the propagation of tissue pain if administered within 24 hours and promoting early wound healing.
Fig. 3 Bicipital diameter before treatment: 37 5 cm
The Authors declare that they have no relationships relevant to the contents of this paper to Disclose
Manuscript received September 15, 2020; revised January 11, 2021; accepted April 21, 2021

Riassunto - La resezione dell'aorta toracica in caso di traumi toracici è una situazione di emergenza Riportiamo il caso di un paziente maschio di 46 anni, giunto al pronto soccorso per politrauma a seguito di caduta da una grande altezza La tomografia computerizzata (TC) ha rivelato la rottura dell'istmo aortico in prossimità dell'arteria succlavia sinistra, pneumotorace, multiple fratture pelviche, dell’omero sinistro e frattura dell'orbita. Viene scelto un approccio totalmente endovascolare con riparazione dell'aorta toracica (TEVAR) associata alla tecnica “Chimney”. L'angiografia finale documentava la pervietà di tutti gli stent graft, dei vasi dell'arco aortico e dell'arteria vertebrale sinistra, l'esclusione della rottura aortica, in assenza di endoleak. Immedia tamente dopo è stata eseguita la fissazione esterna delle fratture multiple del bacino e degli arti La riparazione totalmente endovascolare della lesione aortica nel politrauma consente di stabilizzare i pazienti prima di eseguire, in sicurezza, le altre operazioni ricostruttive La tecnica “Chimney” sull'arteria succlavia è una strategia di salvataggio fattibile in urgenza
Parole chiave: Rottura istmica aortica, politrauma, TEVAR, Chimney
Messaggi chiave:

• La riparazione totalmente endovascolare di un trauma aortico toracico in un paziente politrauma permette di stabilizzare il paziente prima di eseguire, in sicurezza, le altre operazioni di ricostruzione
• La tecnica Chimney sull’arteria succlavia sinistra è una strategia fattibile in urgenza
La rottura traumatica dell'aorta tora cica, nel trauma toracico, è un ' emer genza clinica letale per la vita, e risulta, tra i traumi, la seconda causa più comune di morte dopo il trauma cranico.(1)
La rottura traumatica dell'aorta nella maggior parte dei casi è un evento fatale con il 70 80% di morte immediata. Il
30% dei sopravvissuti può morire nelle 24 ore successive (2)
È associata in primo luogo a scontri tra veicoli a motore, ma anche a diversi incidenti non stradali come precipita zione, arrampicata su roccia ed esplo sioni,(2,3) come è spesso riportato in ambito militare.(4)
Sebbene qualsiasi punto dell'aorta possa essere coinvolto, di solito si veri fica nell'istmo aortico in oltre il 90%
dei casi (3 5)
Durante l'impatto l'istmo rappre senta il punto di transizione tra l'aorta toracica discendente, vincolata alla parete toracica posteriore dalle arterie intercostali, e l'arco aortico, mobile rispetto al resto (5)
Riportiamo un caso di riparazione totalmente endovascolare mediante accesso percutaneo di una rottura trau matica istmica.
* MD, Dipartimento di Biomedicina e Prevenzione, Unità di Chirurgia Vascolare, Università di Roma Tor Vergata, Viale Oxford 81, 00133 Roma Italia
* Cap me , UOC di Chirurgia, Policlinico Militare Celio Roma Italia
° MD, Dipartimento di Biomedicina e Prevenzione, Unità di Chirurgia Vascolare, Università di Roma Tor Vergata, Viale Oxford 81, 00133 Roma Italia
°° MD, Professore, Dipartimento di Biomedicina e Prevenzione, Unità di Chirurgia Vascolare, Università di Roma Tor Vergata, Viale Oxford 81, 00133 Roma. Italia.
Corrispondenza: Cap. me. Raffaele Carnevale. Piazza Celimontana, 50, 00184 Roma. Email: carnevale.raffaele@gmail.com

G Med Mil 2021; 171(2): 159 166

Paziente maschio, 46 anni, tossicodi pendente, viene trasportato presso il Pronto Soccorso per politrauma a seguito di una caduta da elevata altezza All'in gresso, è stato riscontrato un trauma cere brale (8 punti sulla scala Glasgow) I suoi segni vitali erano: pressione sanguigna 100/60, frequenza respiratoria 22 atti respiratori al minuti e frequenza cardiaca 97 battiti al minuto. I test di laboratorio hanno mostrato emoglobina a 10,40 g / dL, ematocrito 31,1%, piastrine a 131.000 cellule / mm3 e 1,12 mg / dL di creatinina. La tomografia computerizzata (TC) total body con mezzo di contrasto è stata eseguita immediatamente ed ha docu mentato una rottura dell'istmo aortico in prossimità dell'arteria succlavia sinistra; inoltre sono stati osservati pneumotorace, multiple fratture pelviche, dell’omero sini stro e frattura dell'orbita Le misurazioni e la pianificazione preoperatorie sono state eseguite rapidamente con un software dedicato OsiriX MD (Pixmeo Labs, Ginevra, Svizzera) Sono state escluse anomalie dell'arco ed è stata evidenziata la pervietà dell'arteria succlavia e l'arteria vertebrale sinistra Considerando le condizioni critiche del paziente e la presenza di fratture multiple per le quali sarebbe dovuto essere trattato, si è scelto un approccio totalmente endovascolare con riparazione endovascolare dell’aor tica toracica (TEVAR) associata alla tecnica “Chimney”.
Il paziente è stato operato in anestesia generale in sala angiografica dedicata, utilizzando un arco a C fisso (Allura Xper, Philiphs, Andover, MA, USA). E’ stato eseguito un accesso percutaneo dell’ar teria femorale bilateralmente e dell’arteria brachiale sinistra con il preimpianto del sistema di chiusura Perclose Proglide (Abbott Vascular, Santa Clara, CA, USA)

L’angiografia pre operatoria ha confer mato la rottura dell’istmo dell’aorta con la presenza di spandimento di mezzo di contrasto in Zona 2 (Classificazione di Ishi maru) (Fig. 1) Dall’accesso femorale destro è stata posizionata un guida rigida (Lunderquist TSCMG 35 300 LESDC) appena al di sopra del piano valvolare aortico Dall’accesso brachiale sinistro, attraverso un introduttore 8 Fr, è stato posizionato uno stent pre montato su pallone Gore Viabahn VBX (W. L. Gore & Associates, Flagstaff, AZ) con estremo distale in arco aortico ed estremo prossi male appena prima dell’emergenza dell’ar teria vertebrale sinistra. Successivamente un ’endoprotesi toracica Zenith Alpha (Cook Medical, Bloomington, Ind) è stata fatta avanzare, attraverso un introduttore 16 Fr, dall’accesso femorale destro fino alla zona di atterraggio sana subito al di sotto
dell’arteria carotide sinistra L’endoprotesi toracica e lo stent in succlavia sinistra sono stati rilasciati correttamente in configura zione “Chimney”

L’angiografia finale documentava che tutti i dispositivi, i vasi epiaortici e l’ar teria vertebrale sinistra risultavano pervi con completa esclusione della rottura aortica ed in assenza di Endoleak (Fig. 2) Tutti gli accessi percutanei sono stati correttamente chiusi mediante serraggio delle suture preimpiantate con il Proglide. Tutti i polsi periferici erano presenti a fine procedura in assenza di flussimetria patologica agli arti. L’intera procedura è stata eseguita in solo 45 minuti, con bassa dose di radiazioni.
Il paziente è stato ricoverato in terapia intensiva, la fissazione esterna delle fratture pelviche e delle estremità è stata eseguita immediatamente dopo,
quando il paziente risultava emodinami camente stabile
Una Tomografia computerizzata con mezzo di contrasto è stato eseguita 3 giorni dopo e mostrava una normale pervietà dell’endoprotesi, della Chimney e dei vasi epiaortici in assenza di segni di Endoleak (Fig. 3)
La degenza è stata regolare in assenza di segni di ischemia midollare ed il paziente è stato dimesso in 18ª gior nata post operatoria.
Al follow up, otto mesi dopo l’inter vento, il paziente era asintomatico e completamente guarito.

Nel 1958 Parmley ha proposto una prima classificazione delle lesioni aortiche (6) Questa classificazione, tuttavia, ad oggi risulta purtroppo irrile vante poichè basata sull'istopatologia Al fine di ottenere un approccio sistematico per la prognosi e per l'indicazione terapeu tica, sono stati introdotti nuovi metodi Azizzadedh ha classificato le lesioni aortiche traumatiche in quattro categorie in base alla gravità Queste includevano: grado 1, lacerazione intimale; grado 2, ematoma intramurale; grado 3, pseudoa neurisma aortico; e grado 4, rottura franca (1) Il nostro paziente mostrava uno spandimento di mezzo di contrasto in prossimità dell'arteria succlavia sinistra, quindi un grado 4. Per tale motivo si è deciso di operare in urgenza.

Le radiografie possono mostrare l'allargamento del mediastino in caso di emotorace e la risonanza magnetica è più utilizzata nel follow up.(7) La tomo grafia computerizzata è abitualmente utilizzata in caso di politrauma ed attualmente è considerata il gold stan dard per lo screening e la diagnosi delle

lesioni traumatiche (8) L'angiografia digitale può essere utilizzata durante la riparazione endovascolare, mentre l'ecografia intravascolare (IVUS) per confermare la classificazione della lesione (1) Nel nostro caso, è stata eseguita immediatamente una tomo grafia computerizzata per una rapida diagnosi e indicazione chirurgica L'as senza di anomalie dell'arco, la pervietà dell'arteria succlavia sinistra e dell'asse femoro iliaco sono state confermate prima di iniziare il trattamento.
La riparazione convenzionale a cielo aperto è spesso soggetta a morbilità e mortalità significative.(9) Nella maggior parte dei casi, i pazienti politraumatizzati possono non tollerare le manipolazioni periprocedurali e la toracotomia a causa dell'instabilità cervicale e della presenza di fratture multiple (10) La riparazione endovascolare è considerata vantaggiosa rispetto alla riparazione a cielo aperto con minor tassi di mortalità operatoria, morbilità e ischemia del midollo spinale e le attuali linee guida prevedono la TEVAR come metodo elettivo per la rottura istmica traumatica (11)
La tecnica Chimney per l'arco aortico è una soluzione totalmente endovascolare per il trattamento di lesioni istmiche e altre patologie dell'arco aortico ed è caratterizzata da risultati a medio termine soddisfacenti in termini di tasso di mortalità e pervietà, sia in situazioni elettive che in emergenza.(12) Secondo il Registro Multicentrico Europeo, la tecnica Chimney/Snorkel, nel trattamento delle condizioni patologiche dell'arco aortico, è una strategia di salvataggio con un basso tasso di reinterventi.(13) Gli approcci ibridi, con bypass carotido succlavio sinistro, hanno esiti soddisfa centi, ma implicano la necessità di molteplici procedure,(13) e potrebbe
non essere una soluzione tecnicamente fattibile nel politrauma
Nel nostro caso abbiamo optato per una soluzione rapida totalmente endova scolare in un unico tempo chirurgico in modo che il paziente potesse essere curato anche da altri specialisti in totale sicurezza
La riparazione totalmente endova scolare di una lesione aortica toracica in un politrauma consente di stabilizzare il paziente prima di eseguire, in sicurezza, le successive operazioni ricostruttive. La tecnica Chimney sull'arteria succlavia sinistra è una strategia di salvataggio attuabile in urgenza La diagnosi precoce, l'esecuzione rapida e la disponibilità di materiali sono elementi chiave per la risoluzione dei casi urgenti
1. Azizzadeh A, Keyhani K, Miller CC 3rd, Coogan SM, Safi HJ, Estrera AL. Blunt traumatic aortic injury: initial experience with endovascular repair J Vasc Surg 2009;49:1403 8
2. Gombert A, Barbatu ME, Stork M, Kotelis D, Keschenau P, Pape HC, et al. Treatment of blunt thoracic aortic injury in Germany Assessment of the TraumaRegister DGU Plos One 2017; 12: e0171837
3. Di Marco L, Pcini D, Di Bartolomeo R. Acute traumatic thoracic aortic injury: considerations and reflections on the endovascular aneurysm repair Aorta (Stamford) 2013;1:117 122
4. Xu Y, Xu W, Wang A, Meng H, Wang Y, Liu S, Li R, Lu S, Peng J. Diagnosis and treatment of traumatic vascular injury of limbs in military and emergency medicine: A systematic review Medicine (Baltimore) 2019 May;98(18):e15406
5. Richens D, Field M, Neale M, Oakley C. The mechanism of injury in blunt
traumatic rupture of the aorta Eur J Cardiothorac Surg (2002) 21(2):288 93 doi:10 1016/S1010 7940(01)01095 8
6 Parmley LF, Mattingly TW, Manion WC, Jahnke EJ Nonpenetratingtraumatic injury of the aorta Circulation 1958;XVII:1958.
7. Anguilar Alaniz E, Reyes Pavon R, Ruiz Romero J, Esparza Pantoja J. Traumatic rupture of the aortic isthmus: Delayed treatment and open repair A case report Arch Cardiol Mex (Eng) 2019; 89 255
8. Cullen E, Lantz E, Johnson C, Young P. Traumatic aortic injury: CT findings, mimics, and therapeutic options Cardiovasc Diagn Ther 2014;4:238 44
9 von Oppell UO, Dunne TT, De Groot MK, Zilla P Traumatic aortic rupture: twenty year metaanalysis of mortality and risk of paraplegia Ann Thorac Surg 1994;58:585 93
10. Brinster DR. Endovascular repair of blunt thoracic aortic injuries Semin Thorac Cardiovasc Surg (2009) 21(4):393 8 doi:10.1053/j.semtcvs.2009.11.003.
11 Writing Committee, Riambau V, Böckler D, Brunkwall J, Cao P, Chiesa R, et al Editor’s choice management of descending thoracic aorta diseases: clinical practice guidelines of the European Society for Vascular Surgery (ESVS). Eur J Vasc Endovasc Surg (2017) 53(1):4 52 doi:10 1016/j ejvs 2016 06 005
12 Li Y, Hu Z, Wang J, Zhang Y, Chen Z, Zhang H, Endovascular ChimneyTechnique for Aortic Arch Pathologies Treatment: A Systematic Review and Meta Analysis, Annals of Vascular Surgery (2017), doi: 10 1016/j avsg 2017 09 00
13 Bosiers MJ, Donas KP, Mangialardi N, Torsello G, Riambau V, Criado FJ, Veith FJ, Ronchey S, Fazzini S, and Lachat M, European Multicenter Registry for the Performance of the Chimney/Snorkel Technique in the Treatment of Aortic Arch Pathologic Conditions Ann Thorac Surg 2016; 0003 4975
Gli Autori dichiarano nessun conflitto di interessi.
Articolo ricevuto il 29 11 2020; rivisto il 02 12 2020; accettato il 16 02 2021
2021; 171(2): 159 166

Abstract Traumatic transection of the thoracic aorta is a life threating emergency in blunt thoracic injury We report a case of a 46 years old male patient, comes in emergency department for polytrauma following a fall from a great heigh Computed Tomography Angiography (CTA) revealed aortic isthmic rupture in close proximity to left subclavian artery, pneumothorax, multiple pelvis, left humerus and orbit fracture It is chosen a total endovascular approach with thoracic endovascular aortic repair (TEVAR) associated with Chimney technique At the completion angiography all the stent grafts, the aortic arch vessels and left vertebral artery were patent, exclusion of aortic rupture and no endoleaks were found The external fixation of multiple pelvis and extremities fractures were performed immediately afterwards Totally endovascular repair of blunt aortic injury in polytrauma allows to stabilize the patients before performing safely the delayed reconstructive operations Chimney technique on sublcavian artery is a bail out strategy feasible in urgency
Keywords: aortic isthmic rupture, polytrauma, TEVAR, Chimney.
Key messages:

• Totally endovascular repair of thoracic aortic injury in polytrauma allows to stabilize the patients before performing safely the delayed recon structive operations
• Chimney technique on left sublcavian artery is a bail out strategy feasible in urgency.
Traumatic transection of the thoracic aorta is a life threating emergency in blunt thoracic injury and is the second most common cause of death after head trauma.(1)
Traumatic aortic rupture in most cases is a fatality event with 70 80% of
victims at the scene, and 30% of survi vors can die in the following 24h (2)
It is associated firstly with motor vehicle fatalities, but also with a several accidents far from street such as free fall, rock climbing and explosions,(2,3) as is often reported in military medicine.(4)
Although any point in the aorta may be involved, it usually occurs at the aortic
isthmus in more than 90% of cases (3 5)
During the impact the isthmus repre sents the transition point between the descending thoracic aorta attached to the posterior thoracic wall by the intercostal arteries, and the mobile aortic arch (5)
We report a case of a totally percuta neous endovascular repair of a traumatic aortic isthmic rupture.
* MD, Department of Biomedicine and Prevention, Vascular Surgery Unit, University of Rome Tor Vergata, Viale Oxford 81, 00133 Rome Italy
* Captain of Italian Army, Surgery Unit, Policlinico Militare Celio Rome Italy


° MD, Department of Biomedicine and Prevention, Vascular Surgery Unit, University of Rome Tor Vergata, Viale Oxford 81, 00133 Rome Italy
°° MD, Professor, Department of Biomedicine and Prevention, University of Rome Tor Vergata, Viale Oxford 81, 00133 Rome Italy.
Corresponding author: Captain of Italian Army Raffaele Carnevale. Piazza Celimontana, 50, 00184 Roma.
Email: carnevale raffaele@gmail com
A 46 years old male patient, drug addict, comes in our emergency depart ment for polytrauma following a fall from a great height On admission to the emer gency room, traumatic brain trauma was found (8 points on the Glasgow Coma Scale) His vital signs were blood pres sure 100/60, respiratory rate 22, and heart rate 97. His laboratory tests showed hemoglobin at 10.40 g/dL, hematocrit 31.1%, platelets at 131.000 cells/mm3, and 1.12 mg/dL creatinine. Total body Computed Tomography Angiography (CTA) was done immedia tely. It revealed aortic isthmic rupture in close proximity to left subclavian artery; in addition, pneumothorax, multiple pelvis, left humerus and orbit fracture were also observed Quickly preopera tive measurements and planning was performed with a dedicated software OsiriX MD (Pixmeo Labs, Geneva, Swit zerland) Arch anomalies are excluded and patency of left sublcavian artery and vertebral artery has been evaluated The patient was frail and due to the presence of multiple fractures for which he should have been treated, It is chosen a total endovascular approach with thoracic endovascular aortic repair (TEVAR) asso ciated with Chimney technique
The patient was operated in angio suite using a fixed C Arm (Allura Xper, Philiphs, Andover, MA, USA) under general aenesthesia. The percutaneous approach to common femoral arteries and left brachial artery was performed using preclose technique with Perclose Proglide (Abbott Vascular, Santa Clara, CA, USA). Angiography confirms aortic isthmic rupture with contrast agent spreading from Landing Zone 2 (Ishi maru classification) (Fig 1) From the right femoral a superstiff guide wire
(Lunderquist TSCMG 35 300 LESDC)

was carried just above the aortic valve plan From the left brachial artery, via a 8 Fr sheath, was introduced a Gore Viabahn VBX balloon expandable endo prosthesis (W L Gore & Associates, Flag staff, AZ), its distal edge advanced in the aortic arch, and its proximal edge released just below the left vertebral artery Successively a Zenith Alpha thoracic endovascular graft (Cook Medical, Bloomington, Ind) was advanced via a 16 Fr sheath from the right femoral access up to the healthy intended landing zone just below the left common carotid artery. The thoracic stent graft was placed successfully and the left subclavian endoprosthesis released in a Chimney configuration
At the completion angiography all the stent grafts, the aortic arch vessels and

left vertebral artery were patent, total exclusion of aortic rupture and no any type of endoleaks were found (Fig. 2) All the percutaneous accesses were succes sfully and safety closed with the Proglide suture and no further procedures were needed All peripheral pulses were present without any pathological blood pressure difference between the two upper limbs Whole procedure lasted just 45 minutes, with low radiation dose.
Admission to the intensive care unit was decided; the external fixation of multiple pelvis and extremities fractures were performed immediately afterwards, when the patient was hemodynamically stable.
A CT scan was performed after 3 days, and showed regular patency of chimney grafts and epiaortic vessel with no evidence of endoleak (Fig 3)
Zone 2
The in hospital stay was uneventful without signs of spinal cord ischemia and the patient was discharged on the 18th postoperative day

In the follow up visit 8 months after surgery, the patient was asymptomatic and with complete recovery

In 1958 Parmley et al. proposed a first classification of blunt aortic injury (BAI).(6) This classification, however, is unfortunately not relevant for today’s clinicians because it is histopathologi cally based. In order to obtain a syste matic approach for prognosis and thera peutic indication, new methods have been introduced Azizzadedh et al classi fied traumatic aortic injuries into four categories based on severity These included: grade 1, intimal tear; grade 2, intramural hematoma; grade 3, aortic pseudoaneurysm; and grade 4, free rupture (1) Our patient showed contrast spreading in close proximity to left subclavian artery, so a grade 4 It's decided to operate in urgent
X ray can show mediastinal widening in case of hemothorax, and magnetic resonance angiography imaging could be better used in follow up (7) CTA scan is routinely used in case of polytrauma and currently it is considered the gold stan dard for blunt trauma injuries screening and diagnosis.(8) Digital angiography can be used during endovascular repair and intravascular ultrasound (IVUS) to confirm the classification of the lesion.(1) In our case, a CTA was performed imme diately for rapid diagnosis and surgical indication Absence of arch anomalies, patency of left sublcavian artery and femoral iliac axis are confirmed before starting treatment

Conventional open repair is a is often accompanied by significant morbi dity and mortality (9) In most cases, polytrauma patients may not tolerate periprocedural manipulations and thoracotomy due to cervical instability and synchronous presence of multiple fractures (10) Endovascular repair is considered advantageous compared to open repair with lower operative mortality, morbidity, and spinal cord ischemia rates and current guidelines accepted TEVAR as a first line repair method for traumatic isthmic rupture.(11)
Chimney technique for the aortic arch is a total endovascular solution to treat blunt isthmic injury and other aortic arch pathologies and it produced
satisfied midterm outcomes in term of death rate and patency, in both elective and emergent situations (12) According to European Multicenter Registry, Chimney/Snorkel Technique, in the treatment of aortic arch pathologic conditions, is a bail out strategy with a low rate of reinterventions (13) The hybrid approaches, with left carotid subclavian bypass, have satisfactory outcomes, but but they imply the need for multiple procedures,13 and might not be a technically feasible solution in the polytrauma.
In our case, we opted for a rapid totally endovascular solution in one surgical time so that the patient could also be treated by other specialists in totally safety

Totally endovascular repair of BAI in polytrauma allows to stabilize the patients before performing safely the delayed recon structive operations Chimney technique on left sublcavian artery is a bail out strategy feasible in urgency Early diagnosis, fast execution and availability of materials are key elements for resolution of urgent cases.
The Authors declare that they have no relationships relevant to the contents of this paper to Disclose
Manuscript received November 29, 2020; revised December 02, 2020; accepted February, 16, 2021

Il trapianto cardiaco ha notevolmente modificato la prognosi delle cardiopatie end stage. Il primo trapianto di cuore fu eseguito da Christian Barnard a Cape Town, Sudafrica, nel 19671 [1]. Nonostante il grande impatto di questo intervento, non solo nella comu nità scientifica ma anche nell’opinione pubblica, solo negli anni ’80 il trapianto di cuore si è affermato come opzione terapeutica reali stica e praticabile nei pazienti con cardiopatia avanzata. In Italia il primo trapianto di cuore è stato eseguito da Vincenzo Gallucci a Padova, nel novembre 1985 Nel giro di poche settimane tutti i Centri che avevano avuto l’autorizzazione dal Ministero della Sanità (come allora si chiamava quello che oggi è il Ministero della Salute), situati prevalentemente nell’Italia settentrionale, iniziarono la propria attività Oggi in Italia vi sono 16 Centri abilitati al trapianto di cuore, di cui 3 destinati al trapianto pediatrico
Una delle principali fonti di informazioni sul trapianto di cuore è rappresentata dal registro dell’International Society for Heart and Lung Transplantation (ISHLT), cui hanno aderito più di 300 Centri in tutto il mondo, in prevalenza statunitensi Sulla base dei dati dell’ISHLT Registry, si nota come i risultati del trapianto siano migliorati nel corso degli anni: attualmente si prevede che i pazienti che ricevono un trapianto cardiaco hanno una mortalità intraospedaliera minore del 5%, un tasso di soprav vivenza ad un anno che si avvicina all'85 90% (86,8%) ed a cinque anni al 73 6% In Italia dal 2000 il Ministero della Salute, attra verso il Centro Nazionale Trapianti, esegue un monitoraggio costante dei risultati di tutta l’attività di trapianto d’organo Nel periodo 2000 2018 in Italia sono stati effettuati 5500 trapianti in 18 centri autorizzati (i centri attualmente attivi sono 15), con una soprav vivenza a 1 anno dei riceventi adulti dell’82 2% (range 81 0 82 5%) [2]
Non solo la quantità di vita ma anche e più spiccatamente la qualità di vita del paziente viene migliorata dal trapianto cardiaco [3]
L'indicazione clinica al trapianto è rappresentata dalla cardiopatia in fase terminale per la quale non vi sia spazio né per la terapia medica né per la terapia chirurgica tradizionale, e per la quale l'aspettativa di vita sia inferiore a 6 12 mesi, in un paziente con età anagrafica e fisiologica inferiore a 60 anni non gravato da altre malattie sistemiche (Fig. 1)
Le indicazioni patologiche considerano quindi malattie cardiache che compromettono irreversibilmente la funzionalità musco lare ventricolare e quindi la contrattilità:
• cardiomiopatie primitive (dilatativa, restrittiva o ipertrofica aritmogenica);

• cardiomiopatie secondarie (ischemia, malattie valvolari con coinvolgimento della funzionalità contrattile, neoplastica senza metastasi e senza recidive per almeno 5 anni, post chemioterapica);

• cardiomiopatie congenite complesse (caratterizzate da ipertrofia e fenomeni disritmici, ad es. la Sindrome di Null).
Più in generale la cardiopatia ischemica e la cardiomiopatia dilatativa idiopatica sono le principali malattie di base che conducono allo scompenso cardiaco severo sufficiente da servire come indicazione al trapianto cardiaco nell’adulto. Seguono le cardiopatie valvolari avanzate e le cardiopatie congenite.
* Dr , Primo Dirigente Medico della Polizia di Stato Ministero dell’Intero Dipartimento della Pubblica Sicurezza Direzione Centrale di Sanità Roma
** Dott ssa, Medico Principale della Polizia di Stato Ministero dell’Intero Dipartimento della Pubblica Sicurezza Direzione Centrale di Sanità Roma
G Med Mil 2021; 171(2): 167 172

• Per una compromissione emodinamica dovuta a scompenso cardiaco
• Shock caardiogeno refrattario
• Documentata dipendenza da un suppor to inotropo endovenoso per mantenere un ’adeguata per fusione di organo
• Picco Vo2<10ml/Kg/min con raggiungimento di un metabolismo anaerobico
• Gravi sintomi di ischemia che limitano notevolmente l’attività di routine e non sono passibili di inter vento di bypass chirurgico o di inter vento coronarico percutaneo
• Ricorrenti aritmie ventricolari sintomatiche refrattarie a tutte le modalità terapeutiche

• Picco Vo2 11 14 ml/Kg/min (o 55% del predetto) e impor tante limitazione delle attività quotidiane del paziente
• Ricorrenti crisi di ischemia instabile non passibili di altri inter venti
• Ricorrente instabilità del bilancio idrico/funzione renale non dovuta a mancata compliance del paziente al regime terapeutico
• Bassa frazione di eiezione ventricolare sinistra
• Anamnesi positiva per sintomi scompenso cardiaco di classe funzionale III o IV
• Picco Vo2>15 ml/Kg/min (e >55% del predetto) senza altre indicazioni
Vo2 = consumo di ossigeno nell’unità di tempo per Kg di peso corporeo
Fig. 1 Linee Guida ACC/AHA: indicazioni per il trapianto cardiaco.
L’analisi dei benefici dopo il trapianto cardiaco è stata focalizzata soprattutto in termini di sopravvivenza La qualità di vita dopo trapianto di cuore è stata invece specificamente indagata solo in studi di dimensioni relativamente modeste Dati generali in merito alla necessità di ricovero, all’autonomia funzionale e allo stato lavorativo provengono ancora una volta dall’ISHLT Registry [4]. Il 45% dei pazienti va incontro ad almeno un ricovero nel primo anno post trapianto, percentuale che si riduce a poco più del 20% negli anni successivi; più del 90% dei pazienti viventi ha un ’autonomia funzionale completa sia a breve sia a lungo termine, ma solo il 38 41% ritorna all’abituale mansione lavorativa
Inoltre il trauma psicologico residuo di aver sofferto di una devastante e quasi fatale malattia trattata con un di fatto inusuale intervento chirurgico non può essere comunque ignorato.
In generale, l’autonomia funzionale dei pazienti trapiantati è buona [5] I fattori che possono condizionare sfavorevolmente la qualità di vita (oltre che la sopravvivenza) nel lungo periodo sono legati alla susseguente terapia medica cronica immunosoppressiva, richiesta per il mantenimento della tolleranza immunitaria dell’organo, che può causare una varietà di effetti collaterali e di complicanze (Fig 2)
Tra le complicanze si annoverano:
• Rigetto (iperacuto, acuto, cronico): il rigetto cronico è responsabile del 36% di morte al primo anno e rappresenta la causa del 60% dei ritrapianti
• Neoplasie: l'incidenza dei tumori è del 9,8% nei pazienti trapiantati (rispetto allo 0,6 nella popolazione generale) Tra questi si distin guono in percentuale tumori solidi (56%); 26% tumori linfoproliferativi (26%); tumori cutanei (9%); sarcoma di Kaposi (9%)
• Alterazioni emodinamiche: comprendono la vasculopatia polmonare con scompenso destro e l'insufficienza cardiaca.
• Infezioni: sono legate alla terapia immunosoppressiva e sono più frequenti nei primi 6 mesi (con picco al primo mese). Frequen temente coinvolti sono i batteri nosocomiali (stafilococchi), i miceti, il CMV ed i germi opportunistici quali lo Pneumocystis Carinii A un anno dal trapianto il 40% dei pazienti ha subito almeno un'infezione maggiore e più dell'80% almeno un'infezione minore
• Affezioni renali: l'insufficienza renale che può comparire è legata al trattamento con inibitori della calcineurina La maggiore compromissione accade nei primi sei mesi e sembra stabilizzarsi entro un anno dal trapianto cardiaco.
• Disturbi gastrointestinali: colelitiasi biliare, pancreatite da colestasi
• Disturbi endocrinologici: a causa della terapia immunosoppressiva con steroidi e inibitori della calcineurina, si può sviluppare un'intolleranza al glucosio che esita in diabete mellito Per gli stessi meccanismi eziopatologici si riporta un aumento del tasso di iperlipidemia (60 80% dei pazienti), osteoporosi (10% dei pazienti) e obesità (49% dei pazienti)
• Affezioni vascolari: l'ipertensione arteriosa compare nel 50 90% dei pazienti ed è causata dagli inibitori della calcineurina per stimolazione simpatica, effetti neuroormonali ed effetti vasco lari diretti sul circolo renale
Mentre le complicanze tipiche dei primi mesi post trapianto, il rigetto e le infezioni, risultano controllabili nella maggior parte dei casi, diverso è il discorso inerente all’outcome a lungo termine Anche in questi ambiti è probabile che la combina zione ragionata degli immunosoppressori possa limitare il danno e migliorare la qualità di vita dei pazienti, tuttavia vi è assoluta carenza di studi clinici rivolti ai soggetti trapiantati da lungo tempo.
I pochi studi clinici disponibili hanno compro vato che lo stato funzionale del trapianto di cuore dei riceventi che sopravvivono oltre un anno è eccellente; la tolleranza all'esercizio fisico resta inferiore alla norma per un notevole decondiziona mento muscolare, ma è sufficiente per lo svolgimento delle attività quotidiane e può aumentare nel tempo con la reinnervazione simpa tica e con il training
Fig. 2 Valutazione qualità cuore prospetto ITALIA Centro Nazionale Trapianti
Dati italiani riportano che il 97% dei sopravvissuti risulta in classe NYHA I II ad un follow up medio di 54 ± 37 mesi ed il registro dell’International Society for Heart and Lung Transplantation riferiscono che ad 1 anno dal trapianto l’82 89% dei pazienti si consi dera privo di limitazioni nell’attività, e solo l’8% con una limitazione moderata, mentre secondo uno studio del National Heart Tran splant i trapiantati, su una scala da 1 a 100, indicano un valore medio della valutazione soggettiva della propria capacità lavorativa di 58 [6]. La capacità massima di lavoro del trapiantato, in pratica, è ridotta di circa il 25 50%, anche se l’allenamento è in grado di produrre incrementi della tolleranza allo sforzo di circa il 15 20%

Un miglioramento della capacità funzionale dettato da una specifica riabilitazione fisica è infatti intimamente correlato con una maggiore possibilità di incrementare il grado di attività favorendo l’autosufficienza e la produttività. Tuttavia, stabilire un rapporto tra training fisico e ritorno al lavoro è difficile poiché molti fattori possono entrare in gioco [7,8]

Da un punto di vista di idoneità alla guida la legislazione italiana e più estesamente europea hanno sancito criteri di unanimità per il rilascio e/o rinnovo di patente a pazienti sottoposti a trapianto cardiaco.
Il comitato per la patente di guida della Commissione Europea [9] ha istituito infatti nel 2016 un gruppo di lavoro in materia di guida e malattie cardiovascolari con l'obiettivo di valutare i rischi per la sicurezza stradale associati alle malattie cardiovascolari da un punto di vista medico aggiornato e di elaborare linee guida adeguate. L'allegato III della direttiva 2006/126/CE del Parlamento europeo [10] è stato infatti modificato conformemente all'allegato della direttiva (UE) 2016/1106 della commissione del 7 luglio 2016 [11] ed adottato dagli Stati membri a partire dal 1 Gennaio 2018 (Fig. 3)
In particolare la sezione 9 (affezioni cardiovascolari) è stata sostituita e recita quanto segue:
“Per le seguenti patologie cardiovascolari la patente di guida può essere rilasciata o rinnovata al candidato o conducente del gruppo indicato soltanto dopo che la patologia è stata curata efficacemente e previa certificazione medica specialistica e, se del caso, valutazione medica periodica:
[p) trapianto di cuore (si applica ai gruppi 1 e 2);]”
G Med Mil 2021; 171(2): 167 172
Fig 3 Idoneità alla guida, legislazione italiana
Inoltre un parere espresso dalla sezione III del Consiglio Superiore di Sanità nella seduta straordinaria del 19 Febbraio 2018 concernente “Richiesta di parere in ordine al rilascio e al rinnovo della patente di guida rilasciata a soggetti trapiantati” ha ritenuto che “[ ] I soggetti trapiantati vengano valutati presso la Commissione Medico Locale in occasione della prima visita successiva al trapianto Nel caso in cui la Commissione Medico Locale valuti il soggetto come affetto da patologia stabilizzata e non suscettibile di aggrava mento, i successivi rinnovi, possano essere effettuati dal Medico monocratico, salvo che quest’ultimo non ritenga necessaria una nuova visita collegiale. [..] Ai soggetti affetti da patologia specializzata e non suscettibile di aggravamento, si applichi, per quanto riguarda la validità della patente di guida, la scadenza naturale prevista dall’art. 126 commi 2,3 e 4 del decreto legislativo 30Aprile 1992, n. 285”.
Del tutto differente è invece il discorso per il conseguimento e la conferma dell’idoneità lavorativa Malgrado i progressi della medicina trapiantologica e la stabilizzazione per lunghi periodi delle condizioni dei soggetti trapiantati vi è ancora l’assoluta mancanza di linee guida vigenti. Questo annoso problema riguarda anche la questione degli interventi di tipo assistenziale e previ denziale che il nostro Sistema della Sicurezza Sociale garantisce a tali categorie di pazienti, con una panoramica sui parametri valu tativi del danno in ambito medico legale, allargata anche al settore della responsabilità civile [12]
Le limitazioni lavorative hanno di certo conseguenze dirette sulla qualità di vita del paziente e dei suoi cari Come ampliamente già discusso il miglioramento dei risultati clinici in termini di qualità di vita infatti, è dovuto soprattutto a una riduzione della morta lità a breve termine, mentre rimane costante l’impatto delle complicanze di lungo periodo.
Di fondamentale importanza risulta inoltre la percezione soggettiva della propria validità e la volontà del paziente di tornare o meno al lavoro, sia quando il trapiantato tende al reinserimento lavorativo vivendolo come realizzazione, recupero, rinascita dopo la mortificazione dell’emarginazione preintervento, sia quando, pur avendo riacquistato una buona discreta capacità funzionale, mostra un’incapacità etica, psicologica al lavoro, essendo interessato unicamente alla strenua difesa della propria salute riconquistata [12].
E’ altresì necessario garantire non solo la sicurezza del soggetto trapiantato nel luogo di lavoro ma la più generale sicurezza pubblica che può essere influenzata a vari livelli dall’operato del paziente/lavoratore Infatti è vero che la qualità di vita dopo il trapianto risulta nettamente migliorata, ma equiparare la funzionalità d’organo di un soggetto trapiantato a quella di un soggetto “ sano ” non è stato ancora scientificamente possibile.
Ne scaturisce che la valutazione soggettiva del caso non può e non deve prescindere da linee guida evidence based, tuttora scarse, e da norme legislative future che possano facilitare l’accesso dei soggetti trapiantati a procedure semplificate, ma sicure e oggettive


1. Barnard CN. The operation. A human cardiac transplant: an interim report of a successful operation performed at Groote Schuur Hospital, Cape Town S Afr Med J 1967; 41: 1271 4
2. www.trapianti.ministerosalute.it.

3 Maria Frigerio, Fabrizio Oliva, Fabio M Turazza, Francesca Macera, Silvia Galvanin, Alessandro Verde, Giuseppe Bruschi, Giovanna Pedrazzini: Come sono cambiate la sopravvivenza e la qualità di vita del paziente trapiantato? G Ital Cardiol Vol 9 Luglio 2008: 461 471
4 Taylor DO, Edwards LB, Boucek MM, et al : Registry of the International Society for Heart and Lung Transplantation: twenty fourth official adult heart transplant report 2007. J Heart Lung Transplant 2007; 26: 769 81.
5. Grady KL, Naftel DC, Kobashigawa J, et al.: Patterns and predictors of quality of life at 5 and 10 years after heart transplantation J Heart Lung Transplant 2007; 26: 535 43
6 Hosenpud JD, Bennett LE, Keck BM, Fiol B, Boucek MM, Novick RJ : The Registry of the International Society for Heart and Lung Transplantation: 15th official report 1998 J Heart Lung Transplant 1998; 17: 656 68
7 Grady KL, Jalowiec A, White Williams C : Predictors of quality of life in patients at one year after heart transplantation J Heart Lung Transplant 1999; 18: 202 10 124
8. Schulman LL.: Quality of life issues in transplantation: thoracic organ transplantation Transplant Proc 2001; 33: 1878 9
9. Nuove norme per la guida e le malattie cardiovascolari, relazione del gruppo di esperti in materia di guida e di malattie cardiovascolari (New Standards for Driving and Cardiovascular Diseases, Report of the Expert Group on Driving and Cardiovascular Diseases), Bruxelles, ottobre 2013
10 GU L 403 del 30 12 2006, pag 18
11. GU L 183 del 07.07.2016, pagg. 59 63.
12. Ciro Molisso, Carlo Giorleo, Valentina Molisso: Il trapianto cardiaco in ambito valutativo medico legale Ital Heart J Suppl Vol 6 Giugno 2005: 354 360
G Med Mil 2021; 171(2): 167 172
1 7 1 1 7 1




Fa b r i z i o B u o n a c c o r s i *
Le Forze Speciali operano principalmente in scenari caratterizzati da livelli elevati di rischio fisico, nei quali non sempre è possi bile assicurare assistenza sanitaria diretta da parte di personale medico o infermieristico Per questa ragione, dal 2019, il servizio sanitario di COMSUBIN svolge un ’attività formativa finalizzata ad incrementare il livello addestrativo del personale delle Forze Speciali abilitato come “Soccorritore Militare” e del personale sanitario di supporto al comparto Forze Speciali della Difesa A tal proposito, presso il Raggruppamento Subacquei ed Incursori “Teseo Tesei” si è svolto il “Workshop Nettuno” dal 22 al 26 Marzo 2021 (in stretta aderenza ai protocolli anti COVID), organizzato dal Comando Operativo Forze Speciali (COFS) ed assegnato come lead al Gruppo Operativo Incursori (GOI): un corso esclusivo nel panorama della Medicina di Combattimento in supporto alle Operazioni Speciali della Difesa, il cui tema centrale è stato il Prolonged Field Care (PFC), ossia la stabilizzazione del ferito grave in contesto operativo, in attesa dei soccorsi avanzati e dell’assistenza medica definitiva Il COFS contribuisce direttamente da tempo alla specializzazione di operatori Forze Speciali di tutte le Forze Armate e dell’Arma dei Carabinieri inviandoli alla frequenza di specifici corsi all’estero e organizzando attività di approfondimento di alcuni giorni nelle sedi stanziali, come nella più recente presso il GOI, sia per condividere le espe rienze e best practices, anche emerse in impieghi reali, sia per avvalersi delle eccellenze sanitarie nazionali Le esperienze in campo internazionale come le attività operative stanno confermando la necessità di compe tenze sempre più specifiche per gli operatori m e d i c delle Forze Speciali per poter intervenire in soccorso di colleghi anche nel vivo dei contesti operativi, con la tempestività indispensabile per accrescere le possibi lità di sopravvivenza e di preservazione delle funzioni vitali In tal senso la Difesa ha svolto un intenso lavoro di analisi interna per giungere, di concerto con le auto rità sanitarie nazionali, al superamento degli ostacoli normativi per lo sviluppo di queste capacità A sottolineare il significato e l’importanza dell’evento e condividere le prospettive, hanno presenziato il

Gen S A N i c o l a L a n z a d e Cr i s t o f o r i s , Comandante del COFS, il Vice Ispettore Generale della Sanità Militare Brigadier Generale (CC) S e b a s t i a n o Fa l l o , l’Ammiraglio Ispettore Ri c c a r d o G u a r d u c c i , Capo del Corpo Sanitario della Marina Militare e Ispettore di Sanità e il Colonnello Fa b i o D i L i b e r a t o dell’Istituto di Perfezionamento e Addestramento in Medicina Aeronautica e Spaziale, oltre a rilevanti presenze del mondo accademico e scientifico nei settori della medi cina d’urgenza, anestesia e rianimazione ed ortopedia
Nelle prime due giornate, la dottoressa Micaela Cretella, dirigente del sistema Emergenza Urgenza della Regione Lazio, ha tenuto un corso sulla gestione avanzata delle vie aeree, anche in caso di ustioni termiche e chimiche
Nella giornata di mercoledì, i dottori Davide Battistella e Danilo Notari, operanti nell’emergenza sanitaria ligure, hanno affrontato la gestione di insufficienze respiratorie generate da eventi traumatici, quali pneu motorace, sovradistensione polmonare e trauma cranico. Gran parte della quarta giornata, è stata dedicata ad un aggiornamento delle procedure di emotrasfusione sul campo e alla gestione farmacolo gica del ferito, secondo le linee guida del Tactical Combat Casualty Care (TCCC) a cura del TV (San/Par) Gianluca Degani, medico del GOI e responsabile scientifico del Workshop, del dottor Matteo Brambati, medico specialista in Anestesia, Rianimazione e Terapia del dolore, e di un Sottufficiale US Navy Seal abilitato SOCM (Special Operation Combat Medic). Il dottor Pier Francesco Mariani, medico ortopedico traumato logo, ha illustrato la gestione di traumi ortopedici e muscolo scheletrici, con particolare focus sulla riduzione di fratture e lussazioni e utilizzo della fasciotomia nella gestione della sindrome compartimentale La fase finale del Workshop ha impegnato gli operatori in un atto tattico inerente la gestione di una mass casualty, organizzato dal dottor Alberto Andreotti, anestesista rianimatore del Centro di Forma zione Avanzata e Simulazione Medica della Facoltà di Medicina e Chirurgia di Modena (FASiM), sfruttando anche l’ausilio di un simula tore di ultima generazione fornito dall’azienda Accurate, in grado di riprodurre emergenze mediche estreme.


Hanno inoltre presenziato molte personalità di spicco del mondo accademico sanitario come la Prof ssa F l a v i a Pe t r i n i , presidente Società Italiana Anestesia, Analgesia, Rianimazione e Terapia Inten siva (SIAARTI), il Prof St e f a n o M a r i a M e z z o p e r a , del comitato tecnico scientifico del modello Italiano per la gestione del rischio in sanità e la Dott ssa Maria Luisa Simonetti, co direttrice del Corso di Perfezionamento Post Universitario in Gestione del Rischio Clinico della LUISS B u s i n e s s S c h o o l , il Prof B e g h i , consigliere scientifico della Marina Militare


disruptive technology anti COVID-19 dalla diagnosi precoce alla sicurezza degli ambienti
Roma, 30 giugno 2021 Centro Alti Studi per la Difesa Palazzo Salviati
Laricerca scientifica, il rapporto con le aziende, l’utilizzo delle risorse tecnologiche ed economiche sono stati gli argomenti al centro della conferenza organizzata dall’Ispettorato Generale della Sanità Militare dal titolo “Ricerca e S anità Militare: disruptive technology anti COVID-19 dalla diagnosi precoce alla sicurezza degli ambienti” All’evento, svoltosi il 30 Giugno 2021 presso la prestigiosa sede del Centro Alti Studi per la Difesa a Palazzo Salviati, hanno preso parte i più eminenti rappresentati del Ministero della Difesa, in primis il Ministro, oltre che vari esponenti del mondo scientifico ed industriale.
Nel salutare i convenuti l’On. Giuseppe Fioroni, Consigliere del Ministro della Difesa per la Sanità Militare, ha ringraziato il Dicastero per le importanti risorse destinate alla sanità sia per fronteggiare la pandemia che per progredire sulla strada dell’innovazione e della ricerca E che questo percorso sia attualmente prioritario è stato anche ribadito dal Gen CA Carmine Masiello, Sottocapo di Stato Maggiore della Difesa “Il binomio ricerca militare ricerca civile costituisce ormai un ’esigenza irrinunciabile” ha sottolineato il generale Allo stesso modo va considerata la stretta collaborazione tra Sanità Militare ed aziende civili “E’ necessario” ha proseguito Masiello “fare squadra dinanzi a scenari per ricercare soluzioni originali per problematiche transnazionali In questo senso del resto è stato concepito il progetto NATO per la ricerca denominato DIANA di cui l’Italia è partner” Il Ten Gen Nicola Sebastiani, Ispettore Generale della Sanità Militare, nell’introduzione ha rimarcato l’importanza dell’occasione, coro namento di una collaborazione pluriennale con le industrie della Difesa e le molteplici aziende che gravitano in questo ambito “La Sanità Militare” ha detto “è stata in prima linea nella lotta al COVID fin dall’inizio con l’attività di screening tramite i tamponi ed ha pron tamente attivato varie linee di ricerca Questo impulso ha consentito di potenziare la capacità di risposta all’emergenza Dell’aumentata

produttività e delle ricerche messe in atto già da anni ne beneficerà anche il settore operativo delle Forze Armate: ne siano esempio gli autoiniettori sviluppati in campo CBRN, i polisaccaridi e gli anticorpi” Se da un lato la Sanità Militare mira a rendere il comparto della Difesa autonomo nel settore della ricerca e produzione in campo sanitario, dall’altro è emersa quale risorsa nazionale insostituibile al fianco del Sistema Sanitario Nazio nale soprattutto nel sostegno alla medicina territoriale, ad esempio tramite la telemedicina “L’attività di ricerca del Dipartimento scientifico” ha aggiunto Sebastiani “congiunta a quella clinica del Policlinico Militare hanno consentito di fornire un ’adeguata risposta alla pandemia e costituiscono una fonte di sicurezza anche in caso di future emergenze sanitarie” . Concludendo l’Ispettore ha voluto ringraziare non solo gli appartenenti alla Sanità Mili tare, ma anche i vertici delle Forze Armate ed il Ministro che con lungimi ranza e determinazione hanno puntato su questo settore. Si è entrati a questo punto nel vivo dei lavori scientifici di cui pubblichiamo gli abstract al termine del presente articolo. Nel proprio intervento circa l’azione antivirale della luce bianca, il Dott. Mauro Pantaleo, presidente di NEXTSENSE srl, ha dichiarato che dal recu pero di precedenti esperienze di ricerca, anche in settori non sanitari, si è giunti a sviluppare metodi di disinfezione risultati utilissimi nel fronteggiare la pandemia Un percorso di sviluppo simile ha avuto AIRLITE, progetto presentato dall’Ing Massimo Bernardoni che, nel proprio intervento sul ruolo delle superfici attive, ha evidenziato i benefici provenienti dalla formazione di radicali liberi tramite semiconduttori Il successivo relatore, il Brig Gen Claudio Zanotto, Supervisore farmaceutico della Difesa, ha rimarcato che l’attività di Igesan durante la pandemia si è estesa dal fornire risorse attive in termini di uomini e mezzi all’elaborare protocolli e documenti che, soprattutto nell’iniziale fase di disorientamento, hanno costituito una reale linea guida Addentrandosi nei particolari tecnici del convegno, il generale farmacista ha esaltato le caratteristiche di prodotti quali Bioakt e Teknact che consentono alti standard di disin fezione, anche contro il COVID 19, permettendo di ridurre l’impiego di altri farmaci ed evitando pertanto la diffusione della resistenza agli antibiotici Ha preso successivamente la parola il Brig Gen Florigio Lista da anni alla guida del Dipartimento Scientifico del Poli clinico Militare di Roma, uno dei principali punti di riferimento nazionale nella lotta alla SARS 2 “Il Dipartimento è da decenni impe gnato nel campo della ricerca per fronteggiare i pericoli provenienti dalle minacce CBRN e dai patogeni inusuali sia con apposite linee di ricerca sia con attività di testing” ha detto Lista Questo impegno ha condotto allo sviluppo dei bionsensori per la rilevazione dell’antrace e del botulino e, più recentemente, alla creazione dei kit salivari per l’individuazione del COVID, nonché alla validazione dei metodi di disinfezione descritti dagli altri relatori “Questi successi” ha aggiunto il ricercatore “ sono anche frutto di importanti e consolidate collaborazioni con le principali istituzioni scientifiche italiane ed internazionali” Al termine dei lavori propriamente scientifici il Prof Francesco Riva, consigliere del CNEL, ha esposto il progetto di mutuare l’esperienza di monitoraggio della diffusione del COVID tramite i test salivari anche ad altre infezioni tra cui quella da HPV appare promettente Nella conclusione dei lavori il ministro della Difesa, On Lorenzo Guerini, ha voluto testimoniare il grande lavoro svolto da tutte le Forze Armate ed ha ringraziato il Gen. CA Francesco Figliuolo, Commissario straordinario per l’emergenza COVID ed il Gen. CA Luciano Portolano, Comandante del COI, entrambi presenti in sala, per gli ottimi risultati raggiunti. Il Ministro ha anche messo in evidenza come l’intero Paese abbia apprezzato l’impegno della Difesa e della Sanità Militare in particolare: “La Sanità Militare ha contribuito nel fronteggiare l’emergenza sanitaria ed ha incrementato la resilienza del Paese”. “Siamo stati la prima democrazia liberale a confron tarsi con il COVID e le scelte da noi fatte per contrastare il diffondersi dell’epidemia sono state prese a modello da altri Paesi” ha aggiunto il Ministro. Al termine Guerini ha confermato la pianificazione di ingenti investimenti e risorse nella lotta alla pandemia di cui molti destinati alla Sanità militare ed alla ricerca che saranno impiegati senza ritardi. Un momento di incontro “epocale” che, oltre al doveroso tributo da parte delle Autorità intervenute alla Sanità Militare, ha anche consentito di tirare le somme sui binomi che da anni perseguono le Forze Armate con l’indirizzo di IGESAN: ricerca ed attività sul campo, programmazione ed esecuzione, istituzione militare e mondo produttivo civile

2021; 171(2): 173 190

Infezioni, pandemie e antibioticoresistenza l’efficacia delle frequenze della luce visibile non UV su batteri e virus
Dott. Maur o PANTALEO
Presidente e Amministratore Delegato di Nextsense S.r.l.
In quattro mesi, COVID 19 ha trasformato il mondo Migliaia di morti, l’intera popolazione mondiale in quarantena e perdite economiche quantificabili a livello globale in trilioni di dollari Sono molte le lezioni che abbiamo appreso nell’ultimo anno ma quella che può essere sicuramente considerata la più importante è che la globalizzazione non porta solo vantaggi ma anche oneri pesanti che richiedono interventi adeguati: le principali emergenze globali dal cambiamento climatico alla resistenza antibiotica sono anch’esse condivise ed interconnesse e richiedono, quindi, la necessità di intervenire con uguale sforzo in tutti i Paesi, soprattutto in quelli in via di sviluppo
La continua interazione tra esseri umani, il mancato rispetto degli spazi che la natura ha concesso a tutti gli abitanti della Terra, la deforestazione, la sovrappopolazione hanno determinato un rapporto stretto ma malato tra gli esseri umani e la natura che ha creato le condizioni ideali che consentono a nuovi e finora sconosciuti agenti patogeni di passare dagli animali agli esseri umani con il fenomeno ormai noto dello spillover
Tutto questo ha determinato l’inizio di una nuova era che è oramai tristemente nota come l’era pandemica
Non dobbiamo dunque stupirci se si verificherà di nuovo Ci sono centinaia di virus negli animali che sono pronti a “saltare” nell’es sere umano (si pensi solo all’influenza aviaria H5N8) e quando questo avverrà si potrebbe verificare una pandemia influenzale persino molto più grave di quella che stiamo vivendo
E questo, anche se con diversi meccanismi, non vale solo per i virus ma anche per una pandemia che ci accompagna da molti anni ma che, non avendo ancora avuto lo stesso impatto del Sars Cov2, è nota come “pandemia silente”.

Ben prima del COVID, infatti, l’epidemia del XXI secolo era considerata e lo è ancora la “resistenza antibiotica”: un processo di mutazione genetica dei batteri che li porta a sviluppare una sorta di immunità rispetto agli antibiotici Gli antibiotici hanno rappresentato sicuramente una delle più importanti scoperte sanitarie del secolo passato tanto che Fleming, inventore nel 1928 della penicillina che è stata il primo antibiotico ad ampio spettro, è stato insignito nel 1945 del premio Nobel per l’enorme impatto che la sua invenzione avrebbe avuto per la sanità pubblica (in verità, la scoperta sul potere battericida delle muffe è da attribuire a un Medico del Corpo Sanitario della Marina Militare Italiana, Dott Vincenzo Tiberio, che già nel 1895 aveva pubblicato sulla rivista Annali di Igiene Sperimentale un articolo con i risultati delle sue sperimentazioni)
Con la penicillina di Fleming e con la prima guarigione da una grave infezione di una infermiera del Connecticut nel 1942, inizia la c d “ era antibiotica”.
Da quel momento si cominciò a pensare che l’umanità non avrebbe più problemi a causa delle infezioni batteriche perché si sarebbe trovato sempre un antibiotico adatto, più potente, più efficace. Ma negli anni successivi il loro uso smodato (soprattutto in Italia che è al secondo posto in Europa dopo Cipro per i morti da resistenza antibiotica) ha consentito ai batteri di conoscere meglio il loro nemico e di sviluppare mutazioni genetiche che li rendono immuni All’inizio degli anni ’80, quindi, l’inizio della resistenza antibiotica ha dato avvio alla c d “ era post antibiotica”
A differenza del COVID19, la “resistenza antibiotica” non è stata mai percepita come una minaccia globale nonostante i numerosi allarmi lanciati dall’OMS che l’ha classificata come “l’Epidemia del XXI secolo” e ha lanciato nel 2017 l’Antimicrobial Resistance
Campaign, diffondendo dati che fanno impallidire anche se paragonati a quelli del COVID: senza soluzioni efficaci, il numero dei morti da resistenza antibiotica cresceranno ogni anno fino a toccare nel 2050 la cifra di 10 milioni all’anno.
Il problema è che i batteri non solo diventano resistenti, ma sono anche in grado di trasmettere la resistenza alle future popolazioni batteriche E questo significa che la popolazione dei batteri resistenti cresce in maniera talmente veloce che possiamo prendere infe zioni da patogeni resistenti nei luoghi di vita comune dai mezzi di trasporto, ai luoghi di lavoro e di svago, alla scuola.
Finora il problema sembrava relegato agli ambienti ospedalieri dove, soprattutto in Italia, la probabilità per un paziente di acquisire infezioni durante i ricoveri ospedalieri o in seguito a trapianti, ricovero in terapia intensiva o interventi chirurgici complessi diventa sempre più alta E il “rischio italiano” è un problema percepito a livello europeo tanto che in alcuni Paesi europei, al momento del rico vero, i pazienti che hanno avuto contatti con ospedali italiani nei sei mesi precedenti vengono sottoposti a screening e immediata mente isolati.
Il problema dei batteri resistenti ha assunto un ruolo importante anche durante la pandemia virale in quanto molti scienziati hanno sollevato il dubbio che l’anomala mortalità italiana da Coronavirus sia da attribuire ai super batteri presenti negli ospedali che hanno assunto maggiore aggressività a causa della maggiore vulnerabilità dei sistemi immunitari come conseguenza del Coronavirus. Può sembrare strano concentrarsi sui batteri durante una pandemia virale ma è da considerare che già durante la pandemia influenzale globale del 1918 1920 gran parte pazienti sono morti non per il virus stesso, ma per le polmoniti batteriche secondarie che si sono diffuse facilmente nei reparti ospedalieri affollati tra i malati spesso malnutriti e immunodepressi
E il problema è sicuramente aggravato da due fattori: gli antibiotici esistenti sono ormai inefficaci sui microrganismi per i quali erano stati prodotti e le aziende farmaceutiche hanno smesso di investire nella ricerca di nuove molecole antibiotiche a causa del breve ciclo di vita che le rende poco redditizie

Il dibattito sulla pandemia, soprattutto negli ultimi tempi, si è spostato su un argomento a mio parere poco rilevante se si guarda in prospettiva: non è importante se questo virus si trasmetta di più via aerosol o a seguito di contatto con le superfici perché ce ne saranno altri che avranno diverse modalità di trasmissione contro le quali dovremo essere preparati Occorre trovare, quindi, nuove soluzioni E se per i virus la scoperta del vaccino “universale” può rappresentare una soluzione (se e quando arriverà) per le infezioni batteriche sembra chiaro che la soluzione non possa essere cercata in antibiotici sempre più potenti ma va cercata in nuove forme di preven zione che siano più compatibili con le normali condizioni di vita quotidiana e che siano auspicabilmente efficaci sia sui virus che sui batteri.
La nuova frontiera si è spostata verso la creazione, soprattutto negli ospedali, di “ambienti biosafe” che riducano la presenza di agenti patogeni e riducano il rischio di acquisizione e trasmissione di infezioni batteriche e virali E, complice la pandemia, sembra ormai pacifico che la bio sicurezza diventerà uno standard anche negli ambienti di vita quotidiana. Ed è ormai chiaro che “bio sicurezza” non può essere la distruzione di tutti i microbi (soprattutto batteri) esistenti con l’uso massiccio di detergenti chimici e sistemi di sanificazione invasivi perché i batteri sono fondamentali per la nostra sopravvivenza La pandemia ci ha costretti a considerarli nemici ma arriverà presto il momento in cui dovremo tornare a vivere insieme a loro in maniera equi librata
Anche per questo motivo, durante la pandemia la ricerca scientifica “ non emergenziale” si è concentrata su nuovi sistemi di sanifica zione continua in grado di creare ambienti in cui tutti gli esseri viventi e i microbi possano vivere insieme realizzando quell’ecosi stema in cui l’equilibrio è l’elemento fondante del benessere generale
I principi su cui secondo l’OMS deve essere basata una corretta sanificazione ambientali sono: 1. Evitare la sterilizzazione degli ambienti, poiché l’eliminazione completa delle popolazioni di microorganismi comporta l’annulla mento del sistema immunitario
2021; 171(2): 173 190
2 Ridurre il rischio di ricontaminazione, che è quanto avviene quando una popolazione microbica potenzialmente patogena si riat tiva in ambienti precedentemente trattati con sistemi di decontaminazione UV C o con disinfettanti chimici
3 Rispettare le condizioni di antagonismo competitivo tra i microorganismi, che si ottiene non eliminando tutti i microrganismi in modo incontrollato, ma mirando prevalentemente ai microorganismi patogeni mentre viene tutelata la creazione di colonie stabili di "probiotici"

4 Contrastare il fenomeno del "resistoma", ossia bloccare la diffusione di quei gruppi di geni che, attraverso lo scambio tra micror ganismi, consentono l'acquisizione di informazioni genetiche in grado di far sviluppare nei microorganismi stessi la resistenza agli antibiotici e ai disinfettanti chimici
Tra i sistemi che sembrano avere prospettive più promettenti in tal senso vanno sicuramente annoverati quelli che utilizzano la “luce sanificante”
La luce come sanificante non può essere considerata una vera e propria scoperta scientifica in quanto il sole è da sempre lo “stru mento” sanificante per eccellenza
Già alla fine dell’‘800 Niels Ryberg Finsen, Nobel per la Medicina nel 1903, aveva scoperto che il vaiolo poteva essere trattato con l’uti lizzo dei raggi infrarossi, sviluppando la sua successiva ricerca per il trattamento del lupus vulgaris (malattia da cui era affetto) utiliz zando la luce del sole filtrata.
In sintesi, partendo da una percezione di maggior forza e miglioramento della sua malattia e della sua salute in generale a seguito dell’e sposizione alla luce del sole, Finsen riuscì a dimostrare che tali effetti benefici potevano essere rilevati anche negli animali In partico lare, attribuì queste particolari capacità ai raggi azzurri e violetti Finsen si concentrò anche su un altro aspetto molto importante della luce, ovvero la proprietà di essere battericida, arrivando alla conclusione che il 95% dell'azione battericida della luce deriva dai raggi azzurri, violetti e ultravioletti Da qui lo sviluppo di uno per primi sistemi di fototerapia per la cura delle affezioni cutanee superficiali, localizzate e parassitarie, tra le quali in special modo del lupus vulgaris su cui erano ovviamente concentrate le sue attenzioni I limiti dei raggi ultravioletti erano già noti a Finsen che aveva capito che per essere sensibili alle loro proprietà i microbi devono essere isolati da sostanze protettrici e per cui la loro resistenza aumenta notevolmente se presenti in un ambiento vivo e, soprattutto, che le infiammazioni provocate alla pelle sana da tali radiazioni potevano essere molto pericolose È anche per questo motivo che i raggi ultravioletti sono classificati in tutto il mondo come cancerogeni di Gruppo 1 e pericolosi per le infiammazioni che provocano all’apparato visivo
Contemporaneamente a Finsen, lo scienziato svizzero Jacques Louis Sorèt aveva avviato i suoi studi sulla sensibilità dei batteri alla luce riuscendo ad individuare il picco di massimo assorbimento delle porfirine batteriche all’interno del range di frequenze dello spettro visibile (non UV) tra 400 420nm Tale banda, in onore del suo scopritore, è stata denominata Banda di Soret
Gli studi di Sorèt sono rimasti lettera morta per molti anni per svariati motivi: sicuramente perché le tecnologie allora esistenti non consentivano di isolare in maniera efficace le frequenze dello spettro visibile tanto che per isolare gli ultravioletti Finsen aveva utiliz zato il metodo utilizzato dai fotografi per filtrare con i vetri rossi le lastre fotografiche. E poi perché il Nobel a Finsen spostò l’atten zione sulle frequenze dell’ultravioletto, in particolare gli UV C, che erano considerate sicuramente più efficaci.
Inoltre, la scoperta della penicillina ad opera di Fleming nel 1928 aveva generato la convinzione che gli antibiotici sarebbero stati la definitiva soluzione delle infezioni batteriche
Gli studi di Sorèt sono stati ripresi in una pubblicazione del 1954 (Shibata et al ) che analizzava gli spettri di assorbimento di alcuni microrganismi attraverso l'uso di filtri opalescenti, evidenziando come quasi tutti i picchi massimi di assorbimento fossero posizio nati in un quartiere di 400nm
Un successivo studio del 2010 dell'Università israeliana di Ramat Gan (Lubart et al ) ha condotto un 'analisi delle innumerevoli ricerche che avevano, con tecniche diverse, dimostrato la capacità di eradicazione batterica attraverso l'emissione di radiazioni lumi nose entro intervalli praticamente coincidenti con lo studio di Shibata et al
G Med Mil 2021; 171(2): 173 190
1 7 9 1 7 9
La scoperta dei diodi led nei primi anni 2000 ha consentito di realizzare i primi dispositivi che emettono frequenze dello spettro visi bile Grazie a ciò, l'Università scozzese di Strathclyde, dopo aver effettuato approfonditi test e ricerche sulla disinfezione della luce visibile, ha sviluppato i propri dispositivi di disinfezione a frequenza singola che sono in uso dal 2008 presso la Glasgow Royal Infir mary, un ospedale didattico gestito dal National Health Service Dal 2008, tale tecnologia e la sua efficacia sono state oggetto di decine di pubblicazioni accademiche in peer review e altrettante presentazioni in convegni e conferenze Tutte le ricerche, tuttavia, si concentravano esclusivamente su picchi di potenza ristretti, ignorando l'ampio spettro di assorbimento che i microrganismi hanno dimostrato di possedere
I batteri infatti, come già dimostrato da Sorèt, hanno dimostrato una sensibilità a tutte le frequenze del visibile grazie ai diversi picchi di assorbimento delle porfirine batteriche e, più in generale, dei foto sensibilizzatori cellulari endogeni, come citocromi, flavine e NADH, in grado di innescare una reazione metabolica incontrollata che è in grado di portare rapidamente alla definitiva eradicazione dei microrganismi irradiati dalla luce, siano essi batteri, virus, spore o muffe batteriche.
L’efficacia sui batteri delle frequenze dello spettro visibile, oltre ad essere ormai scientificamente acclarata e certificata dalle nume rose pubblicazioni scientifiche, è stata oggetto di specifiche sperimentazioni, in vivo e in vitro, effettuata da qualificati laboratori indi pendenti.
L’efficacia sui virus può essere considerata una scoperta abbastanza recente il cui merito va attribuito al Dipartimento Scientifico del Policlinico Militare Celio che, in collaborazione con l’Istituto Superiore di Sanità (ISS), ha condotto i primi test sul Sars Cov2 e su altri virus utilizzato un dispositivo fornito da Nextsense basato sulla tecnologia Biovitae® che è l’unica al mondo che utilizza una combi nazione di frequenze tra 400 420nm con un picco intorno a 413nm efficace su virus e batteri (coperta da due brevetti internazionali depositati nel 2016)
I test di efficacia sul SARS Cov2 sono stati effettuati nel pieno della pandemia COVID 19 con cicli di sperimentazione replicati che hanno valutato la capacità della tecnologia BIOVITAE di eradicare sia il SARS Cov 2 sia altre specie virali (tra i quali il virus febbre gialla ed il virus influenzale).

I risultati, che sono stati pubblicati in preprint sulla rivista MedRxiv nel giugno 2020, hanno eviden ziato la capacità di BIOVITAE di ridurre fino al 99,8% del SARS CoV 2 in meno di un ’ ora a seguito di esposizione alla luce di Biovitae (Fig 1) Il secondo ciclo di test è iniziato immediatamente dopo la pubblicazione del primo articolo e ha visto il coinvolgimento, oltre al Dipartimento Scientifico del Policlinico Militare Celio in qualità di coordinatore, dei Dipartimenti Scientifici delle Sanità Militari di Svezia e Germania (tutti membri dell’EU Biodefense Laboratories Network (https://globalbiodefense com) e dell’Università la Sapienza di Roma Tutti gli esperimenti si sono conclusi con pari risultati di efficacia e gli esiti saranno pubblicati a breve su una rivista in peer review O l t r e a i v a r i s t u d i c o n d o t t i s u c c e s s i v a m e n t e u t i l i z z a n d o l a t e c n o l o g i a B I OV I TA E d a d i v e r s i l a b o r a t o r i ( s i c i t a n o s o l o i l Commissariato per l’Energia Atomica e le Energie Alternative CEA in Francia e il Centro Internazionale per l’Ingegneria
2021; 171(2): 173 190
Fig 1 Piastre di Petri utilizzate nel test con Biovitae
G e n e t i c a e l e B i o t e c n o l o g i e I CG E B d i Tr i e s t e ) , u n a m e n z i o n e m e r i t a l a r e c e n t e r i c e r c a i n d i p e n d e n t e d e l l a Icahn School of Medicine del Monte Sinai che ha confermato l ' e f f i c a c i a d e l l e f r e q u e n z e d e l l o s p e t t r o d i B I OV I TA E s u l SARS CoV 2 e altri virus
Lo studio pubblicato in preprint su BioRxiv con il titolo “ L i g h t i n g a b e t t e r f u t u r e : t h e v i r u c i d a l e f f e c t s o f 4 0 5 n m v i s i b l e l i g h t o n S A R S C o V 2 a n d i n f l u e n z a A v i r u s ” riporta i risultati dei test effettuati utilizzando uno l'intero spettro visibile tra 380 e 780nm, con un massimo picco nell’inter vallo 400 420nm che viene riportato in figura 2 Tale spettro coincide con quello utilizzato dal Dipartimento Scientifico militare italiano nel corso del suo esperimento che viene riportato nella figura 3 Si tratta di un importante riconoscimento per il Dipartimento scientifico del Policlinico Militare Celio di Roma, che è stato il primo al mondo a fare questa scoperta e a pubblicare i risul tati della propria ricerca nel giugno 2020 su MedRxiv Volendo dare una rappresentazione immediata dell’impor tanza della scoperta è sufficiente analizzare i risultati dei test sul SARS Cov2 effettuati utilizzando uno l'intero spettro visi bile sopra 400nm sia con tecnologia BIOVITAE (CELIO e CEA) sia con altri dispositivi che emettono lo stesso spettro di frequenze (ICAHN MOUNT SINAI) che, in sintesi, vengono riportati nella tabella 1
Fig. 2 Normalized spectral distribution from the study of the Icahn School of Medicine, posted on BioRxiv on April 20, 2021

Mt. Sinai
Fig. 3 Normalized spectral distribution from the TÜV Rheinland test report of January 22, 2021, as made available to

Tabella relativa ai test effettuati sul SARS Cov2 con spettro BIOVITAE
Organism
Medium Irrad. (mW/cm2) Time (hours) Time (minutes) Results
SARS Cov2 PBS (Saline) 0 035 4 N/A 55 08% 24 90 17%
Mt. Sinai SARS Cov2 Ar tificial Saliva 0 076 24 N/A 98 22%
Mt. Sinai SARS Cov2 PBS (Saline) 0 15 4 N/A 63,64% 24 96,21%
Mt. Sinai SARS Cov2 PBS (Saline) 0 6 1 N/A 71 52% 8 99 74%
CELIO SARS Cov2 gMEM 4 67 N/A 15 93 25
CELIO SARS Cov2 gMEM 4 67 N/A 30 97 94
CELIO SARS Cov2 gMEM 4 67 N/A 45 99 31
CELIO SARS Cov2 gMEM 4 67 N/A 60 99 64
CEA SARS Cov2 TNE buf fer +0 3g/L BSA 1 04 N/A 30 57 34
CEA SARS Cov2 TNE buf fer +0 3g/L BSA 1 04 N/A 60 98 30
CEA SARS Cov2 TNE buf fer +0 3g/L BSA 1 04 N/A 90 98 65

Può essere la luce una tecnologia disruptive per contrastare le infezioni virali e batteriche?
Quali sono le prospettive dopo la pandemia?
Sicuramente la scienza mette a disposizione molti più strumenti rispetto a quelli del passato: nonostante i limiti e le preoccupazioni legate ai ridotti tempi di sperimentazione e alla reale efficacia, la velocità di realizzare vaccini in così poco tempo rappresenta sicu ramente una risorsa rilevante in quanto consente di rispondere con ancora maggior rapidità rispetto a quanto avvenuto con Sars CoV 2 Ma non possiamo permetterci di avere milioni di morti all’anno per ogni nuova pandemia e occorre quindi investire in stru menti che ci consentano di convivere in maniera meno pericolosa con le nuove malattie infettive.
Rafforzare i sistemi sanitari, istruire i Governi dei Paesi in via di sviluppo ad affrontare le emergenze sanitarie in maniera adeguata non risponde più quindi solo a scopi solidaristici, come finora abbiamo pensato, ma è un ’esigenza globale perché anche da questo dipende la salvaguardia del Pianeta e la salute di tutta la popolazione mondiale Perché è ormai evidente che non è vero che ogni Stato è un mondo a parte ma tutti gli Stati sono parte del mondo e il Pianeta è la casa di tutti
La ripresa di controllo della situazione dipenderà dalla nostra capacità di modellare e implementare misure efficaci che vadano oltre il distanziamento fisico (il cui impatto a livello economico non potrebbe essere retto) e riguardino soprattutto sistemi di prevenzione “ meno invasivi” e, ovviamente, sistemi di diagnostica rapida e terapie efficaci. Non possiamo prevedere quale direzione prenderà il mondo una volta usciti dall’emergenza ma sembra ormai chiaro che cambie ranno totalmente i paradigmi e gli standard della sicurezza sanitaria all’interno degli ambienti non solo sanitari ma anche negli uffici, scuole e abitazioni private in cui la sanificazione continua diventerà uno standard importante quanto l’illuminazione E proprio la luce sanificante che utilizza frequenze dello spettro visi bili non UV (e quindi non dannosa per gli esseri viventi) potrà rappre sentare lo strumento più efficace di sanificazione continua in quanto è già utilizzata tutti i giorni negli ambienti di vita quotidiana e può garantire il controllo della carica microbica quando sono presenti i principali vettori dei microrganismi: gli esseri umani L’utilizzo più immediato è ovviamente il general lighting degli edifici ma altre applicazioni specifiche possono essere progettate per garantire sanificazioni più approfondite, se necessario E se prima della pandemia il segmento più interessato poteva sembrare essere quello delle strutture sanitarie ora è chiaro che il problema riguarda anche le aziende che hanno bisogno di riprendere in sicu rezza le attività economiche, le scuole ma anche i privati, segno che il bisogno di protezione non è solo legato al business ma sta diventando un ’esigenza sentita e diffusa E gli ambienti militari rappresentano sicuramente quelli che più hanno bisogno di questi sistemi in quanto lo svolgimento delle ordinarie attività comporta inevitabilmente assembramenti e contatti continui tra persone di diversa provenienza, soprattutto in occasione delle missioni internazionali

Ad oggi sul mercato solo la tecnologia BIOVITAE è in grado di offrire una tecnologia brevettata che utilizza una combinazione di frequenze dello spettro visibile tra 400 420nm (Banda di Soret) (con un picco intorno a 413nm) che è stata testata efficace su tutti i batteri e virus in quanto provoca un danno alla membrana dei batteri e al capside virale attraverso un processo di perossidazione. È evidente che BIOVITAE può rappresentare una tecnologia disruptive per contribuire alla ripresa in sicurezza delle attività post pandemia e per contrastare gli effetti delle infezioni virali e batteriche

In Italia si vendono circa 100 milioni di lampadine (oltre ovviamente a tutti gli altri dispositivi luminosi di altra forma), pensiamo possa essere un ’evoluzione logica e naturale quella di una loro progressiva sostituzione con sistemi di luce sanificante anche perché è una soluzione plug and play che, oltre ad inserirsi nella transizione in corso già iniziata da qualche anno per la
2021; 171(2): 173 190
progressiva sostituzione delle datate tecnologie alogene e incandescente con la tecnologia LED per la sua maggiore efficienza dal punto di vista energetico, non necessita di alcuna installazione specialistica ed è quindi ad immediata fruibilità Biovitae risponde alla nuova domanda generata da una maggiore consapevolezza del rischio di infezioni virali e batteriche la cui prevenzione sarà uno dei settori su cui si concentreranno le maggiori risorse negli anni a venire La forza di questa tecnologia sta anche nel suo essere un “change without change” : rappresenta un’innovazione assoluta nel campo delle infezioni batteriche e virali senza richiedere alcun adattamento o cambio di abitudine: per proteggersi, infatti, basta accendere la luce.

Dr. Fr a n c e s c o R i v a , MD, DDS
Consigliere CNEL (Consiglio Nazionale dell’Economia e del Lavoro)
Ogni anno in Italia le nuove diagnosi di tumori legati alla presenza del Papilloma Virus sono oltre 6 mila. Il totale dei costi diretti associati con i casi di patologie HPV correlate è di oltre 500 milioni di Euro ogni anno in Italia. L’OMS e la European Cancer Organisation hanno lanciato una call to action per eradicare i tumori legati all’HPV attraverso l’immuniz zazione, la diagnosi precoce con test all’avanguardia, le cure tempestive Ma l’informazione è ancora troppo scarsa I tumori legati all’HPV non riguardano solo l’area genitale o la cervice uterina Sono anche i tumori del distretto testa collo Il virus HPV Papilloma Umano è responsabile di numerosi tumori, fra cui tumore della cervice uterina, pene, ano, vagina, vulva, cavità orale lingua, bocca, tonsille e orofaringe. Oggi è possibile mettere in campo le armi della prevenzione primaria grazie al vaccino per ragazze e ragazzi, e secondaria con la diagnosi precoce, ma deve essere aumentata l’adesione da parte della popolazione e l’infor

mazione al riguardo Infatti solo il 60% delle ragazze che rientrano nel target primario del programma di immunizzazione risulta protetto contro i tumori correlati all’HPV ed è ancora troppo basso il numero di donne che esegue il Pap test o HPV DNA Test aderendo ai programmi di screening organizzati nelle diverse regioni Ancora più bassa è l’informazione e la conoscenza dei tumori HPV correlati del distretto testa collo e le visite periodiche per la diagnosi precoce in campo odontostomatologico e otorinolaringoia trico sono pressoché nulle Ogni anno in Italia le nuove diagnosi di tumori legati alla presenza del Papillomavirus sono oltre 6 mila e il totale dei costi diretti asso ciati con i casi di patologie HPV correlate è stimato in oltre 500 milioni di Euro annui, dato a rischio di ulteriore crescita per il ritardo diagnostico e il calo delle immunizzazioni a causa della pandemia da COVID 19 Nel 2020 l’OMS ed ECCO European Cancer Organisation hanno lanciato una call to action con l’obiettivo ambizioso di eliminare il cancro della cervice uterina e tutti gli altri HPV correlati entro il 2030, ed è importante sviluppare una sinergia fra specialisti diversi per creare una rete organizzativa in grado di alzare la soglia di informazione della popolazione, di diffondere in modo capillare controlli e test mirati e di rendere concreta una più stretta collaborazione in fase diagnostico terapeutica fra gli specialisti.
Per questo nasce il progetto “HPV BOARD: UN FUTURO SENZA PAPILLOMAVIRUS”, promosso da Francesco Riva Consigliere CNEL con il Patrocinio dell’ Ispettorato Generale Sanità Militare, del C O C I Cenacolo Odontostomatologico del Centro Italia, della SIOCMF Società Italiana di Odontostomatologia e Chirurgia Maxillo facciale e della SIO ChCF Società Italiana di Otorinolaringoiatria e Chirurgia Cervico facciale Media partner Medicina e Informazione Web Tv
Un progetto che vede attori principali le figure dell’otorinolaringoiatra, dell’odontoiatra e del chirurgo maxillo facciale in stretta sinergia con altri specialisti per alzare la soglia di attenzione dei clinici e coinvolgere la popolazione sul valore della vaccinazione e dei nuovi strumenti diagnostici per sconfiggere i tumori del testa collo HPV correlati L’obiettivo è quello di unire intenti, competenze e iniziative al fine di promuovere progetti di prevenzione primaria, diagnosi precoce e terapie adeguate.
Ad oggi non esiste un test standardizzato che consenta di individuare precocemente la presenza di Papillomavirus nel cavo orale Poter individuare i soggetti positivi per la presenza di HPV consentirebbe di avviare dei programmi personalizzati di monitoraggio
Basandosi sull’esperienza e sulle risorse messe in campo contro la Pandemia da COVID 19, che hanno permesso di mettere a punto dei test antigenici affidabili, rapidi e a costo contenuto, si è pensato di stimolare la comunità scientifica e l’industria per rendere disponibili test antigenici in grado di identificare la presenza di altri virus nella saliva, uno su tutti l’HPV
La ricerca all’avanguardia tutta italiana di Technogenetics ha permesso di sviluppare un test colorimetrico rapido in grado di trovare il SARS CoV 2 nella saliva. Con la stessa tecnologia utilizzata per la lotta al COVID si potrà trovare la presenza del Papillomavirus nella saliva e l’azienda è già in fase avanzata di sperimentazione per rendere disponibili nelle prossime settimane test di ultima genera zione che cambieranno l’approccio diagnostico alle patologie HPV relate.

La call to action di OMS ed ECCO è un ’occasione unica per cambiare per sempre la storia naturale di alcune neoplasie che in futuro potrebbero scomparire
Essere promotori e parte attiva di questo progetto come clinici, come istituzioni, come divulgatori e come aziende è un gesto di responsabilità sociale in cui far confluire energie e sinergie
Gli specialisti del distretto cervico facciale e testa collo vogliono contribuire cambiando la cultura della prevenzione e della diagnosi precoce grazie a test innovativi e non invasivi che possono diventare parte centrale nelle nuove strategie di contrasto ai tumori del testa collo legati all’HPV
Il progetto HPV Board è stato presentato in anteprima al CNEL il 22 Aprile 2021 e successivamente nel corso della Conferenza Scien tifica “RICERCA e SANITÀ MILITARE: disruptive Technologie anti COVID 19 dalla diagnosi precoce alla sicurezza degli ambienti” promossa dall’ISPETTORATO GENERALE
Mil 2021; 171(2): 173 190
Ing. M a s s i m o B e r n a r d o n i
Co fondatore e Direttore Ricerca e Sviluppo Airlite
L'esperienza che stiamo vivendo con la pandemia da Sars Cov2, ha messo in risalto cosa vuol dire il benessere e la sicurezza all'in terno degli edifici Parleremo quindi di come le superfici attive, possano aiutare al rilancio nel post Covid 19 e aiutino a prevenire altri tipi di pandemie
Parleremo di Airlite

Airlite è una tecnologia a semiconduttore, inserita all'interno di uno dei prodotti più semplici e diffusi: una pittura Abbiamo creato un prodotto minerale, completamente privo di derivati dal petrolio, che è in grado di eliminare ogni batterio testato, anche quelli antibiotico resistenti, i virus, compreso il Sars Cov2, oltre a ridurre in maniera importante gli inquinanti gassosi presenti nell'aria, prodotti da traffico veicolare, riscaldamenti domestici e industrie, quali gli ossidi di azoto, di zolfo ed i VOC (compresa la Formaldeide)
La tecnologia si rifà agli studi condotti dagli scienziati giapponesi Fujishima e Honda, in cui scoprirono il ruolo svolto da un minerale, il biossido di Titanio, nella decomposizione dell'acqua in presenza di luce di una certa frequenza Tali studi, avevano come obiettivo applicazioni in campo energetico, legate soprattutto alla produzione di idrogeno
Gli studi che hanno portato alla realizzazione di Airlite hanno inizio circa 20 anni fa, con lo scopo do cercare di realizzare un prodotto, di facile applicazione, che riguardasse ampie superfici e che avesse un costo il più possibile contenuto, per combattere l'inquinamento dell'aria Tale inquinamento lo suddividiamo in tre macro aree:
• il primo di origine fisica concerne soprattutto il particolato atmosferico.
• il secondo di origine chimica, abbraccia soprattutto i gas di combustione (NOx, SOx, VOC)

• il terzo di origine biologica, contiene muffe, spore, lieviti, batteri e virus L'inquinamento atmosferico è causa di circa 500 000 morti l'anno solamente nella UE Quasi mai si prende in considerazione il costo economico derivante da questo aspetto. Ricordo che in Europa, il costo medio per citta dino è di 1.276/euro/anno, mentre in Italia questa cifra sale a 1.535, con punte di 2.800 nella zona di Milano. Come funziona la tecnologia:
La fotocatalisi è definita come l’accelerazione della velocità di una fotoreazione per la presenza di un catalizzatore (biossido di Titanio) Infatti, l’ossidazione della maggior parte degli idrocarburi procederebbe piuttosto lentamente in assenza di sostanze attive catalitiche Un fotocatalizzatore diminuisce l’energia di attivazione di una data reazione, cioè serve meno energia perchè essa avvenga Dall’espo sizione di Airlite alla luce, vengono generati degli stati eccitati capaci di iniziare processi a catena come le reazioni redox e le trasforma zioni molecolari
I gruppo ossidanti che vengono prodotti (gruppi ROS) sono particelle fortemente reat tive, in grado di poter ossidare materiali orga nici che, nel caso degli inquinanti gassosi, si trasformano alla fine in sali a base di calcio.
Una fortissima attività igienizzante si veri fica sulla superficie di Airlite, sia contro le muffe, batteri e virus
ll meccanismo di decomposizione comporta il degrado della parete cellu lare e della membrana citoplasmatica, sempre a causa della produzione di specie reattive dell'ossigeno (ROS), come •O2 , OH H2O2 •HO2
Questo inizialmente porta alla fuoriuscita del contenuto cellulare, quindi alla lisi cellulare e fino ad una completa minera lizzazione dell'organismo
In tutti i test effettuati, Airlite si comporta in modo aspecifico, è in grado cioè di eliminare qualsiasi ceppo batte rico o virale, indipendentemente dalla variante o mutazione test di questo genere sono stati effettuati in vari laboratori universitari e in più paesi di continenti diversi, riportando sempre gli stessi identici risultati Nel mese di aprile di quest'anno, siamo entrati in contatto con la Direzione Sanitaria Militare del Celio, e più precisamente con il Generale Sebastiani Illustrando le caratte ristiche di Airlite e le prove fini ad allora realizzate, l'Ispettore Generale ha intuito la potenzialità di Airlite come strumento di preven zione, autorizzando la realizzazione di uno studio volto a verificare l'effettiva capacità del nostro prodotto di eliminare il Sars Cov2. Questo chiaramente era possibile vista la disponibilità di laboratori con classe di sicurezza 3 (BSL3). I test sono durati circa tre mesi, durante i quali è stato messo a punto un metodo per verificarne l'efficacia

Le prove prevedevano lo studio su un vetro semplice, un vetro con sopra applicata una pittura tradizionale e un vetro con sopra appli cata Airlite
I campioni sono stati messi sonno una lampada UVA per circa un ' ora, poi la lampada è stata spenta, e dopo 10 minuti è stato messo super ficialmente il liquido surnatante contenente il virus e dopo 15 minuti di attesa illiquido è stato aspirato e si è effettuata la conta virale Il risultato è stato che nel vetrino ricoperto con la pittura standard abbiamo riscontrato una diminuzione del virus dell'1,60%, mentre in quello ricoperto con Airlite abbiamo riscontrato una diminuzione del Sars Cov2 dell'89%. Precedentemente avevamo effettuato delle prove con vari Istituti Universitari, fra i quali l'Università La Sapienza di Roma, dove la ricerca ha avuto come oggetto il virus H1N1

I risultati ottenuti nello studio della Sapienza, hanno mostrato che il contatto (60’) con la vernice AIRLITE riduce del 74% l’infettività del virus influenzale A H1N1
Inoltre dall’analisi della vitalità cellulare, si evince cha le superfici verniciate con AIRLITE non rilasciano componenti tossici per le cellule Abbiamo fatto moltissimi studi sull'effi cacia del prodotto nei confronti dei batteri. Ne abbiamo testato una quindi cina, anche qui in vari laboratori utiliz zando anche quelli antibiotico resistenti come lo Staphylococcus Aureus MRSA Il
2021; 171(2): 173 190
risultato è la totale distruzione di qualsiasi batterio testato entro pochissimi tempo e, sottolineo, che ciò avviene in assenza totale di sostanze velenose, tipo antibiotici o anti vegetativi, Il meccanismo non discrimina dalla forma o tipologia del microrganismo
Come dicevamo all'inizio, Airlite nasce come strumento di facile utilizzo per mitigare l'inquinamento dell'aria Oltre ad aver effettuato i relativi test secondo le normative in corso, per determinarne l'efficacia, sono stati effettuati molti pilot su casi reali di cui vi descriviamo i due principali
Nel 2007 abbiamo riqualificato il Tunnel Umberto I° a Roma, applicando il prodotto alle pareti della galleria e rifacendo l'impianto di illuminazione.

Contestualmente sono state realizzate due campagne di monitoraggio ambientale all'interno del tunnel per la durata di tre settimane ciasciuna Una prima di effettuare i lavori, che si sono svolti nel mese di agosto, nel mese di luglio, mentre la seconda nel mese di ottobre Complessivamente abbiamo acquisito circa 500 000 letture di dato

I risultati avuti sono un abbattimento dei livelli di inquinamento al centro della galleria pari al 51%, l'eliminazione dei cattivi odori all'interno con la possibilità di utilizzare il tunnel dai pedoni Per ultimo, le pareti sono rimaste bianche per oltre 10 anni, quando con una pittura standar diventano nere in circa un anno
Nel 2009, in una scuola a Londra, sono state dipinte due aule Una con una pittura tradizionale e una con Airlite Successivamente sono stati installate dei rilevatori al loro interno e i risultati sono stati i seguenti: Nell'aula dipinta con Airlite la concentrazione di NO2 è risultata del 96,4% in meno rispetta all'altra aula, come sono diminuiti i livelli di VOC ( 98,8%), batteri ( 99,99%) e la produzione di rifiuti speciali ( 100%).
Nell'ultimo anno si è dibattuto molto sul ruolo che potrebbe avere l'inquinamento atmosferico nell'accelerare la diffusione del Sars Cov2 Se possa p meno fungere da carrier, cioè da vettore, consentendo al virus di percorrere distanze maggiori Sicuramente le persone che vivono in un ' area con alti livelli di inquinanti sono più inclini a sviluppare problemi respira tori cronici e adatti a recepire qualsiasi agente infettivo.
Inoltre, un 'esposizione prolungata all'in quinamento atmosferico secondo il loro lavoro porta a uno stimolo infiammatorio cronico, anche in soggetti giovani e sani.
In pratica Airlite è un contenitore di tecnologie che possiamo riassumere con queste affermazioni:
• Elimina il Sars Cov2

• Elimina i virus
• Elimina i batteri
• Elimina le muffe
• Purifica l'aria
• Elimina i cattivi odori
• Ha un'impronta di carbonio pari ad un terzo rispetto alle pitture tradizionali
• È ignifugo
• Ha un alte potere riflettente
• Non contiene VOC
• Non contiene antivegetativi
• Contiene un 38% di prodotto riciclato
• È un prodotto minerale
• Per la sua produzione viene utilizzata energia prodotta al 100% da fonti rinnovabili
Abbiamo fortemente voluto dotare Airlite di certificazioni ambientali volontarie, molto importanti, come Cradle to Cradle Gold, Friendly Material Gold e Green Seal americana
Inoltre Airlite contribuisce al raggiungimento degli obiettivi dell'agenda ONU per lo Sviluppo Sostenibile nei punti 3, 8, 9, 11, 12 e 13.
Il prodotto si può applicare ovunque sia necessario dipingere una parete, quindi uffici, scuole, case private, fabbriche, ospedali, caserme, industrie alimentari, hotel, ecc
Dipingendo una casa con Airlite si ottiene lo stesso risultato, relativamente all'abbattimento degli inquinanti, dell'aver aver creato un bosco della stessa superficie Ad esempio, dipingere 100 mq vuol dire creare un bosco di 100 mq

L'anno scorso abbiamo messo a punto un sistema per la purificazione e sterilizzazione dell'aria, all'interno delle UTA (Unità di Trat tamento Aria), luogo estremamente delicato e dove è possibile la diffusione di agenti patogeni all'interno delle canalizzazioni, fino alla fuoriuscita dalle bocchette di aereazione L’installazione all’interno delle UTA (unità di trattamento aria) di luci UV che, in abbinamento con la tecnologia Airlite, permettono di ottenere un nuovo tipo di filtro con altissimi livelli di sterilizzazione dell’aria, arrivando a effi cienze germicida che raggiungono il 99,9%.
Anche questa tecnologia è indicata per moltissime destinazioni, quali ad esempio, palazzi, ospedali, industria, treni, navi allevamenti, aeroporti, ecc.
Abbiamo vinto il contest a New York quale miglior prodotto mondiale per combattere l'inquinamento dell'aria e l'effetto isola di calore
2021; 171(2): 173 190
Le Nazioni Unite ci hanno indicato fra le migliori quattro tecnologie al mondo per migliorare la qualità dell'aria KPMG ci ha inserito nelle innovazioni del settore Real Estate 2019 Abbiamo vinto il primo premio nella seconda edizione dell'Asia Exhibition of Inventions ad Hong Kong nel 2019 Il prodotto è stato definito come una disruptive technology, e uno straordinario strumento di prevenzione.
Tutte le caratteristiche del prodotto sono state testate e verificate da moltissimi centri di ricerca nel mondo e stiamo collaborando con le migliori università italiane
Sono incancellabili le sensazioni che, appena un anno e mezzo fa, all’accenno del primo focolaio di infezioni di COVID 19 a Codogno (LO) in Lombardia, sancivano di fatto l’apertura di un ’ emergenza pandemica dai risvolti epocali1 e ancora attuale In quei giorni, mentre l’Istituto Superiore della Sanità (ISS) metteva a punto un rapporto sulle «Raccomandazioni ad interim sulla sanificazione di strutture non sanitarie nell’attuale emergenza COVID 19: superfici, ambienti interni e abbigliamento » s’imponevano scelte determi nanti per mettere in sicurezza gli ambienti lavorativi della Difesa.2
In un momento congiunturale particolare, caratterizzato dalla carenza quali quantitativa di Dispositivi di protezione individuale (DPI) e disinfettanti / igienizzanti, le scelte operate si sono rivelate allo stesso tempo intuitive e calibrate, capaci di individuare giuste opportunità offerte dall’industria di settore, in totale armonia con le indicazioni fornite dalle raccomandazioni dell’ISS.
L’Ispettorato Generale, in ragione della sua responsabilità strategica a latere del Capo di Stato Maggiore della Difesa e nelle more attuative del Decreto «Cura Italia» per ottenere le prime munizioni finanziarie per uno sforzo maggiormente coordinato ed efficente, ha agito tempestivamente, senza perdere di vista i presupposti datoriali necessari a mettere in sicurezza il personale della Difesa indi pendentemente dalla propria area d’impiego, garantendo efficacia e sicurezza
La Scelta del prodotto BIOAKT, DM di Classe IIb3, validato per la sua attività virucida dal Dipartimento Scientifico del Policlinico Mili tare del Celio, è stata tutt’altro che casuale Il prodotto della NEWTECH SOLUTIONS, che fa dell’efficacia, della biocompatibilità e della sicurezza il suo punto di forza, si è rivelato senza conseguenze negative tanto in termini di impatto ambientale quanto in quelli di anti biotico resistenza (AMR)
L’utilizzo del Dispositivo Medico a base di ioni argento in acido citrico ha permesso poi di compiere un ulteriore passo innovativo, integrato in un sistema (GATEAKT) costituito da un tunnel e un ’unità di controllo, progettato per sanificare utenti che accedono a spazi commerciali, pubblici e luoghi di lavoro Un risultato che, sviluppato da NEW TECH SCIENTIFIC (NEW TECH SOLUTION e TEKNE)4, evidenzia il frutto di ingegno e di una manodopera tutta italiana, La capacità di raccogliere al momento opportuno le soluzioni disponibili per la sanificazione di superfici e ambienti interni non sani tari per la prevenzione della diffusione dell’infezione COVID 19, considerandone tanto l’impatto ambientale quanto i potenziali rischi per la salute umana, ha permesso all’Ispettorato Generale della Sanità Militare di assolvere ai suoi compiti di sorveglianza sanitaria in modalità integrata con le soluzioni offerte dall’industria italiana, assolvendo agli scopi prefigurati e contribuendo a rinforzare l’im magine positiva offerta dall’intero Sistema Paese.
1 https://it wikipedia org/wiki/Pandemia di COVID 19 in Italia

2 https://www iss it/rapporti covid 19/ /asset publisher/btw1J82wtYzH/content/prossima pubblicazione rapporto iss covid 19 n 25 2020 raccomandazioni ad interim sulla sanificazione di strutture non sanitarie nell attuale emergenza covid 19 superfici ambienti interni e abbigliamento
3 https://it wikipedia org/wiki/Dispositivo medico
4 NEW TECH SCIENTIFIC | Sicurezza in ambienti a rischio contaminazione
G Med Mil 2021; 171(2): 173 190
Brig. Gen. C l a u d i o Z a n o t t o




S
P U N T I P U N T I D A L D A L G G I O R N A L E I O R N A L E D I D I M M E D I C I N A E D I C I N A M M I L I T A R E I L I T A R E C E N T O C E N T O A N N I A N N I F A F A ::
Relazione del prof Cesare Baduel, colonn med , direttore gener della C R I

I. Attività in zona di guerra.
Appena l'Italia entrò nel grande conflitto la C. R. I., forte della sua preparazione, mobi litò rapidamente le proprie Unità, che in breve tempo furono dislocate nella zona di guerra ed immediatamente utilizzate. Furono mobilitate 209 unità così suddivise: 65 ospedali da guerra attendati, 3 ospedali di tappa, 3 ospedali chirurgici mobili, 4 sezioni di sanità, 32 ambulanze da montagna, 29 posti di soccorso ferroviari, 24 treni ospedali, 15 sezioni auto mobili, 3 sezioni da campo per infermierie volontarie, 1 ambulanza lagunare, 1 ambulanza fluviale, 6 ambulanze radiologiche, 1 ambulanza elettro vibratore, 4 bagni doccia mobili. Furono impiantati 2 magazzini di rifornimento, 3 depositi di rifornimento, 3 depositi di personale, lavanderie, laboratori per ricerche mediche e 3 autoparchi. Per il servizio di dette unità la C. R I. mobilitò il personale seguente: ufficiali medici 1163, di amministra zione 427, farmacisti 165, automobilisti 273, cappellani 157, infermiere volontarie 1080 e 9500 uomini di truppa (graduati e militi).
Gli ospedali da guerra avevano una capacità iniziale di 50 letti, che fu portata rapidamente a 100 ed in qualche caso a 200, in modo che fu possibile allestire nella zona di guerra circa 10.000 letti. Molti di questi ospedali erano provvisti di laboratori bacteriologici, di gabinetti di radiologia, apparecchi di disinfezione, impianti di cure moderne, ecc. Questi ospe dali ricoverarono 426.786 malati e feriti con 3.658,772 giornate di degenza e prestarono 191.487 cure ambulatorie.
Gli ospedali chirurgici mobili erano formazioni di grande rendimento chirurgico, capaci di dare i più moderni soccorsi della chirurgia di guerra, ed ebbero una parte importantissima nell'assistenza ai feriti, giacchè essi potevano provvedere, in prossimità della zona di azione, ai casi gravi per ferite all'addome, cranio, torace ecc, per i quali lo sgombero in
(1) (1) Ho desiderato che in questo Giornale venisse pubblicata la relazione che la Croce R o s s a I t a l i a n a h a i n v i a t o a l C o n g r e s s o I n t e r n a z i o n a l e d i m e d i c i n a e f a r m a c i a m i l i t a r e d i Bruxelles per illustrare la propria opera sanitaria durante la guerra, quale ausiliaria della Sanità Militare. Questa relazione viene quanto mai opportuna per completare quel poco che io scrissi nel fascicolo precedente di questo periodico sulla relazione ufficiale “Organizzazione generale dei servizi sanitari militari e rapporti con la C. R. I.” per la parte spettante alla C. R. I. Mancandomi notizie precise e dati statistici, di cui è ricca la relazione del Direttore generale, il concorso dato dalla C. R. I. vi è prospettato in maniera insufficiente, mentre desideravo affermarne la larghezza, la importanza e la utilità.
La C. R. I. ha voluto, con un simpatico gesto di cameratismo, che il ten. col. med. prof. Filippo Caccia, delegato del Ministero della guerra al Congresso di Bruxelles, rappresentasse anche la C. R. I. e presentasse questa relazione.
Prof. STEFANO SANTUCCI, brig. generale medico.
ospedali più distanti dalla linea del fuoco avrebbero portato un gravissimo danno. Essi costi tuirono dei propri Posti chirurgici avanzati. L'intero ospedale era trasportato su 6 camions. Senza tener conto delle operazioni di minore importanza, come amputazioni, disarticolazioni, resezioni, allacciature di grossi vasi, ecc., eseguite in gran numero, le statistiche regi strano 694 laparatomie, 612 cranioctomie, 45 laminectomie e 60 toracotomie. Ospitalizzarono 6125 infermi, con 44.715 giornate di degenza e 3849 prestazioni chirurgiche ambulatorie.
Le Sezioni di sanità avevano la stessa costituzione di quelle della Sanità militare ed ospi tarono 16.049 infermi con 12.659 giornate di degenza, 225.691 cure ambulatorie e trasportarono 65.523 infermi.
Le Ambulanze da montagna resero grandi servizi, e riuscirono a compiere le più svariate mansioni, funzionando da piccoli ospedali chirurgici avanzati, da infermerie, da ospedali di isolamento, istituti di riposo, ambulatori, ecc. Più tardi, atteso che il carattere della guerra era piuttosto di posizione che di movimento, un gran numero di esse fu trasformato in Sezioni automobili, che, sia impiegate isolatamente, sia aggregate alle sezioni di sanità, facilitarono opportunamente il problema della evacuazione dei feriti dalla prima linea. Vi furono addette 220 ambulanze. Esse ospitalizzarono 45.533 militari con 210.988 giornate di degenza, e 484.816 visite ambulatorie, e furono trasportati 500.308 militari.
I posti di soccorso nelle stazioni ferroviarie, 29 in zona di guerra e 51 nella zona terri toriale, furono i primi ad entrare in azione provvedendo alle necessità dell'affollamento ed all'intenso traffico ferroviario per il concentramento delle truppe. Oltre al carico e scarico dei malati e feriti sui treni ospedali, provvidero al servizio sanitario delle truppe accantonate nelle vicinanze, costituirono ricoveri notturni per i soldati di transito, fecero funzionare i posti di visita e disinfezione per la sorveglianza sanitaria degli operai civili di passaggio, ecc. Le prestazioni sommano a 761.725 per la zona di guerra e 560.912 per quella territoriale, dove 40 posti di ristoro coadiuvarono e, completarono l'opera dei posti di soccorso.
I treni ospedali, mobilitati in numero di 24, diedero alla guerra un rendimento di grande importanza. Allestiti con gran cura durante il periodo di pace, controllati da esperimenti, erano capaci di trasportare in un primo tempo 206 feriti coricati, ed in seguito 300. Il rendi mento di queste nostre Unità fu cosi soddisfacente che la Sanità militare modificava i propri treni attrezzati rimodernandoli sul tipo di quelli della C. R. I. Nel 1918 fecero il servizio delle truppe italiane operanti in Francia e delle truppe inglesi impiegate sul nostro fronte. Specializzatisi in treni contumaciali provvidero al rimpatrio dei prigionieri tubercolosi ed allo sfollamento degli ospedali di primo concentramento dei medesimi. Trasportarono in Austria gli ex prigionieri invalidi ed in Polonia gli ex prigionieri austriaci di nazionalità polacca. L a l o r o a t t i v i t à s i r i a s s u m e n e l l e s e g u e n t i c i f r e : i n f e r m i t r a s p o r t a t i 8 3 5 . 5 0 1 , v i a g g i eseguiti 4572, chilometri percorsi 2.824.519.
Passo rapidamente sull'impiego delle sezioni automobili, delle sezioni da campo per infer miere volontarie, delle sezioni bagni doccie mobili, dell'ambulanza lagunare, dell'ambulanza fluviale «Litta», delle ambulanze radiologiche e dell'ambulanza elettro-vibratore e delle altre formazioni, come magazzini, lavanderie, laboratori, che integrarono la nostra organiz zazione sanitaria nella zona di guerra.
I servizi automobilistici, fino dal principio della guerra assunsero una grandissima impor tanza. Per assicurare un buon servizio sanitario di sgombero la C. R. I. aprì arruolamenti per la durata di due anni fra i proprietari di automobili ed i loro meccanici, costituendo cosi un corpo di 273 ufficiali automobilisti, di cui solamente 111 avevano obblighi militari. Tale servizio diede ottima prova tanto per la qualità degli uomini, come per la bontà del
G Med Mil 2021; 171(2): 191 198
1 9 3 1 9 3

materiale e per la organizzazione dei servizi. In ciascuna delle Armate venne costituito un autoparco della C. R. I.

Il rendimento delle nostre Infermiere volontarie fu superiore ad ogni elogio. Esse presta rono servizio negli ospedali da guerra, nei treni, negli ospedali chirurgici mobili, nei posti di soccorso avanzati, dovunque la C. R. I. alzò le sue insegne, sia nella zona di guerra, che in quella territoriale, in numero di 10.000 circa, di cui 1080 nelle formazioni sanitarie del fronte. Il corpo delle Infermiere volontarie in Italia aveva già una solida preparazione prima della guerra, ma all'approssimarsi di essa furono organizzati numerosi corsi accelerati presso le 180 scuole che già erano in funzione. Nell'aprile 1915 veniva istituito presso il Comitato centrale della C. R. I. l'Ispettorato generale delle Infermiere volontarie, a cui S. M. la Regina prepose S. A. R. Elena di Francia, Duchessa D'Aosta, L'Augusta principessa coordinò programmi ed attività ed assicurò la più rigida osservanza alla disciplina; e quando il Rego lamento per il servizio Infermiere pose dei limiti e delle restrizioni alla loro assegnazione, giacche disponeva che soltanto negli ospedali di tappa, treni ospedali e negli ospedali terri toriali esse dovessero servire, S. A. R. volle che tutte le Infermiere prestassero l'opera loro dovunque fosse un ferito da curare, un malato da assistere fino sulla linea del fuoco. Ed è così che vediamo le nostre Infermiere nelle ambulanze chirurgiche, nei posti chirurgici avan zati, nei lazzaretti, nella galleria di Zagòra, nelle trincee di Devetaki, che raggiunsero di notte per strade battute dal fuoco nemico. Esse hanno assistito i feriti più gravi e dato prova di valore e di resistenza, affrontando con sereno esempio di fierezza d'animo, i disagi più terribili della guerra, i pericoli delle infezioni, cosi come più tardi la dura prigionia.
Croce Rossa e Sanità militare. Il servizio della C. R. I. fu sempre intimamente legato ed in perfetta comunione di intenti con quello della Sanità militare e partecipò in cosi larga proporzione a tutti i provvedimenti presi nel campo sanitario, che non era più possibile fare una distinzione di attribuzioni ed assegnare alla C. R. I. limiti di attività diversi da quelli della Sanità militare. Le restrizioni imposte in un primo tempo all'attività della C. R. I. caddero per volere del nostro personale e per la fiducia che aveva saputo conquistare. E la C. R I. passò ai servizi di prima linea. Numerose le prove di simpatia e di stima che le autorità militari diedero al nostro personale. Un nostro ufficiale superiore, clinico chirurgico di una Università, istituì e diresse l'Università da campo di S. Giorgio di Nogaro, ed ufficiali della C. R. I. furono adibiti come insegnanti nella Scuola: in detta Università gli studenti di medi cina sotto le armi trovarono modo di continuare i loro studi senza essere dispensati dal servizio militare. Un altro nostro ufficiale, pure professore di Università, creò un Museo anatomo-patologico, illustrante la traumatologia di guerra, che costituisce oggi la più preziosa raccolta di pezzi anatomici, a dimostrazione di peculiari lesioni occorse in guerra in relazione anche con i nuovi mezzi di offesa, e servirà come materiale di studio e di insegnamento nella R. Scuola di applicazione di Sanità militare, a cui la C. R. I. lo ha donato.
Personale dell'Associazione morto e ferito. Durante la guerra morirono per fatti d'arma, 13 ufficiali medici, 2 ufficiali di amministrazione e 30 militi: per malattie contratte in servizio 51 ufficiali medici, 10 ufficiali farmacisti, 23 ufficiali di amministrazione, 2 cappellani, 43 infermiere volontarie e 254 militi. Furono feriti 21 ufficiali medici, 5 uffi ciali di amministrazione, 1 cappellano, 2 infermiere volontarie e 118 militi. Furono fatti prigionieri 21 ufficiali medici, 1 ufficiale farmacista, 1 ufficiale di amministrazione, 3 infermiere volontarie ed 11 militi. Dispersi: 3 ufficiali medici, 1 cappellano e 16 militi.
2021; 171(2): 191 198
Ricompense. S. M. il Re ha conferito alla C. R. I. la Medaglia d'argento al valore militare con la seguente motivazione: “Nell'adempimento della sua nobilissima e pietosa missione dimo s t r ò i n t u t t a l a g u e r r a m i r a b i l e s p i r i t o d i a b n e g a z i o n e , g e n e r o s o a r d o r e , s e r e n o v a l o r e , costante devozione al dovere. 1915 1918. ”
Furono citati all'ordine del giorno 29 nostre formazioni sanitarie. Furono individualmente conferite: medaglia d'argento al valore ad 11 ufficiali, 2 infermiere volontarie e 2 militi; medaglia di bronzo al valore a 37 ufficiali, 53 infermiere volontarie e 2 militi; croci al merito di guerra a 205 ufficiali, 235 infermiere volontarie e 354 militi; a 6 infermiere volon tarie fu conferita la medaglia Nightingale.
II. Attività in zona territoriale.
Nella zona territoriale furono impiantati 204 ospedali in posizioni salubri, soleggiate, aereate, trasformando collegi, conventi, scuole e ville, e dotandoli di tutte le provvidenze che la moderna igiene e le necessità della medicina e della chirurgia di guerra richiedevano. Questi ospedali avevano una capacità variabile da 50 a 700 ed anche 1000 letti. Alcuni erano destinati a ricevere malati di medicina, altri assunsero un tipo puramente chirurgico, altri si specializzarono, altri infine subirono durante la lunga guerra le più variate trasforma zioni. Essi misero a disposizione dell'Esercito 30.000 posti letti; ricoverarono 696.993 mili tari con 17.018.782 giornate di degenza. Per questo servizio in zona territoriale furono mobi litati 1160 ufficiali medici, 163 ufficiali farmacisti, 480 ufficiali di amministrazione, 130 ufficiali automobilisti, 90 cappellani, 7320 infermiere volontarie, 5750 militi, e 4122 di personale borghese aggregato.
Nella Reggia del Quirinale S. M. la Regina Elena impiantò un ospedale, dove per tutta la durata della guerra, provvide con regale generosità e con materno affetto, all'assistenza dei nostri valorosi feriti prima, ed in seguito dei nostri mutilati. Per Sua iniziativa e sotto la Sua direzione furono eseguiti i necessari impianti per la fornitura degli apparecchi di protesi e di fisioterapia, allestiti laboratori di calzoleria ortopedica, dove attesero i muti lati stessi, scuole di calligrafia, dattilografia, disegno e plastica e di orientamento per lavori artistico industriali. Sua Maestà la Regina dedicò le Sue cure personali a questo ospe dale dove, durante tutta la guerra, passava gran parte della Sua giornata, interessandosi di tutto e di tutti. In esso furono ricoverati 4999 militari con 213.085 giornate di degenza.
Con eguale sentimento di pietà S. M. la Regina Madre nel proprio palazzo personalmente allestì e diresse un ospedale chirurgico per ufficiali e soldati che ebbe scuole, laboratori, dove i ricoverati potevano riprendere i loro lavori abituali od apprendere un nuovo mestiere. Vi furono ricoverati 2.917 militari con 107.459 giornate di degenza; si eseguirono 440 opera zioni chirurgiche della massima importanza. L'Augusta
Donna provvide a tutte le agiatezze ed a tutti i conforti ispirati dal Suo grande cuore di Madre e dalla Sua grande signorilità di Sovrana.
7 ospedali furono allestiti come case di cure e di rieducazione per i mutilati e gli storpi. Presso l'ospedale territoriale di Chiari venne istituita una sezione di cura Vanghetti. E' noto come questo illustre italiano, nostro ufficiale, modesto medico di una piccola città, ignoto ai profani e non abbastanza noto nel campo medico, spetti l'onore di avere adottato un metodo per la vitalizzazione delle membra artificiali che trovò, durante la guerra, in Italia ed all'Estero, la più opportuna applicazione, dopo che le principali tra le Nazioni alleate invia rono in Italia missioni per lo studio pratico di questo metodo che ha dato dei risultati vera
G Med Mil 2021; 171(2): 191 198
1 9 5 1 9 5

mente meravigliosi. Fu provveduto altresì al ricovero dei grandi invalidi ed a Firenze è ancora in funzione un ospedale a loro destinato.
Altri ospedali territoriali furono destinati al ricovero e alla cura dei tubercolosi. Il compianto Presidente della C. R. I. Conte G. G. della Somaglia inaugurava l'8 ottobre 1916 il primo sanatorio per militari tubercolosi impiantato in Italia. Nel 1918 le unità sanitarie della C.R.I. destinate ai tubercolosi erano in numero di 12 con una totale efficienza di 450 l e t t i e d o v e d u r a n t e l a g u e r r a f u r o n o r i c o v e r a t i 1 5 . 8 9 3 i n f e r m i c o n 2 8 4 . 1 7 8 g i o r n a t e d i degenza. Questa organizzazione fu validamente aiutata dalla Direzione generale della Sanità pubblica che concesse alla C. R. I. centri baraccati di ottimo rendimento. Questi Istituti presentemente sono ridotti a 4 con 520 letti.
Furono impiantati altresì ospedali specializzati per le malattie infettive, sezioni per il trattamento chirurgico delle lesioni nervose e per l’elettroterapia consecutiva, sezioni di elioterapia, una sezione per malattie mentali e nelle Puglie fu organizzato un grande centro di isolamento per i militari provenienti dall'Oriente con 960 posti-letto.
Sei ospedali furono destinati a convalescenziari per ufficiali malati e feriti e 16 per soldati. Un ospedale di Bologna fu messo a disposizione delle truppe czeco slovacche ed a Como un ospedale fu adibito per il concentramento dei prigionieri di guerra anche a scopo contu maciale.
A n c h e i n z o n a t e r r i t o r i a l e o r g a n i z z ò s e r v i z i a u t o m o b i l i s t i c i i m p i a n t a n d o u n a u t o p a r c o centrale a Roma, tuttora in funzione, e gli autoparchi di 12 Comitati, sedi di importanti centri ospitalieri. In detti centri fu provvisto col concorso di automobili privati e con i mezzi a disposizione delle Società di soccorso di assistenza locali, e con opportune trasformazioni delle vetture tramviarie, al trasporto dei malati e feriti dalle stazioni ferroviarie agli ospedali, non soltanto di Croce Rossa, ma altresì militari e civili.
Durante l'epidemia influenzale che funesto l'Italia nel 1918, la C. R. I., per quanto impe gnata nel soccorso di guerra, fu richiesta dalle autorità sanitarie in concorso ai servizi di profilassi e di cura di una grandissima quantità di ammalati. A tale servizio, nelle regioni più colpite, furono destinati 381 ufficiali medici, 10 farmacisti, 860 infermiere volontarie e 547 militi.
III. Riassunto dell'opera della C. R. I. durante la guerra.
Le prestazioni della C. R. I. durante la guerra sia in zona di operazione che nel territorio possono essere cosi riassunte:
Malati e feriti ospitalizzati N. 1.205.754 Giornate di degenza “ 21.262.301 Cure ambulatorie “ 1.975.477 Malati trasportati “ 4.365.000 Essa chiamò in servizio:

Ufficiali medici N. 2.539 “ farmacisti “ 318 “ di amministrazione “ 630 Cappellani “ 349 Infermiere Volontarie “ 10.000 Sottufficiali e Militi “ 14.650 Personale borghese aggregato “ 4.122
2021; 171(2): 191 198
Finanziamento. Come la C. R. I. ha potuto sostenere le ingenti spese di guerra? Le spese complessive della propria organizzazione sanitaria, e che già sono state esattamente calcolate, ammontano a lire 232.434.985,12. Esse fanno carico, per grandissima parte, all'amministrazione militare per rimborso delle diarie di degenza dei militari ricoverati, per gli stipendi al personale chiamato in servizio nonchè per altri capitoli di credito di minore entità. Ma il contributo che la C. R. I. ha dato ascende nondimeno alla cospicua cifra di lire 51.000.000. Attività fuori del territorio nazionale. La C. R. I. partecipò al servizio delle truppe operanti in Albania e Macedonia con 4 ospedali di guerra, con 1 treno ospedale e con il perso nale direttivo di una sezione di sanità. Nostri treni ospedali fecero il servizio delle truppe inglesi e francesi per ricondurre in Patria i loro feriti e malati. Altri rimpatriarono i prigionieri austriaci invalidi di guerra in Austria, ed i prigionieri austriaci di nazionalità polacca in Polonia. Un nostro treno ospedale seguì le truppe italiane operanti in Francia. Inviò altresì soccorsi in Polonia, a Costantinopoli, ed in Georgia

La C. R I. infine nel settembre 1919 ebbe dal Governo italiano l'incarico del vettovaglia mento della popolazione civile della città di Fiume, che organizzò e compì per un importo c o m p l e s s i v o d i v e t t o v a g l i e d i l i r e 1 2 . 1 7 4 . 2 0 0 , 2 8 , e l a r g e n d o , p e r p r o p r i o c o n t o l a t t e i n polvere, medicinali, materiale sanitario, generi di conforto, indumenti, ecc.
Durante i recenti conflitti nei dintorni di quella città inviò un ospedale da 100 letti, con materiale e personale proprio.
Assistenza ai congedati malarici (1919 20). Le vicende della guerra che determinarono l'abbandono delle opere di bonifica nella regione dell'Isonzo, la rottura degli argini del Piave e le spedizioni in Albania e Macedonia, diedero alle truppe italiane operanti un notevole contingente di malarici che rientrò in paese dopo la smobilitazione. Nel novembre 1919 il Governo, giustamente preoccupato della nuova minaccia al benessere nazionale, si rivolse alla C. R. I. per organizzare la cura dei congedati malarici ed essa in accordo con la Direzione generale della Sanita pubblica e della Sanità militare e con l'Associazione dei combattenti, stabilì, nella primavera 1920, tutto un piano di lotta antimalarica per l'assistenza degli smobilitati malarici. Furono censiti e curati 87.848 malarici con questi risultati: circa il 36% può essere considerato guarito, il 50% notevolmente migliorato, il 14% presenta ancora delle recidive. Le forme gravi furono curate in sei Sanatori di alta montagna, egualmente alle stiti dalla C. R. I, per potere associare al trattamento specifico, i fattori climatici che nella malaria hanno una indiscussa importanza terapeutica.
Rapporti della C. R. I. con le autorità militari in tempo di guerra ed in tempo di pace. Per disposizione del proprio Statuto, la C. R. I. dipende dal Ministero della Guerra e della Marina, i cui rappresentanti sono in diritto membri del Comitato centrale e del Consiglio direttivo. I decreti Reali del 14 dicembre 1919, n. 2469 e 2470, stabiliscono oggi le attri buzioni che la C. R. I. ha in tempo di pace e in tempo di guerra, e i suoi rapporti col Ministero della guerra, e le dipendenze gerarchiche ed amministrative con le autorità sanitarie militari in zona di guerra e territoriale. Così pure è sancita la posizione giuridica del nostro perso nale in caso di mobilitazione per ordine dell'autorità militare. Il Ministero della guerra ha il diritto di controllare le promozioni del nostro Corpo di ufficiali: gli ufficiali ed i militi chiamati in servizio in tempo di pace sono sottoposti alle disposizioni disciplinari sanzionate per i militari del R Esercito e della R. Marina. Essi sono considerati militari ed i loro gradi riconosciuti.
Per il decreto del 17 ottobre 1920, sulla proposta del Ministro della guerra, S. M. il Re ha concesso alla C. R. I. un “Labaro” come agli altri Corpi dell'Esercito.
1 9 7 1 9 7 G Med Mil 2021; 171(2): 191 198

«Sarà forte quell’Esercito che avrà più largamente e con maggiore costanza adottato i criteri psicologici di selezione.»

Nell’ambito della Psicologia militare1, la selezione psicoattitudinale del personale può essere definita come il complesso i n s i e m e d e l l e a t t iv i t à p s i c o l o g i c h e vo l te a d a c c e r t a re i l p o s s e s s o , n e i soggetti da selezionare, di determinati requisiti attitudinali e di persona lità, al fine di identificare coloro che sono idonei a svolgere lo specifico incarico a cui sono avviati, con soddisfazione sia propria che della Forza Armata (Giusti, Pizzo, 2003)
L’ottimizzazione del processo selettivo è un tema di grande attualità ed importanza nell’ambito dell’Esercito Italiano poiché è in questa fase che si pongono le fondamenta per la costruzione della futura struttura della Forza Armata
Ad oggi, in ambito Stato Maggiore dell’Esercito, l’Ufficio di Psicologia e Psichiatria Militare si occupa di organizzare, gestire e controllare la selezione psico attitudinale in Forza Armata, attraverso una sezione specifica denominata “Selezione del personale”2.
Edoardo Gemelli (Fig. 1) nasce da una famiglia di commercianti, a Milano il 18 gennaio 1878. Benché battezzato, per volere dei genitori, non riceve un ’edu cazione alla religione cattolica.
Padre Agostino Gemelli, 1925 Fig. 1 Padre Agostino Gemelli

* Ten. sa. (psi) Uf. Ad. 2^ Sz. Psicologia Clinica e dei Processi Organizzativi, Addestrativi e Formativi Ufficio di Psicologia e Psichiatria Militare Stato Maggiore dell’Esercito, Roma Corrispondenza: Via XX Settembre, 123/A 00187 ROMA (RM) tel 103 6507 civ 06 47356507 email: vincenza iodice@esercito difesa it


Una volta conclusa la scuola elementare, Edoardo è iscritto al collegio militare Longoni, dove frequenta prima il ginnasio e poi il liceo classico Conseguito il diploma di maturità, nel 1896 s’iscrive alla Facoltà di Medicina presso l’Università di Pavia
Il 9 luglio 1902 presenta e discute una tesi di laurea sull’anatomia e l’embriologia dell’ipofisi Relatore è il professor Camillo Golgi3 , futuro premio Nobel per la medicina nel 1906 Il dottor Edoardo Gemelli ha ora 24 anni e deve ancora assolvere agli obblighi di leva militare
Rinunciando al grado militare di sottotenente e accontentandosi del grado di soldato semplice, Gemelli evita la Scuola di Sanità Militare a Firenze, per prestare servizio come volontario all’Ospedale Militare di Milano, che ha sede presso l’antico monastero bene dettino di Sant’Ambrogio
Il reparto infettivi di tale ospedale diviene lo scenario della sua conversione religiosa Profondamente turbato dall’agonia di un soldato di cavalleria semianalfabeta, colpito da tubercolosi, allo stadio terminale e ricoperto da piaghe, il giovane medico concede il bacio para filiale che questi gli chiede poco prima di morire. Dopo di che trascorre mesi dell’inverno 1902 in una profonda crisi inte riore.
Nella primavera del 1903 Gemelli si riaccosta ai sacramenti e il 17 luglio 1903 Gemelli indossa la veste di terziario francescano. Il congedo militare arriva il 15 novembre e la sera stessa si presenta da padre Antomelli, sua guida spirituale e ministro provinciale dell’Ordine, per concordare con lui il da farsi.

Il noviziato di Agostino, nome imposto da padre Antomelli in considerazione del suo cammino di conversione, prosegue. Nel 1908 è ordinato sacerdote dal cardinale Andrea Carlo Ferrari a Milano.
La scelta dei voti gli impedisce di esercitare come medico ma gli è concesso di approfondire le discipline teologiche e filosofiche Tra queste, all’epoca, figura anche la Psicologia
Mentre intensifica i suoi studi, Gemelli inizia ad abbozzare quello che sarà il grande progetto della la sua vita: un ’università per i cattolici italiani, in cui scienza e fede non siano in contrasto tra loro, bensì possano integrarsi per la formazione dei giovani
Con l’approvazione dei suoi superiori affronta l’esame e ottiene la libera docenza in Istologia prima e in Psicologia dopo Consegue anche un ’ulteriore laurea in Filosofia
La dura esperienza della Prima Guerra Mondiale segna profondamente un padre Gemelli pur già abituato, dal collegio Longoni e dalla vita in convento, a uno stile di vita improntato a rigide regole militaresche (Fig 2) Mosso dall’umana pietà e dall’interesse scien tifico che da sempre lo accompagna, decide di studiare i combattenti Con il consenso del Generale Luigi Cadorna impianta, pioneri stico in Italia, un laboratorio di Psicofisiologia applicata In particolare si occupa dei soldati colpiti da choc emotivo e degli aviatori Addetto, come Ufficiale medico, al comando supremo dell’Esercito Italiano, si adopera per applicare la Psicologia e i suoi metodi in varie direzioni Studia i casi di amnesia dovuti a shell shock, il trauma da bombardamento o psicosi traumatica, giungendo alla conclusione che la causa di tale fenomenologia morbosa non è da imputare a lesioni organiche del sistema nervoso, bensì a condizioni pregresse di fragilità nervosa, che il trauma psichico porta in superficie Applica la selezione attitudinale a vari campi e sostiene con forza davanti ad alti gradi dell’Esercito la necessità di selezione di tutti i militari Questo al fine di arrivare ad arruolare dei veri specialisti per le diverse operazioni belliche
Il 7 dicembre 1921 l’Università Cattolica del Sacro Cuore viene ufficialmente inaugurata. Gemelli è rettore per diritto di fonda zione, ma desidera una carriera accademica regolamentare. Per questo, il 3 ottobre 1925 partecipa al concorso per la cattedra in Psicologia. La commissione concorsuale lo proclama vincitore della cattedra e rimarca i suoi meriti scientifici(4).

Dal punto di vista scientifico, lo psicologo Agostino Gemelli prosegue gli studi sull’aviazione già iniziati durante il primo conflitto mondiale Fedele al metodo scientifico, oltre che sui piloti professionisti, studia gli effetti del volo anche su sè stesso Si appassiona a tal punto che nel 1939 consegue il brevetto di pilota aereo di primo grado, a 61 anni compiuti

Nell’ultimo decennio della sua vita Agostino Gemelli vive la brutalità del secondo conflitto mondiale, al termine del quale, come tutti i rettori universitari nominati dal fascismo, viene destituito dal suo incarico Il 18 gennaio 1953, però, con un decreto del Presi dente della Repubblica, Agostino Gemelli viene confermato Magnifico Rettore a vita dell’università da lui fondata Il 15 luglio del 1959, dopo settimane di sofferenza, padre Agostino Gemelli si spegne in un letto dell’Ospedale di San Giuseppe di Milano È sepolto nella cripta della cappella del Sacro Cuore in Università Cattolica
Padre Agostino Gemelli e la selezione psicoattitudinale del personale militare
Per comprendere e migliorare sempre più il processo di selezione del personale nell’Esercito Italiano è utile, tra i diversi approfondimenti scientifici, analizzare le principali tappe storiche e l’influenza che lo sviluppo della Psicologia scientifica ha rivestito nella definizione del settore.
In Italia, così come negli altri Paesi occidentali, la Psicologia Militare ebbe un fulgido sviluppo a partire dall’inizio del secolo scorso, in particolare fra la I e la II guerra mondiale, grazie alle ricerche di Padre Agostino Gemelli, i cui studi pionieristici sulla sele zione dei piloti dell’Aviazione vengono comunemente riconosciuti come i precursori del suo successivo interesse per la selezione del personale militare. Infatti, lo stesso Gemelli afferma: “la psicologia militare ha una vita assai breve; il suo atto di nascita non risale al di là del 1915, ossia ai primi saggi di selezione dei piloti” (Gemelli, 1942, p.171).
L’impegno per la selezione dei militari muove a partire dalla definizione che Gemelli dà di “personalità del soldato”, intendendola come l’insieme di sentimenti, idee, tendenze, credenze e attitudini che, nonostante si sviluppi con gli anni e venga plasmata dall’edu cazione, non raggiunge mai la staticità ma muta, si trasforma e subisce per tutta la vita l’influenza dell’ambiente
Secondo Gemelli una selezione militare adeguata, che risponda a specifici criteri psicologici, deve studiare la personalità del soggetto, declinandola nei suoi diversi aspetti, e definire, parallelamente, le specifiche attitudini che un soldato deve possedere per lo svolgimento del servizio
A tal proposito, A Gemelli (1926) definisce la selezione dei militari un “problema nazionale” Infatti, all’epoca i criteri selettivi erano basati esclusivamente su quanto inserito nell’”Elenco delle imperfezioni e delle infermità che sono causa di inabilità assoluta e temporanea”(5) Secondo Gemelli, questo elenco analizzava in maniera minuziosa tutte le imperfezioni o le infermità fisiche giudi cate incompatibili col servizio militare, invece, per ciò che riguardava l’attività psichica, le categorie che definivano le infermità erano troppo ampie (gravi nevrosi, frenastenie e psicopatie) e non prendevano in considerazione i progressi scientifici compiuti in questo ambito di conoscenza
È nel corso di questa trattazione che Gemelli esprime la curiosità di approfondire, con metodi scientifici, lo studio dell’attività psichica, comprensiva del carattere e delle attitudini, che un soggetto deve avere per svolgere il suo servizio in tempo di pace e in tempo di guerra Conclude questo suo pensiero affermando: “La selezione delle reclute, intesa non solo nel senso di eliminare gli inadatti, ma intesa nel senso di guidare nella assegnazione dei vari compiti a seconda delle attitudini, deve rendere in tempo di pace il nostro eser cito sempre più preparato ad essere, nel giorno in cui la patria lo chiamerà all’opera, lo strumento prezioso della difesa nazionale; a questo i cittadini sono chiamati a dare tutto quello che possono secondo le proprie attitudini personali” (Gemelli, 1926, p. 167).
A partire da ciò, per Padre Gemelli la selezione deve:
• riconoscere in ogni individuo le specifiche attitudini e le loro potenzialità;
• suggerire quali sono i campi di applicazione più confacenti alle attitudini possedute, sottolineando così la fondamentale connessione tra processo selettivo e orientamento professionale;

• seguire l’individuo durante il processo di apprendimento al fine di potenziare l’esercizio attraverso cui possono svilupparsi le attitudini richieste.
Padre Gemelli sostiene che questi aspetti teorici avevano trovato già applicazione in campo militare, nel 1915, quando era stato coinvolto nella selezione dei piloti Inoltre, le ricerche compiute sui soldati italiani nella Grande Guerra lo condussero alla proposta, agli Alti Vertici di Forza Armata, di introdurre una selezione prima dei mitraglieri, che venne attuata tra il 1917 e il 1918, e poi dei mili tari di ogni arma Quest’ultima proposta, però, non trovò seguito nell’immediato benché la questione sollevata portò a una collabo razione tra Forza Armata e studiosi del settore (tra cui anche Gemelli)
A seguito di questa esperienza si costituì, infatti, una commissione mista, composta da Ufficiali Superiori dello Stato Maggiore dell’Esercito e psicologi, che aveva lo scopo di delineare un processo di selezione volto a: 1 considerare le esigenze, i bisogni e le circostanze in cui il soldato italiano era chiamato a svolgere il suo servizio; 2 fornire all’Esercito soldati adatti agli specifici compiti
Il lavoro di questa commissione, innanzitutto, fu quello di delineare il “profilo professionale” del militare, che esplicitasse le atti tudini richieste al soldato per l’esecuzione di specifiche attività legate ad un incarico ben preciso (Fig. 3) Successivamente, la commis sione si occupò anche del metodo attraverso cui valutare l’esistenza e il grado delle singole attitudini nei militari da esaminare Vennero scelti, pertanto, metodi semplici e costituiti da prove collettive, al fine di valutare nel più breve tempo possibile ampi gruppi di persone Vennero, inoltre, individuate delle prove individuali, somministrabili da personale che, pur possedendo un ’adeguata expertise, non aveva conseguito una specializzazione psicologica di grado elevato (6) (Gemelli, 1942).
Il processo selettivo si chiudeva, infine, con una valutazione comparativa delle attitudini di tutti i soldati esaminati. Contempora neamente all’esame attitudinale veniva eseguito anche l’esame caratteriologico.
Dal complesso risultato comparativo attitudinale si ricavavano gli elementi per fornire all’autorità militare degli elenchi, in cui il personale sottoposto a valutazione veniva così classificato:

• soldati a cui era possibile, da un punto di vista psicologico, affidare determinati compiti con sicurezza “di buona riuscita”;
• mediocri;

• inetti.
L’autorità militare aveva il potere, poi, di utilizzare questi giudizi a seconda delle proprie precipue esigenze Dall’esperienza maturata con questo lavoro, Gemelli trasse alcuni criteri generali utili per effettuare le selezioni attitudinali dei militari, che sono stati da lui sintetizzati, fra l’altro, nei seguenti punti:
1 nel pronunciare il giudizio sul singolo soggetto è necessario constatare l’esistenza di un ’attitudine e inserire tale constatazione in una visione più generale e globale della personalità;
2 sarebbe un errore nella selezione psicologica dei soldati ricercare uomini d’eccezione, in possesso dunque di tutte quelle attitu dini richieste dal profilo professionale Ciò che va fatto, invece, è valutare se le reclute o gli aspiranti militari posseggano le carat teristiche necessarie per svolgere adeguatamente i compiti che gli verranno affidati;
3 la psicologia ha il compito di selezionare gli uomini dal punto di vista psico attitudinale con una comprensione maggiore di quella comune Pertanto lo psicologo deve essere umano nel suo esame: deve avvalersi di strumenti scientifici di valutazione, le cui risul tanze però vanno associate alla capacità di intuito propria dello specialista, con l’obiettivo di ricostruire la personalità del soldato che esamina; 4 lo psicologo che opera in ambito militare deve tenere conto nella valutazione del soldato non solo delle aree carenti ma anche delle possibilità di compenso che il soggetto manifesta Per fare ciò è necessario prendere in considerazione l’età del militare, il suo passato e la sua professione
L’operosa attività di Agostino Gemelli presenta tutt’oggi caratteri di modernità. Le valutazioni, i pensieri e le opinioni espresse su come dovessero essere selezionati i soldati, benché all’avanguardia, vanno comunque inseriti nel contesto storico culturale dell’e poca.
Il merito più grande di questo studioso è stato sicuramente quello di aver posto solide basi allo sviluppo della psicologia militare in Italia e di aver lavorato sulla selezione psico attitudinale dei soldati focalizzandosi sul processo, con un ’ottica specialistica e scien tifica, che mantenesse un rigore metodologico unito ad aspetti di umanità e sensibilità.
I suoi studi in tale ambito hanno avuto importanti ripercussioni sulla psicologia del lavoro, trovando quindi applicazioni a contesti organizzativi diversi dall’Esercito ma che, allo stesso modo, hanno colto l’importanza e il valore che la risorsa umana riveste nello sviluppo e nel potenziamento dell’organizzazione stessa

Gemelli A (1916) L’anima dei nostri soldati In Vita e Pensiero 1916 4 (1)
Gemelli A. (1925). Sulla necessità di una selezione psicologica nel reclutamento dei militari. In Nuova Antologia 16 ottobre 1925.
Gemelli A. (1926). Un problema nazionale: la selezione dei militari. In Vita e Pensiero 1926 3.
Gemelli A (1942) La selezione del moderno soldato In Scientia 1942 XX Quarta serie Anno 36°
Giusti E , Pizzo M (2003) La selezione professionale Intervista e valutazione delle risorse umane con il Modello Pluralistico Integrato Sovera Editore: Roma
Lo Castro I., Fanelli G. (2015). Cit. in Introduzione alla psicologia nelle emergenze. Manuale per i soccorritori di Venturi M. E.. Liberodiscrivere edizioni: Genova.
Montanari I. (2017). AGOSTINO GEMELLI PSICOLOGO. Una ricostruzione storiografica. EDUCatt: Milano.
1 “Disciplina volta a comprendere, sviluppare e facilitare i processi organizzativi peculiari della realtà militare, allo scopo di potenziare l’efficacia e l’efficienza operativa delle Unità, mediante l'ottimizzazione del rapporto tra organizzazione ed individuo” (Lo Castro, Fanelli, 2015)
2 Il Capo Ufficio è Col sa (me) t ISSMI Fabio CIPPITELLI e il Capo della 1^ Sezione è il Magg sa (psi) Mariano PIZZO
3 Camillo Golgi (1843 1926)
4 Si veda al riguardo, la documentazione contenuta nel fascicolo personale n 1326, relativo alla posizione accademica del prof Edoardo detto Agostino Gemelli, conservato dalla Direzione delle risorse umane dell’Università Cattolica del Sacro Cuore Ufficio personale docente
5 R Decreto 15 gennaio 1923, n 24, con il quale si approvano gli elenchi A e B delle imperfezioni e delle infermità riguardanti l’attitudine fisica al servizio militare (Gazzetta Ufficiale, 25 gennaio 1923, n 20)
6 In Italia il primo corso di laurea in Psicologia è stato istituito a Roma e Padova nel 1971
Med Mil 2021; 171(2): 199 206






Il Giornale di Medicina Militare è indicizzato su piattaforma
